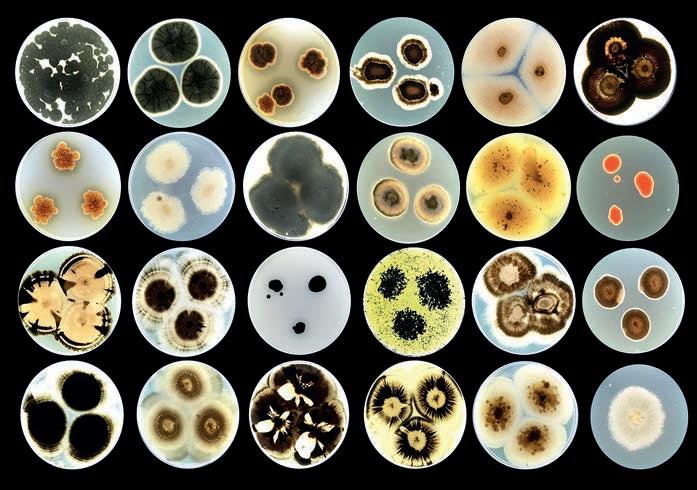

FAZITGESPRÄCH Hüter der Solidarität
FAZITGESPRÄCH Hüter der Solidarität
Grawe-Chef
Grawe-Chef
Klaus Scheitegel im Interview
Klaus Scheitegel im Interview
![]()

FAZITGESPRÄCH Hüter der Solidarität
FAZITGESPRÄCH Hüter der Solidarität
Grawe-Chef
Grawe-Chef
Klaus Scheitegel im Interview
Klaus Scheitegel im Interview
Juni 2025
FAZITESSAY
Christian Wabl mit einem ausführlichen Brief an den neuen Pontifex
Wirtschaft und mehr. Aus dem Süden.
FAZITTHEMA KRISE DER POLITIK


Von Christian Klepej

Oziel Inácio-Stech ist 43 Jahre alt, stammt aus Brasilien und lebt seit 2010 in Deutschland. Dort arbeitet er mittlerweile über neun Jahre an der Berliner Carl-Bolle-Grundschule als Lehrer. Und er ist schwul.
Vor wenigen Tagen nun ist in der Süddeutschen Zeitung eine Reportage erschienen, die – wieder einmal – ein alarmierendes Schlaglicht auf den Zustand unserer Gesellschaft wirft. Inácio-Stech soll über zwei Jahre hindurch in seiner Schule von Teilen der Schülerschaft wegen seiner sexuellen Orientierung gemobbt und drangsaliert worden sein. Derzeit ist er im Krankenstand, er leidet an einer posttraumatischen Belastungsstörung, hoffe aber, bald wieder an seinen Arbeitsplatz zurückkehren zu können. Er soll unter Anfeindungen und Beleidigungen in seinem Unterricht durch einige seiner Schüler gelitten haben, Schüler aus anderen Klassen sollen immer wieder seinen Unterricht gestört haben und auch am Schulhof wäre er solchen Schmähungen ausgesetzt gewesen. Inácio-Stech hat alle Vorfälle offenbar penibel dokumentiert,
Falsche Rücksicht hilft keinem Migranten. Bedroht aber unseren Frieden
* Migrantismus meint hier die Tatsache, dass man – aus falscher und unangebrachter Toleranz – Migranten gegenüber keine klaren und deutlichen Verhaltensregeln aufstellt. Und nicht, dass es nicht auch unter Migranten den einen oder anderen Tor geben darf.
daher wissen wir etwa von Formulierungen wie er sei »kein Mann«, eine »Familienschande« oder schlicht »ekelhaft«. Die Carl-Bolle-Schule hat rund 300 Schüler und von denen haben gute 95 Prozent Migrationshintergrund. Vorsichtig geschätzt werden das also 75 bis 80 Prozent Kinder mit muslimischer Religionsangehörigkeit sein. Und damit ist es recht wahrscheinlich, dass es – zumindest vor allem – muslimische Kinder waren, die diese sexistischen Angriffe auf den Lehrer zu verantworten haben. Worauf das vom Lehrer protokollierte »Du Schwuler geh weg von hier. Der Islam ist hier der Chef« hindeuten würde. Von Beginn an seiner Probleme mit den Schülern (einigen, selbstverständlich nicht allen), hat Stech jeden Vorfall der Schulleitung mitgeteilt. Dort erfuhr er aber offenbar, so ist der SZ-Reportage zu entnehmen, keinerlei Rückhalt. Ganz im Gegentum wurde er mit sich im Nachhinein als haltlos erwiesenen Anschuldigungen konfrontiert und es wurde ihm damit also auch von Seiten der dortigen Direktion recht übel mitgespielt. Interessant erscheint für mich zudem, dass in den natürlich umfangreichen Diskussionen im Netz über diesen Sachverhalt, durchaus dem Lehrer des Öfteren vorgeworfen wird, er hätte seine sexuelle Orientierung nicht »publik« machen sollen. Es wäre »unprofessionell« in der Beziehung Lehrer-Schüler so ein privates Thema zu besprechen. Was mich fassungslos macht, angesichts zahlreicher Pride-Monate und noch viel mehr Pride-Paraden, mit dem im Grunde einzigen Wesenskern, »stolz« auf sich und seine sexuelle Orientierung sein zu sollen. Weil es so sehr an die Verlogenheit diverser internationaler Konzerne erinnert, die ihre Logos in Europa und Amerika so gerne in Regenbogenfahnenart dekorieren, im Nahen Osten und anderen muslimischen Staaten darauf aber tunlichst verzichten. Ich verstehe dieses »Stolz-Sein« im Übrigen nicht wirklich, nie käme ich auf die Idee, auf meine Heterosexualität »stolz« zu sein. Ich bin recht zufrieden damit, ruhe da in mir. Aber ich brauch das niemandem bei einer Parade auf die Nase drücken. Mir geht sogar,
ich gestehe, jeder einzelne Regenbogenzebrastreifen und noch viel mehr jedes einzelne superbunte Erstebankappdesign sowas von auf die Nerven, aber ich kann Ihnen versichern, dass ich 1966 geborener, alter weißer Mann also, in ein Gymnasium und danach in eine Handelsakademie gegangen bin, in denen wir keinen Mitschüler ungestraft wen auch immer wegen seines »Schwulseins« beleidigen hätten lassen. So weit waren wir damals jedenfalls. Und, wenn wir schon dabei sind, in die Frühbar, damals in den Neunziger- und Nullerjahren, hab ich nur aufgehört zu gehen, weil ich dort zu viel konsumiert hab. Und nicht, weil der eine oder die andere Kellner*in einen Rock zu seiner bzw. ihrer Perücke getragen hat. So weit waren wir also schon.
Und jetzt dieser weitere Fall von traurigem Migrantismus*. Ich denke heute gar nicht an den FPÖ-Funktionär, der mit einer ähnlichen Entgleisung Schnappatmung bei Standard, ORF und Falter auslösen würde. Ich denke daran, dass Multikulti gescheitert ist. Dass wir endlich, siehe mein letztes Editorial, ganz klare Regeln aufstellen müssen. Und diese mit Konsequenzen behaftet sein müssen. Das hilft aus meiner Sicht auch den friedvollen und engagierten Migranten, die es natürlich in großer Zahl gibt. Das rettet vor allem aber unser friedliches Zusammenleben. Und unsere Kultur. n
Sie erreichen den Autor unter christian.klepej@wmedia.at

Fragmentierte Demokratie
Weil die Dreierkoalition sich nicht auf nachhaltige Reformen einigen kann, bleiben drängende Probleme ungelöst.

Hüter der Solidarität
In unsicheren Zeiten steigen Risiken, auch Veranlagungen werden komplexer. Ein Fazitgespräch mit Grawe-Chef Klaus Scheitegel.


»Dear Brother Leo!«
Nach Essays über das Christentum und den Glauben in den USA nun ein Brief nach Rom. An den neu gewählten Papst Leo XIV.
Wenn Mikroben Kunst machen
Eine Revolution in der Gestaltung und Erhaltung von Fassaden könnte das von der EU geförderte Projekt »Remedy« werden. Andreas Pankarter hat es sich angeschaut.
Seite 80

Rubriken
Editorial 5
Politicks 14
Investor 32
Außenansicht 38
Oberdengler 46
Immobilien 68
Alles Kultur 78
Schluss 82

Der Kalendermann
Neues-Land-Cefredakteur Karl Brodschneider prägt seit vier Jahrzehnten das publizistische Gesicht des Steirischen Bauernbundes.

Charly und die Eisfabrik 1997 expandierte Charly Temmel von Graz in die USA. Und auch dort hat der »Eiskönig« ordentliche Spuren hinterlassen.
Demokratien leben vom Konsens – doch was, wenn sich drei Regierungsparteien auf nichts Nachhaltiges einigen können? Im Fazitthema analysieren wir die lähmende Reformunfähigkeit der aktuellen Dreierkoalition.
Um Verantwortung geht es auch im Fazitgespräch mit Klaus Scheitegel: Der Generaldirektor der GRAWE spricht über die wachsenden Herausforderungen für Versicherungen in unsicheren Zeiten – von steigenden Risiken bis zur komplexeren Geldveranlagung.
Der Fazitessay ist diesmal ein Brief von Christian Wabl an den neuen Bischof von Rom, Papst Leo XIV. Für die Fazitbegegnung trafen wir Karl Brodschneider, der seit 40 Jahren das publizistische Gesicht des Bauernbunds prägt. Im Fazitporträt geht es um den steirischen Eispionier Charly Temmel, der vor 18 Jahren sein Glück in den USA suchte, um dort den Eismarkt zu erobern.
Für Riesenirritationen sorgte Songcontest-Gewinner »JJ«. Nach seinem Boykottaufruf gegen Israel steht der Musiker international unter Beschuss. Wir beleuchten den Vorfall und den Umgang mit Antisemitismus in der woken ESC-Szene. Gutes Lesen! -red-
IMPRESSUM
Herausgeber
Horst Futterer, Christian Klepej und Mag. Johannes Tandl
Medieninhaber & Verleger
Klepej & Tandl OG
Chefredaktion
Christian Klepej Mag. Johannes Tandl
Redaktion
Peter K. Wagner (BA), Mag. Josef Schiffer, Mag. Maryam Laura Moazedi, Dr. Volker Schögler, Mag. Johannes Pratl, Helmut Wagner, Mag. Katharina
Zimmermann, Mag. Michael Petrowitsch, Kim Vas (Satz und Produktion), Vanessa Fuchs (Organisation)
Lektorat AdLiteram
Druck
Walstead-Leykam
Vertrieb & Anzeigenleitung
Horst Futterer
Kundenberatung
Irene Weber-Mzell
Redaktionsanschrift
Titelfoto von Jorj Konstantinov
Schmiedgasse 38/II, A-8010 Graz T. 0316/671929*0. F.*33 office@wmedia.at fazitmagazin.at facebook.com/fazitmagazin

Weil keine Einigung auf nachhaltige Reformen gelingt, stecken die Regierungspolitiker den Kopf in den Sand und lassen drängende Probleme ungelöst.
Fazitthema
Von Johannes Roth
Die einst dominierenden Großparteien verlieren an Einfluss, neue Bewegungen, Protestparteien und Einzelakteure erstarken.
Das bedingt Regierungskonstellationen, die sich immer weiter vom Wähler entfernen und so den demokratischen Gedanken konterkarieren.
Am Tag nach der EU-Wahl 2024 herrschte in den Parteizentralen gespannte Ratlosigkeit. Nicht nur wegen der Ergebnisse: Die FPÖ auf Platz eins, SPÖ und ÖVP mit historischen Tiefstwerten. Vielmehr wurde offensichtlich, was Kommentatoren schon lange konstatierten: Die Wählerlandschaft ist zersplittert. »Es gibt keine Volksparteien mehr«, kommentierte Politologe Peter Filzmaier trocken in der zur Wahl ausgestrahlten ORF-Sondersendung. Mehr noch: Die Zeiten, in denen die Republik konsensual aus der Mitte heraus regiert werden konnte, schien vorbei zu sein, ein Mitte-Rechts-Bündnis zwischen rechten Parteien schien unausweichlich. Dass die Republik driftet – politisch, ideologisch und strukturell –, wurde in den folgenden Wahlen immer deutlicher. Auch bei den Nationalratswahlen änderte sich der Trend nicht. Die FPÖ vereinte 28,8 Prozent der Wählerstimmen auf sich, während sich die ÖVP mit 26,3 Prozent und die SPÖ mit 21,1 Prozent zufriedengeben mussten. Weit abgeschlagen im Wählerwillen: Die Grünen mit 8,2 Prozent und die NEOS mit 9,2 Prozent.
Herkulesaufgabe Status quo
Ergebnisse wie dieses sind natürlich weder Zufall noch gottgegeben. Sie sind ganz im Gegenteil Ausdruck eines tief wurzelnden Vertrauensverlustes der Bevölkerung in Politik, Parteien und das System. Der erklärt sich aus einer einfachen Tatsache: Den Bürgern geht es in Zeiten multipler Krisen nicht besser. Allein den Status quo zu halten, ist eine Herkulesaufgabe für jede Regierung, die selten zufriedenstellend gelingen kann. Der Vertrauensverlust in die »großen Zwei« (ÖVP, SPÖ) zieht sich dabei durch alle Altersgruppen. Laut einer Studie zur politischen Zufriedenheit vertrauen nur noch 27 Prozent der Befragten den traditionellen Parteien, ein Minus von 15 Prozentpunkten seit 2010. Andererseits scheinen Menschen wieder Vertrauen in das System generell zu gewinnen. Der Demokratiemonitor 2024 des Foresight-Institutes zeigt, dass 43 Prozent der Menschen denken, dass das politische System in Österreich gut funktioniert. Das ist natürlich nicht viel – 2018 waren es noch 63 Prozent gewesen –, aber immerhin um vier Prozentpunkte mehr als im Jahr 2023, als Pandemienachwirkungen und der Krieg an den Toren Europas die Einschätzung dominierten.
Einflussfaktor Algorithmen
Gleichzeitig verschärft die Medien- und Kommunikationslogik in online konsumierten Nachrichten und Social-Media-Plattformen die Fragmentierung: Algorithmen bevorzugen Zuspitzung. Kleinparteien und Einzelpersonen profitieren – etwa Dominik Wlazny (»Marco Pogo«) mit seiner Bierpartei, die laut Umfragen vom Mai 2025 inzwischen bei acht Prozent liegt, auch wenn Wlazny mit seinem eher mediokren Programm bei der Nationalratswahl 2024 nur zwei Prozent der Wähler überzeugen konnte und damit den Einzug in den Nationalrat verpasst hatte. Dass das nicht ohne Auswirkungen auf die Regierungsfähigkeit eines Landes bleiben kann, liegt auf der Hand: Mit vier, fünf oder mehr Parteien im Parlament wird Regierungsbildung zur Gratwanderung. Schwierige Regierungsbildungen aufgrund einer zu stark fragmentierten
politischen Landschaft sind indes weltweit längst kein Ausnahmephänomen mehr: Blockierte oder zähe Regierungsbildungen prägen zunehmend vor allem das politische Bild Europas. In vielen Ländern geraten demokratische Abläufe ins Stocken – selbst dann, wenn eine Wahl wie geplant verläuft.
Frankreichs Schande
Nach der herben Niederlage seines Mitte-Lagers bei den EU-Wahlen im Juni 2024 entschloss sich etwa Frankreichs Präsident Emmanuel Macron, die eigentlich für 2027 geplanten Parlamentswahlen vorzeitig anzusetzen. Das Ergebnis: Ein Patt zwischen dem rechtsextremen Rassemblement National (RN), Macrons zentristischem Bündnis und dem linken Wahlbündnis »Front Populaire« – eine politische Blockade, aus der es schwer war, einen stabilen Regierungspfad zu finden. Es dauerte bis September, bis Macron den ehemaligen EU-Kommissar Michel Barnier zum Premierminister ernennen konnte – ein Schritt, der insbesondere bei linken Parteien auf scharfe Kritik stieß, da Barnier als Zugeständnis an den rechtspopulistischen Rassemblement National (RN) gewertet wurde, obwohl seine eigene Fraktion nur die fünftgrößte in der Nationalversammlung ist.
Auch die Niederlande stehen sinnbildlich für die neue Normalität politischer Zähflüssigkeit: Nach den Wahlen im November 2023 zogen sich die Koalitionsverhandlungen bis in den Mai 2024 hin – ein halbes Jahr politisches Vakuum, dass der Tatsache geschuldet war, dass die rechtskonservative Partei von Geert Wilders zusammen mit der konservativen VVD fast 40 Prozent erringen konnte, die sich mit unzähligen Kleinstparteien auf eine Koalition einigen mussten. In Belgien ist man mit solchen Zuständen schon vertraut: Zwischen der Parlamentswahl 2019 und der Regierungsbildung vergingen 600 Tage. In der Zwischenzeit regierte eine Übergangsregierung – ironischerweise während der entscheidenden Phase der Corona-Pandemie. Doch auch dort, wo Regierungen zustande kommen, wird Zusammenarbeit zunehmend zur Herausforderung. In Spanien zog Ministerpräsident Pedro Sánchez nach dem schlechten Abschneiden seiner Koalitionsparteien bei Regional- und Kommunalwahlen im Juli 2023 ebenfalls vorzeitige Neuwahlen ein. Die neue Regierung konnte nur durch teils umstrittene Zugeständnisse an zahlreiche kleinere Gruppierungen gebildet werden – außerhalb des konservativen Lagers der Partido Popular (PP) und der rechtspopulistischen Vox, die eigentlich die rechnerische Stimmenmehrheit auf sich vereint hätte.
Politischer Vertrauensverlust
In Deutschland, wo es nach der Bundestagswahl 2021 immerhin zur Bildung einer Ampelkoalition kam, zeigt sich ein anderes Problem: Die Unzufriedenheit mit der Regierung aus SPD, Grünen und FDP war laut Umfragen schon drei Jahre nach der Wahl auf einem Rekordtief. Als die FDP – viel zu spät – die Reißleine zog und deren Finanzminister sich vom Bundeskanzler lieber entlassen ließ, als einer überbordenden Neuverschuldung zuzustimmen, war der Schaden längts angerichtet: Das Volk hatte angesichts der zahl-

»Statt die Sache (Anm: das Budget) in Ordnung zu bringen und die überbordenden Staatsausgaben auf das ohnehin schon sehr hohe Vorkrisenniveau zurückzuführen, beginnt die von der ÖVP geführte Regierung ihre Arbeit mit noch höheren Steuern.«
Franz Schellhorn, Agenda Austria
losen ungelösten Probleme des Landes den regierenden Parteien insgesamt das Vertrauen entzogen. In den darauffolgenden Wahlen zeigte sich das Ergebnis: Mit der CDU/CSU und der AfD wurden mehrheitlich Parteien gewählt, die zuvor das Versprechen des »Zurück zur Normalität« gegeben hatten.
Vielfalt mit Schwächen
Die Erfahrungen der jüngeren Vergangenheit zeigen eine gravierende Schwäche moderner politischer Systeme in westlichen Demokratien auf: Die Vielzahl der im Parlament vertretenen Parteien bringt zwar Vielfalt – aber erschwert kompromissfähige Politik. Programme und politische Kulturen driften immer weiter auseinander, was vor allem den extremen Rändern nutzt. Dazu kommt ein Phänomen, das eigentlich im Wunsch nach Machterhalt der großen Volksparteien in ganz Europa begründet ist: Die Brandmauerpolitik, eine Taktik, die darauf hinausläuft, den erkennbaren Wählerwillen zu ignorieren und rechtspopulistischen Parteien durch das Bilden von Mehrparteienkoalitionen die Regierungsteilhabe zu verwehren. Die Brandmauerstrategie ist mittlerweile fast drei Jahrzehnte alt; das dahinter liegende System ist durchschaubar und gerade deshalb immer wirkungsloser: Parteien, die mit teils drastischer Wortwahl einfache Lösungen für komplexe Probleme versprechen und dabei in einem immer unübersichtlicher gewordenen europäischen Vielvölkerkonglomerat, das immer mehr Probleme mit sich bringt, immer mehr Wählerstimmen auf sich vereinen, werden zunächst in die Nähe des Nationalsozialismus gerückt. Sie zu dämonisieren ist nicht schwer, denn tatsächlich propagieren sie nicht nur harte Law-&-Order-Politik, sondern betonen zudem das nationalistische Element, indem sie vor allem die ausländischen Bevölkerungsgruppen zu klaren Feindbildern stilisieren. Mit dieser unappetitlichen Methode lassen sich einfache Gemüter schnell überzeugen – aber nur wenn die etablierten Parteien selbst keine Lösungen mehr für die wachsenden politischen Probleme an anderen Fronten zu bieten haben.
Breite Angriffsflächen
Die methodische Nähe zu den diktatorischen Parteien des vergangenen Jahrhunderts bietet neben der politischen Ideenlosigkeit eine breite Angriffsfläche, die die etablierten Parteien schnell zu nutzen wussten und bis heute immer wieder sauber polieren. Die Milchmädchenrechnung: Wo sich ein drittes Lager zwischen die zwei großen Strömungen der Nachkriegszeit – nämlich die Sozialdemokratie und das Christlichsoziale – drängt, kann eine der beiden Strömungen von der politischen Teilhabe abgeschnitten werden. Wenn hingegen das dritte Lager – und alle Randerscheinungen von Team Stronach bis zur Bierpartei – so klein gehalten wird, dass sich rechnerisch immer eine große Ko-
alition zwischen Sozialisten und Volkspartei ausgeht, ist die Macht der beiden Strömungen einzementiert.
Sündenfall Cordon Sanitaire
Niemand kann genau sagen, wann und wo diese Taktik das erste Mal ihre volle Wirkung entfaltete – in Österreich jedenfalls nicht, denn Bruno Kreisky hatte in den 1970ern keinerlei Skrupel, mithilfe der FPÖ – die damals ebenso noch von echten ehemaligen NSDAP-Mitgliedern durchsetzt war wie alle Parteien – zu regieren. Erst als Jörg Haider Norbert Steger als Parteiobmann ablöste, gewann die FPÖ so an Relevanz in den Wahlen, dass sie zur echten Gefahr für die Verfechter des großkoalitionären Gedankens wurde. Auf europäischer Ebene setzte sich Ende der 1980er Jahre in Belgien endgültig die Auffassung durch, dass eine Koalition mit rechtspopulistischen Parteien ein Tabu sei: Die etablierten Parteien wollten sich nach der Wahl 1989, bei der der rechtskonservative Vlaams Blok 20 Prozent der Stimmen gewann, eindeutig nach rechts abgrenzen – und bildeten den sogenannten »Cordon Sanitaire«.
In der ursprünglichen Bedeutung war mit dem Begriff »Cordon Sanitaire« eine Pufferzone gemeint, die man zwischen zwei Gebieten absteckte, um das Ausbreiten von Pandemien zu verhindern. Schon die Wortwahl war, wie auch das deutsche »Brandmauer«, ein Meisterwerk der Propagandakunst. Aus dem Katastrophenschutz entlehnt, suggeriert beides die unbedingte Notwendigkeit ihrer Existenz – denn wenn der Cordon Sanitaire überschritten oder die Brandmauer eingerissen würde, würde sich eine Katastrophe ungehemmt ausbreiten können, sei es die Pandemie des Populismus oder der Flächenbrand vorurteilsgesteuerter politischer Entscheidungen. Wie überhaupt Sprache ein wesentlicher Teil der Ausgrenzungspolitik ehemaliger Großparteien ist – man denke etwa an das Mantra der »gesichert« rechtsextremen AfD, das, oft genug wiederholt, nicht den leisesten Zweifel am Charakter der Partei aufkommen lassen soll. Der Cordon Sanitaire erwies sich jedenfalls bald als taugliches Mittel des Machterhalts und setzte sich überall dort in Europa durch, wo rechtsnationale Parteien erstarkten: In Schweden, in Frankreich, in Belgien, in Deutschland und schließlich auch in Österreich. Galt die »Vranitzky-Doktrin«, der zufolge eine Koalition der SPÖ mit der FPÖ ausgeschlossen war, lange Zeit nur für die Sozialdemokratie, machte man sie vergangenes Jahr auch in der ÖVP salonfähig, wenn auch in abgeschwächter Form: Mit »dieser« FPÖ verbiete sich eine Koalition, erklärte Karl Nehammer, und ließ sich damit eine Hintertüre für mögliche Verhandlungen offen, denn personelle und inhaltliche Weichen sind in jeder Partei schnell gestellt – der FPÖ
wäre es ein Leichtes gewesen, zu einer »anderen« FPÖ und damit regierungsfähig zu werden.
Linke Regierung, rechte Wahl
Tatsächlich war dann bei der Nationalratswahl der Wählerwille eindeutig: Eine klare Mehrheit der Österreicher positioniert sich in wirtschafts- und migrationspolitischen Fragen rechts der Mitte. Laut einer OGM-Umfrage vom April 2025 (Sonntagsfrage, Kurier) würde wieder eine relative Mehrheit eine Koalition aus ÖVP und FPÖ möglich machen, die FPÖ wäre dabei mit fast 33 % der Seniorpartner. Dass dieses Modell Wähler mobilisieren kann, zeigen nicht zuletzt die Wahlerfolge von Sebastian Kurz 2017 und 2019. Die Realität sieht jedoch anders aus: Die sogenannte »Brandmauer zur FPÖ«, wie sie von den Grünen, der SPÖ und Teilen der ÖVP propagiert wird, verhinderte diese Option. Schon davor hatte Bundespräsident Alexander Van der Bellen mehrfach betont, keine Regierung mit »verfassungsfeindlichen Elementen« angeloben zu wollen – ein klarer Wink Richtung FPÖ. Die dann in den Regierungsverhandlungen, die man sie zähneknirschend führen lassen musste, tatsächlich wie vorausgesagt versagte. Womit sich rechnerisch für den Wahlzweiten ÖVP nur mehr eine Koalition mit einer extrem linken SPÖ ausgehen konnte.
Belastungswelle statt Sanierung
Die konnte somit die Bedingungen diktieren – und machte davon auch reichlich Gebrauch. Österreich hatte rechts bzw. konservativ gewählt – und das ziemlich eindeutig – und eine eindeutig links-
orientierte Politik bekommen. Allein das Finanzministerium für sich zu reklamieren und dort den polarisierenden AK-Ökonomen Markus Marterbauer an der Spitze zu installieren, war aus Sicht der SPÖ ein Geniestreich. Aus Sicht des Staates und wirtschaftsorientierter Kommentatoren allerdings weniger. Die großen Probleme des Staates seien weit entfernt davon, einer Lösung zugeführt zu werden: In der Migrationspolitik blieb man Antworten ebenso schuldig wie in puncto Budgetsanierung. Zu Letzterem äußerte sich Agenda-Austria-Chef Franz Schellhorn. Man habe eine ausgabenseitige Sanierung versprochen, aber eine Belastungslawine geliefert, sagte er der »Kleinen Zeitung« im Kontext des Doppelbudgets 2025 und 2026. Dieses Budget sei der kleinste gemeinsame Nenner einer Dreiparteienkoalition und nicht das lang erwartete, nötige Reformwerk.
Sorgen nicht ernst genommen
Ein im Ergebnis ähnliches Bild zeigt sich noch viel deutlicher in Deutschland. Auch dort blieb trotz eines eindeutig erkennbaren Wählerwillens für eine konservative Regierungskoalition dem Wahlsieger CDU/CSU nichts anderes übrig, als eine Koalition mit den Sozialdemokraten einzugehen. Die AfD, die über zehn Millionen Stimmen errungen hatte, musste machtlos zusehen, wie die Pfründe der Bundesrepublik an ihnen vorbei verteilt wurden. Auch in Berlin gelang es der SPD, den Finanzminister für sich zu reklamieren. Und auch in Deutschland wurde nicht das Ausgabenproblem des Staates zur Grundlage der Budgetierung gemacht, sondern ein mehrere hundert Milliarden Euro schweres Neuver-


























schuldungspaket durchgesetzt. Die Sorgen der Bevölkerung –schleichende Verarmung und zu viele Migranten aus islamischen Ländern – hingegen wurden trotz gegenteiliger Versprechungen vor der Wahl nur unzureichend behandelt.
Exzessive Schuldenpolitik
Womit man wieder auf Österreich verweisen kann – denn auch bei uns ist der Reformstau mittlerweile so gewaltig, dass schnell sichtbare Lösungen in weite Ferne gerückt scheinen. Agenda-Austria-Chef Franz Schellhorn lässt kein gutes Haar an den Reformbemühungen der Regierung: »In Österreich läuft dasselbe Spiel (wie in Deutschland, Anm.) deutlich geräuschloser ab. Wir tun uns da auch leichter, weil unsere Staatsschulden seit Jahrzehnten ungebremst steigen. Wir haben die exzessive Schuldenpolitik geradezu kultiviert. Hierzulande sind es übrigens die Konservativen, die den Staatshaushalt zerrüttet hinterlassen haben. Statt die Sache in Ordnung zu bringen und die überbordenden Staatsausgaben auf das ohnehin schon sehr hohe Vorkrisenniveau zurückzuführen, beginnt die von der ÖVP geführte Regierung ihre Arbeit mit noch höheren Steuern.«
Falsch verstandene Staatsräson
Tatsächlich summieren sich allein die Schulden der Republik mittlerweile auf exakt 297.981 Millionen Euro. Dazu kommen die Schulden von Gemeinden und Ländern. Wollte man sie schnellstmöglich zurückzahlen, müsste man ungeheure Ressourcen mobilisieren und der Bevölkerung wirklich harte Einschnitte
zumuten. Diese sind aufgrund der durch Brandmauern und Parteienfragmentierung geschaffenen Koalitionslogiken jedoch kaum durchsetzbar. Die Diskrepanz zwischen Wählerwillen und Regierungskonstellation hat auch wirtschaftspolitische Folgen. Themen wie Steuererleichterungen, Deregulierung, Energiepreisdeckel oder Migration bleiben auf der Strecke, weil breite politische Kompromisse in einer saturierten Mitte gesucht und dann natürlich nicht gefunden werden. Franz Schellhorn kommentiert im Profil folgerichtig: »Sowohl in Österreich als auch in Deutschland beschreiten die bürgerlichen Parteien den Weg des geringsten Widerstands und verklären den Verrat an ihren Wählern zur Staatsräson. Staatsräson heißt aber nicht, FPÖ und AfD mit höheren Steuern und Schulden von der Macht fernzuhalten. Staatsräson bedeutet, das Land mit überzeugenden Reformen wieder in die Spur zu bringen und damit zu riskieren, die nächste Wahl zu verlieren. Mit höheren Steuern und Schulden werden die rechtsnationalen Kräfte nicht geschwächt. Sie werden gestärkt.«
Die Erkenntnis, dass das Fortführen dieses politischen Auslaufmodells letztlich bestenfalls zu einem fortgesetzten Vertrauensverlust in die demokratischen Entscheidungsfindungsmechanismen und im schlechtesten Fall zu gravierenden sozialen Unruhen führt, hat sich noch nicht überall durchgesetzt. Die Politik wird sich früher oder später entscheiden müssen: Will sie sich weiter in Mikropartikularismen und Machterhaltungsfantasien verlieren oder gelingt der Sprung zu einer neuen politischen Kultur, die Komplexität ernst nimmt, aber Entscheidungen trifft?
























Ich möchte glauben, dass die USA an unserer Seite bleiben werden.
Aber wir müssen bereit sein, wenn das nicht der Fall ist.
Staatspräsident Emmanuel Macron in einer Ansprache an das französische Volk

Wunschdenken statt Wirklichkeit – Marterbauers Budget steht auf tönernen Füßen
Der von Finanzminister Markus Marterbauer vorgelegte Budgetentwurf für 2025/26 erscheint auf den ersten Blick als Kraftakt – tatsächlich basiert er auf überoptimistischen und schöngerechneten Erwartungen. Die Regierung geht für das Jahr 2025 nämlich immer noch von einem Wirtschaftswachstum von 1,6 Prozent aus, während für 2026 sogar ein Wachstum von 1,8 Prozent erwartet wird. Dabei geht die ÖNB schon seit ihrer März-Prognose für das Gesamtjahr 2025 von einer Stagnation der Wirtschaftsleistung (-0,1 %) aus. Und auch für 2026 kann von +1,8 Prozent keine Rede sein. Die ÖNB prognostiziert lediglich 1,2 Prozent Wachstum. Finanzminister und Bundesregierung igno -
Das Doppelbudget von Finanzminister Marterbauer enthält zwar kurzfristige Einsparungen, es fußt jedoch auf falschen Wachstumsannahmen und echte Reformen findet man darin auch nicht.
den Einnahmen und einer disziplinierten Ausgabenkultur sind angesichts der ÖNB-Prognose völlig ungesichert.
Auch die Zinsbelastung dürfte höher als im Budget angenommen werden Hinzu kommt: Die Schuldenquote soll bis 2029 lediglich von 87 auf 86,9 Prozent sinken – ein kosmetischer Effekt, erkauft durch ein Zahlenwerk, das die konjunkturellen Risiken und Zinsdynamiken ausblendet. Ein ernst gemeinter Konsolidierungspfad würde daher gänzlich anders aussehen, ist aber in der derzeitigen Regierungskonstellation kaum umzusetzen. Der Finanzminister verweigert sich aus „Regierungsräson“ realistischen Wachstumsannahmen und einer glaubwürdigen Priorisierung auf der Ausgabenseite. Voraussetzung dafür wäre nämlich der transparente Umgang mit den Risiken seiner veralteten Wachstumsannahme – samt deren Auswirkungen auf die Pensionsausgaben, die Gesundheit und die steigenden Zinslasten, die von Marterbauer einem Prozent womöglich auch viel zu optimistisch dargestellt werden.
rieren daher immer noch, dass sich Österreichs Staatsfinanzen nicht mit kosmetischen Eingriffen sanieren lassen.
Die Wachstumserwartungen sind wieder einmal viel zu optimistisch Ein Defizit von 18,1 Milliarden Euro im Jahr 2025 und von 18,3 Milliarden im Folgejahr ist ohnehin kein Sanierungsbudget, sondern die Fortschreibung eines strukturellen Ungleichgewichts. Auch die Annahme, dass sich das Defizit „von selbst“ bis 2028 auf Maastricht-konforme drei Prozent verringert, ohne tiefgreifende Reformen in der Ausgabenstruktur oder nachhaltige Wachstumsimpulse, ist reines Wunschdenken. Die zugrunde liegende Prognose rechnet – nachweislich falsch – mit stabilem Wachstum. Auch die daraus resultierenden Annahmen von steigen -
Dringende Reformen werden weiter verschleppt
Der politische Kompromiss der Bundesregierung ist zwar voll mit Schlagworten wie „Reformen“ und „Investitionen“, liefert ab kaum belastbare Maßnahmen, die der jeweils eigenen Klientel der drei Regierungsparteien zuwiderlaufen würden. Vor dem Hintergrund bewusst fragwürdiger Grundannahmen klingt die Ankündigung einer „neuen Ära der Transparenz“ daher eher zynisch. Das Doppelbudget sendet kein Signal der Stabilität, sondern des Verschiebens. Österreich steuert nicht trotz, sondern wegen einer Budgetpolitik, die sich weigert, der Realität ins Auge zu sehen, in ein EU-Defizitverfahren. Aber vielleicht ist es aus Regierungsperspektive ja tatsächlich bequemer, die Verantwortung für zwangsläufig notwendige Einschnitte

bei den Ausgaben nicht nur zu verschieben, sondern gleichzeitig auf Brüssel abzuwälzen.
Eine Haushaltskonsolidierung mit Wachstumsimpulsen kann auch in der Rezession funktionieren
Denn Österreich kämpft nicht nur mit wachsenden Schuldenbergen, sondern, wie viele Ökonomen von Christian Helmenstein abwärts längst befürchten, auch damit, dass der nun dreijährigen Rezession ohne deutliche Wachstumsimpulse eine noch längere Phase der Stagnation folgen könnte. Für die Budgetpolitik ergibt sich daraus eine doppelte Herausforderung. Zum einen ist die Konsolidierung unausweichlich, zum anderen würden Kürzungen zur falschen Zeit oder mit dem falschen Instrumentarium die wirtschaftliche Schwäche noch verschärfen. Was also tun, wenn die Notwendigkeit zur Haushaltskonsolidierung auf eine hartnäckige Rezession trifft?
Abwarten löst keine Budgetprobleme Klar ist, dass auch in einer Rezession Folgendes gilt: Abwarten löst keine Budgetprobleme. Im Gegenteil – die verschleppte Konsolidierung verschärft mittelfristig die strukturellen Defizite und erhöht die Zinslast. Dennoch muss der Einstieg in die Konsolidierung konjunkturgerecht gestaltet werden. Das bedeutet nicht, gar nichts zu tun, sondern mit gezielten, wachstumsverträglichen Maßnahmen zu beginnen, die das Vertrauen der Märkte und der Investoren stärken – ohne die gesamtwirtschaftliche Nachfrage abrupt abzuwürgen. Möglich, dass der Finanzminister ja genau das vorhat. Aber geschönte Wachstumszahlen sind entweder schlechter Stil oder ein Kopf-in-den-Sand-Stecken. Denn auch in einer wirtschaftlichen Schwächephase müssen vor allem Ausgaben reduziert werden. Und zwar jene, die wenig oder keinen Beitrag zum langfristigen Wachstum leisten. Dazu zählen ineffiziente Subventionen, überbordende Verwaltungs-
MIT JOHANNES TANDL
ausgaben, politisch motivierte Zuschüsse ohne Hebelwirkung sowie teure Förderprogramme mit geringen Multiplikatoreffekten. Und natürlich müssen strukturfördernde Ausgaben (für Bildung, Digitalisierung, Infrastruktur mit hoher Produktivitätsrendite) geschützt bleiben oder gezielt umgeschichtet werden.
Reformen sind langsam, aber dafür langfristig budgetwirksam Konsolidierung bedeutet nicht pauschales Sparen, sondern Prioritätensetzung. Ein von der Regierung völlig unterschätzter Hebel liegt in reformpolitischen Maßnahmen, die keine neuen Ausgaben verursachen und teilweise sogar Einsparungen bringen. Zu nennen sind einmal mehr Deregulierung und Bürokratieabbau, insbesondere bei Genehmigungen und Zugangsbeschränkungen zum Arbeitsmarkt und immer noch bei Betriebsgründungen.
Auch bei Maßnahmen zur Arbeitsmarktaktivierung etwa durch gezieltere Qualifizierung, bessere Anreize zur Arbeitsaufnahme oder flexiblere Beschäftigungsmodelle überwiegt der Nutzen die Kosten. Und außerdem gilt es endlich eine heilige Kuh der ÖVP zu schlachten und die Effizienzsteigerung im öffentlichen Sektor, etwa durch die Digitalisierung, aber auch durch eine permanente outputorientierte Aufgabenreform in eine Verwaltungsverschlankung umzumünzen. Solche Maßnahmen wirken zwar nicht kurzfristig konjunkturstützend, aber sie verbessern die Investitionsbedingungen und erhöhen die Wettbewerbsfähigkeit und damit die langfristigen Wachstumschancen – was wiederum zur Budgetkonsolidierung beiträgt, selbst wenn es kaum kurzfristige Effekte auf das Defizit gibt.
Schweden zeigt, das Wachstumsimpulse und Konsolidierung zusammenpassen Einnahmenverbesserungen gehören zwar auch zur Budgetkonsolidierung,
sie sind in rezessiven Phasen jedoch kontraproduktiv, weil sie die Haushalte und Unternehmen zusätzlich belasten. Wesentlich zielführender ist da schon die Schließung von Steuerschlupflöchern, etwa im internationalen Konzernsteuerrecht, oder die Bekämpfung von Steuervermeidung und -hinterziehung durch die bessere Digitalisierung der Finanzverwaltung.
Der schwedische Weg zeigt, wie sich Konsolidierung auch unter schwierigen Rahmenbedingungen nachhaltig gestalten lässt: Dort wirkt die sogenannte „regelbasierte Haushaltsführung“ mit klaren Zielen und Ausgabenobergrenzen. Ein glaubwürdiger mittelfristiger Konsolidierungspfad mit verbindlichen Eckwerten reduziert außerdem trotz Schulden die Risikoaufschläge auf Staatsanleihen und stärkt die Planbarkeit für Wirtschaft und Verwaltung. So kann auch bei zunächst laufendem Defizit das Marktvertrauen stabilisiert werden. Natürlich braucht jede Konsolidierung ihre politische Legitimität. Daher ist es besonders in der Rezession entscheidend, den Bürgerinnen und Bürgern klar zu vermitteln, warum jetzt gehandelt werden muss und wie die Maßnahmen langfristig zu mehr Stabilität, Wachstum und sozialer Sicherheit beitragen. Aber auch eine transparente, faktenbasierte Kommunikation und ein kohärenter Reformplan sind bis jetzt nicht Teil des österreichischen Konsolidierungskurses.
Auch in der Rezession bleibt Budgetkonsolidierung also notwendig – aber sie muss klug gestaltet werden. Statt mit pauschalen Kürzungen die Konjunktur zu bremsen, sollten Staaten auf wachstumsfreundliche Priorisierung, regelbasierte Steuerung und strukturelle Reformen setzen. Es gibt gute Beispiele, wie sich auch in wirtschaftlich schwierigen Zeiten eine fiskalische Trendwende einleiten lässt – mit langfristig positiven Effekten für Staat, Wirtschaft und Gesellschaft.
Die Freiheit der Eheschließung und des Familienlebens im europäischen Verfassungsgefüge

Die Charta der Grundrechte der Europäischen Union (GRC) verankert in Artikel 9 das Recht auf Eheschließung und das Recht, eine Familie zu gründen. Die Norm formuliert dies bewusst offen, sie gibt Anlass zu einer differenzierten Betrachtung im Spannungsfeld zwischen nationaler Souveränität und europäischer Grundrechtsbindung. Artikel 9 GRC unterscheidet sich in seiner Formulierung signifikant von Artikel 12 der Europäischen Menschenrechtskonvention (EMRK), der ausdrücklich von einer Ehe zwischen »Mann und Frau« spricht. Die Charta verzichtet auf eine solche Einschränkung und erlaubt somit eine dynamische Auslegung, die insbesondere die rechtliche Anerkennung gleichgeschlechtlicher Ehen oder anderer Formen des familiären Zusammenlebens nicht ausschließt. Der Europäische Gerichtshof (EuGH) hat wiederholt klargestellt, dass die Charta im Rahmen des Unionsrechts anzuwenden ist und nicht automatisch eine Angleichung der Ehe- und Familienrechte in den Mitgliedstaaten erzwingt.
Die EU ist nicht befugt, eine unionsweite Definition der Ehe oder des Familienrechts vorzugeben, da diese Bereiche weitgehend in der Gesetzgebungskompetenz der Mitgliedstaaten verbleiben. Dennoch wirkt das Unionsrecht über Mechanismen wie »die Freizügigkeit« oder »die Nichtdiskriminierungsgrundsätze« in diesen Bereich hinein. So hat der EuGH in der Rechtssache Coman u. a. (C-673/16) entschieden, dass die Mitgliedstaaten die Aufenthaltserlaubnis für Ehepartner unionsweit anerkennen müssen – unabhängig davon, ob sie gleichgeschlechtliche Ehen selbst in ihrem nationalen Recht zulassen.
Die Rechtsentwicklung zeigt, dass sich die Grenzen zwischen nationalen Kompetenzen und europäischem Grundrechtsschutz zunehmend verschieben. Während Mitgliedstaaten das Recht haben, eigene Regelungen zur Ehe und Familie beizubehalten, müssen sie unionsrechtliche Vorgaben, insbesondere im Bereich der Diskriminierungsfreiheit und der Personenfreizügigkeit, respektieren. In Zukunft könnte sich der unionsrechtliche Einfluss auf Ehe- und Familienrechte weiter verstärken, insbesondere durch eine Ausweitung der Rechtsprechung des EuGH oder durch legislativen Druck in Form von Antidiskriminierungsrichtlinien.
Fazit: Artikel 9 GRC garantiert das Recht auf Ehe und Familie, überlässt die konkrete Ausgestaltung jedoch den Mitgliedstaaten. Dennoch beeinflusst das Unionsrecht die nationale Rechtsentwicklung zunehmend, insbesondere durch die EuGH-Rechtsprechung und die unionsrechtlichen Grundprinzipien.
Dr. Andreas Kaufmann ist Rechtsanwalt und Universitätslektor in Graz. Er ist spezialisiert auf Bau-, Immobilien-, Wirtschafts- und Nachhaltigkeitsrecht. ak-anwaltskanzlei.at

An drei Grazer SPAR-Standorten findet täglich von 14:00 bis 15:00 Uhr die „Stille Stunde“ statt.
Als Nahversorger Nummer 1 trifft das Einzelhandelsunternehmen SPAR auf vielfältige individuelle Bedürfnisse der Kundschaft. Um den hochsensiblen und reizempfindlichen Menschen den Lebensmitteleinkauf angenehmer zu gestalten, findet in Zukunft an drei SPAR-Standorten in Graz eine sogenannte „Stille Stunde“ statt. Das bedeutet, dass dort zwischen 14 und 15 Uhr gänzlich auf Musik und Werbedurchsagen verzichtet wird.
Die Umsetzung der Stille Stunde findet an folgenden Standorten von Spar-Supermärkten in Graz statt: in der Fischergasse, in der Olga-Rudel-Zeynek-Gasse bei der Green City und in der Conrad-von-Hötzendorfstraße 99a gegenüber dem Ostbahnhof. Das heißt für die Kunden und Kundinnen Einkaufen ohne Radio, ohne Musik und ohne Werbung: Von Montag bis Samstag wird in den Geschäften für eine Stunde am Nachmittag von 14 bis 15 Uhr die gesamte Ladenbeschallung ausgeschaltet.
Geräusche als Herausforderung
Vom Piepsen der Scanner-Kassen über Gespräche zwischen anderen Personen bis zur Hintergrundmusik: Während der Großteil der Menschen all die unterschiedlichen Geräusche im Supermarkt entweder gar nicht oder nicht als besonders störend wahrnimmt, kann die Reizüberflutung für die Gruppe der hochsensiblen Menschen herausfordernd sein. Als Marktführer im österreichischen Lebensmitteleinzelhandel ist sich SPAR seiner Verantwortung bewusst und probiert neue Formate aus, um sich für Menschen mit speziellen Bedürfnissen starkzumachen.
Positive Reaktionen der Kundschaft
„Wir sind offen für neue Ideen, die den Menschen guttun – gerade bei so etwas Elementarem wie dem Lebensmitteleinkauf“, unterstreicht SPAR-Steiermark-Geschäftsführer Christoph Holzer. Die Gruppe der Kunden und Kundinnen, die Reize stark wahrnehmen und daher die Stille Stunde als besonders wohltuend empfinden, betrifft sowohl Männer als Frauen und geht quer über alle Altersschichten.
Schloss Eggenberg feiert 400-JahrJubiläum

Unter dem Titel „Ambition & Illusion“ ist Schloss Eggenberg seit 26. April der Schauplatz der dritten Steiermark-Schau, die vom Land Steiermark beauftragt und vom Universalmuseum Joanneum umgesetzt wird. Das UNESCO-Welterbe des historischen Gebäudes steht dabei im Mittelpunkt. Eine multimediale Ausstellung mit einzigartigen Leihgaben lädt dazu ein, einen ganz neuen Blick auf die Geschichte des Schlosses und seine Bewohner und Bewohnerinnen zu werfen. Alle Museen vor Ort ergänzen diese außergewöhnliche Schau und entführen heuer in die Welt der Eggenberger. Anlass dafür ist das 400-Jahr-Jubiläum des ambitionierten Schlossbaus, der im Jahr 1625 von Hans Ulrich von Eggenberg in Auftrag gegeben wurde.

Der RC Graz-Burg veranstaltet heuer zum zweiten Mal ein Sommerfest mit Livemusik und Kulinarik, das am 28. Juni am Graz Airport im Restaurant Globetrotter stattfinden wird. Unter dem Motto „Musik liegt in der Luft am Graz Airport“ erwartet Sie eine musikalische Reise mit bekannten Jazz-Nummern, interpretiert von Vesna Petkovic und ihrem Quartett, und Big Band Sound von der Rotary Big Band. Der Erlös kommt dem Projekt „Mehr Freu(n)de mit Deutsch“ zugute. Seit über zwölf Jahren werden Sprachförderstunden an der VS Gabelsberger finanziert für Kinder, die die Sprache ihrer neuen Heimat erlernen müssen. Die Vermittlung der Freude an der deutschen Sprache, bewegtes Lernen, Förderung individueller Begabungen sowie Eingehen auf spezifische Bedürfnisse der Schülerinnen und Schüler stehen im Vordergrund der Sprachförderung. Homepage und Kartenverkauf unter:www.sommerfest-airport.at

Ansturm bei Eröffnung der Steiermark-Schau
Es ist ein Barockjuwel und über die Grenzen hinaus bekannt: Schloss Eggenberg am Grazer Stadtrand ist seit 2010 UNESCOWeltkulturerbe. Hans Ulrich, der erste Fürst von Eggenberg, gab 1625 den Auftrag, dieses Residenzschloss zu bauen. Das 400-Jahr-Jubiläum ist Anlass für die diesjährige SteiermarkSchau, die unter dem Titel „Ambition & Illusion“ dem Schloss und all seinen Bewohnern eine Ausstellung widmet. Am 26. April wurde die Schau mit zahlreichen Besuchern, darunter viele Ehrengäste aus Kunst, Kultur, Politik und Wirtschaft, eröffnet – musikalisch umrahmt vom Ensemble Art House 17 mit den „Sounds of Eggenberg“. Bis 2. November bietet die Schau vor Ort die Möglichkeit, in die Welt der Eggenberger einzutauchen.
Grawe siegt bei Recommender Award 2025



Bereits zum 13. Mal in Folge sicherte sich die Grawe den ersten Platz in der Kategorie „Versicherungen bundesweit“ und wurde auch 2025 wieder mit dem „Recommender Award“ des FMVÖ ausgezeichnet. Damit werden jene Institute bedacht, die bei Kundenbefragungen die höchste Quote an Weiterempfehlungen verzeichnen. Bereits zum 13. Mal in Folge sicherte sich die Grawe den ersten Platz in dieser Kategorie. Bei der FMVÖ-Recommender-Gala am 6. Mai in Wien nahm Vorstandsdirektor Georg Schneider die Auszeichnung stellvertretend für alle Mitarbeiter sowie Partner entgegen. Daneben bestätigt auch das Gütesiegel „Exzellente Kundenorientierung“ die konsequente Ausrichtung der Grawe auf Servicequalität und Kundenzufriedenheit.

von Graz nach Leibnitz
Sonntag, 15. Juni 2025
8.30 Uhr, Brauerei Puntigam | Start 9.30 Uhr EinzelfahrerIn
Im Ziel erwarten Sie:
• Großes Familienfest mit Musik (Beppo‘s Dance Band)
• Große Warenpreisverlosung
• Gesundheitscheck Arbeiterkammer
• Kinderbetreuung –Hüpfburg, Kletterturm
Sonderzug Leibnitz–Graz AK-ÖGB Betriebssportverband 05 7799-2329 | betriebssport@akstmk.at www.akstmk.at/betriebssport www.betriebssport.st

Die Ausstellung „Man will uns ans Leben − Bomben gegen Minderheiten 1993 – 1996“ im Grazer Volkskundemuseum erinnert an den Schrecken des rechtsextremen Terrors und die Angst, die Österreichs Minderheiten vier Jahre lang begleitete. Im Zentrum der Ausstellung steht die Perspektive jener, die Ziel des Terrors waren. Sie gedenkt der Opfer, lässt Betroffene zu Wort kommen und beleuchtet die Rolle des politisch-gesellschaftlichen Klimas der 1990er-Jahre für die Gewalttaten. Videointerviews mit Zeitzeugen und Experten kommentieren Facetten der Geschehnisse aus unterschiedlichen Blickwinkeln. Zahlreiche ORF-Berichte, Zeitungsartikel mit Fotos bzw. Aussagen und Zitate dokumentieren die mediale Auseinandersetzung mit den Ereignissen.


Die Grawe blickt auf ein erfolgreiches Geschäftsjahr 2024 zurück. Trotz geopolitischer und wirtschaftlicher Herausforderungen steigerte sie die Prämieneinnahmen um 9,4 % auf 966,2 Mio. Euro. Die Grawe Group erzielte sogar ein Plus von 11,8 % auf 1.529,4 Mio. Euro. Der Konzerngewinn vor Steuern wuchs um 13,2 % auf 195,7 Mio. Euro, während die AG einen Rückgang um 14,8 % auf 69,6 Mio. Das positive Bild setzte sich auch im Konzernabschluss fort. Im abgelaufenen Geschäftsjahr sind die Prämieneinnahmen um 11,8 % gestiegen und erreichten einen Wert von 1.529,4 Mio. EUR. Der Gewinn vor Steuern konnte deutlich gesteigert werden und lag 2024 bei 195,7 Mio. EUR. Die neue Gesundheitsversicherung Grawe „MyMed“ übertraf die Erwartungen deutlich.
UMJ trauert um Kurt Jungwirth



Jetzt ab € 26.090,–¹
oder ab € 189,– mtl. bei Leasing¹
Ford Puma Gen-E: Stromverbrauch: 13,1 – 14,5 kWh/100 km (kombiniert) | CO₂-Emissionen: 0 g/km (kombiniert) | Elektrische Reichweite: je nach Serie bis zu 347 – 376 km* (Prüfverfahren: WLTP)

Symbolfoto | *Gemäß Worldwide Harmonised Light Vehicles Test Procedure (WLTP). Es können bis zu 347 – 376 km Reichweite (beabsichtigter Zielwert nach WLTP) bei voll aufgeladener Batterie erreicht werden – je nach vorhandener Serien- und Batterie-Konfiguration. Die tatsächliche Reichweite kann aufgrund unterschiedlicher Faktoren (z.B. Wetterbedingungen, Fahrverhalten, Streckenprofil, Fahrzeugzustand, Alter und Zustand der Lithium-Ionen-Batterie) variieren. **Öffentliche DC-Schnellladestationen können von 10 % bis 80 % in 23,2 Minuten laden. Der Ford Puma Gen-E kann mit maximal 100 kW geladen werden. Basierend auf einem Ford Puma Gen-E ohne Optionen. Die Ladeleistung nimmt mit steigendem Ladezustand ab. Die tatsächlichen Ladezeiten können aufgrund unterschiedlicher Faktoren (z.B. Wetterbedingungen, Fahrverhalten, Streckenprofil, Fahrzeugzustand, Alter und Zustand der Lithium-Ionen-Batterie) abweichen. 1) Unverbindlich empfohlener, nicht kartellierter Richtpreis inkl. USt. für Privatkunden, beinhaltet bereits Importeurs-nachlass sowie Ford Credit Bonus und Versicherungsbonus. Berechnungsbeispiel am Modell Puma BEV Gen-E 5-Türer Elektromotor 124 kW (168PS) 1-Gang-Automatikgetriebe FWD: Aktionspreis € 26.090,–; Anzahlung € 7.827,–; Laufzeit 48 Monate; 10.000 Kilometer/Jahr; Restwert € 12.570,87; monatliche Rate € 189,–; Sollzinssatz 5,49 %; Effektivzinssatz 5,95 %; gesetz. Vertragsgebühr € 168,99; zu zahlender Gesamtbetrag € 29.638,86; Gesamtkosten € 3.548,86. Die Abwicklung der Finanzierung erfolgt über Ford Credit, ein Service der Santander Consumer Bank. Bankübliche Bonitätskriterien vorausgesetzt. Abschluss eines Vorteilssets der Ford AutoVersicherung (Versicherer: GARANTA Versicherungs-AG Österreich) vorausgesetzt. Freibleibendes unverbindliches Angebot, vorbehaltlich Änderungen, Irrtümer und Druckfehler. Nähere Informationen erhalten Sie bei Ihrem Ford-Partner.
Der langjährige Präsident des Kuratoriums des Universalmuseums Joanneum, Prof. Kurt Jungwirth, ist am 13. Mai 2025 im 96. Lebensjahr verstorben. Mehr als 30 Jahre lang – von 1991 bis 2022 – wirkte er als Vorsitzender dieses ehrenamtlichen Gremiums, das von der Steiermärkischen Landesregierung eingesetzt wird, um für das Museum beratend und unterstützend tätig zu sein. In dieser Funktion hat Prof. Jungwirth das Universalmuseum Joanneum nachhaltig geprägt und wesentlich zur positiven Entwicklung des Hauses beigetragen, nachdem er bereits zuvor als Kulturreferent der Steiermärkischen Landesregierung von 1970 bis 1991 für das Museum zuständig war und die Reformierung des Joanneums eingeleitet hatte.
Kulturbudget-Proteste zeigen Wirkung
Wie am 28. April Kulturlandesrat Kornhäusl bekanntgab, soll das steirische Kulturbudget nun doch steigen. Für SPÖ Klubobmann Hannes Schwarz auch eine Folge der Proteste der Opposition: „Wir haben den vielen betroffenen Kulturschaffenden von Anfang an versprochen, dass wir nicht ruhen werden, bis die blau-schwarze Landesregierung ihren kulturpolitischen Irrweg beendet. Die Erhöhung des Budgets ist ein erster Schritt in die richtige Richtung und zeigt, dass unser Druck wirkt“, sagt Schwarz und ergänzt: „Daher werden wir selbstverständlich genau darauf achten, ob die nun zur Verfügung stehenden Mittel auch tatsächlich eingesetzt werden. Versprechen kann man viel – am Ende zählt die Umsetzung und daran werden wir Landesrat Kornhäusl messen.“

Contact30 − die Zukunft der Mobilität
Mit über 730 Teilnehmern und 87 Unternehmen und Institutionen war der Contact30 – ACstyria Mobilitätskongress am 8. Mai 2025 ein voller Erfolg und ein klares Bekenntnis zur Steiermark als führende Mobilitätsregion Europas. Im einzigartigen Ambiente des Hangars am Flughafen Graz wurden hochkarätige Keynotes, visionäre Branchenpanels (Autocontact, Aircontact, Railcontact) sowie eine umfassende Leistungsschau geboten. Internationale Speaker von Unternehmen wie Mahindra, BMW, Rheinmetall, Siemens Mobility und viele weitere teilten ihre Perspektiven auf die Transformation der Mobilität. Ein besonderes Highlight war die Abendveranstaltung mit festlicher Netzwerk-Gala, bei der 30 Jahre ACstyria Mobilitätscluster gewürdigt wurden.

Leopold Städtler feiert 100. Geburtstag
GAK-Ehrenpräsident Rudi Roth und Kulturlandesrat Karlheinz Kornhäusl gratulierten nach einer Festmesse im Grazer Dom am 23. April Prälat Leopold Städtler zu seinem 100. Geburtstag. Als Zeitzeuge, Seelsorger und Gestalter des kirchlichen Lebens prägte er Generationen –mit einem festen Glauben, menschlicher Wärme und beeindruckender Lebensenergie. Der langjährige GAK-Fan wurde zu diesem freudigen Anlass von Rudi Roth mit einem originellen GAK-Trikot bedacht. Als Alpenkönig und Menschenfreund gewürdigt, wurde Städtler von vielen Gratulanten gefeiert, unter ihnen Bischof Wilhelm Krautwaschl, Neo-Weihbischof Johannes Freitag, Alt-Landeshauptmann Hermann Schützenhöfer, Stadtrat Günter Riegler und viele weitere.

Grandiose Eröffnung des Designmonats
Über 900 Besucher und Besucherinnen, darunter weitgereiste internationale Gäste der UNESCO City of Design Graz, waren am Abend des 9. Mai Teil des Grand Openings zum diesjährigen Designmonat Graz. Mit dem Programmfokus „The New Real“ spürt dieser der Frage nach, welche aktuellen und künftigen Auswirkungen Künstliche Intelligenz auf den Kreativbereich und zentrale Aspekte der Gesellschaft hat. So kamen auch die Eröffnungsworte seitens des Landesrats Willibald Ehrenhöfer, CIS-Geschäftsführer Eberhard Schrempf und Stadtrat Günter Riegler KI-generiert vom Band – gefolgt von einem kurzen Bühnenauftritt. Eingeleitet wurde die Eröffnungs-Show mit einer KI-Modenschau, organisiert von Flare Talents.

Mark Perz, Vorstand Mobilität und Freizeit der Holding Graz
Worin liegen die größten Herausforderungen bei den Baustellen für den Straßenbahnausbau im Sommer?
Wie ich schon wiederholt betont habe, wird es dieses Mal besonders herausfordernd. Von Mai bis September werden die Grazer Öffis von den Dauerbaustellen ausgebremst. Wir nutzen das Andocken der Schienen der Innenstadtentlastungsstrecke an die Annenstraße für zahlreiche weitere Arbeiten im Grazer Westen. Von dort aus einen passenden Schienenersatzverkehr zu konzipieren, ist für uns aus betrieblicher Sicht die größte Herausforderung.
Sind die Material- und Personalressourcen für den Ersatzverkehr ausreichend?
Ein so umfangreicher Schienenersatzverkehr ist – gerade in den Urlaubsmonaten – immer eine Herausforderung für die Kollegen und Kolleginnen der Planung. Ein Beispiel: Wir kaufen bei den Bussen externe Ressourcen zu. Fakt ist aber, dass Ersatzbusse die Straßenbahnen nie zur Gänze ersetzen können.
Welche Vorzüge bieten die neuen Straßenbahngarnituren ab kommendem Jahr?
Wir brauchen die neuen Bahnen für den Ausbau des ÖV dringend. Daher ist aus betrieblicher Sicht der größte Vorzug, dass die im zeitlichen Abstand gelieferten 15 Straßenbahnen das ÖV-Angebot der Straßenbahnen in Graz um eine 30 Prozent höhere Fahrgastkapazität optimieren. Die neue Straßenbahngeneration bringt aber nicht nur mehr Platz, sondern auch eine moderne Ausstattung.

Die Grazer Frühjahrsmesse 2025 präsentierte sich vom 30. April bis 4. Mai als lebendiger Treffpunkt für Familien, Genießer sowie Sportbegeisterte. Bei Frühlingswetter zog es zahlreiche Besucher und Besucherinnen auf das Grazer Messegelände, das mit einem vielfältigen Programm und besonderen Highlights überzeugte. „Wir haben gesehen, dass bestimmte Schwerpunkte wie das Familienprogramm mit diversen Mitmach-Stationen, das Garten- und Wohnsegment sowie das regionale Genussangebot besonders gut angenommen wurden“, erklärt Messeleiter Helmut Sechser. Der neue GF Martin Ullrich denkt schon weiter: „Die richtige Themensetzung bietet großes Potenzial und dieses werden wir in Zukunft noch stärker fokussieren und qualitativ weiterentwickeln.“

Energie Graz senkt Strompreis um 25 Prozent
Die Großhandelspreise für Strom haben sich im Laufe des letzten Jahres auf niedrigerem Niveau stabilisiert. „Daher kommen wir erneut zeitnah unserem Versprechen nach, die positive Marktentwicklung so rasch wie möglich an unsere Kundinnen und Kunden weiterzugeben“, so die GF Josef Landschützer und Boris Papousek der Energie Graz. Per 1. Oktober 2025 senkt die Energie Graz daher die Fixpreis-Tarife für Strom um 25 Prozent auf 15,78 Cent brutto pro Kilowattstunde. Insgesamt profitieren mehr als 70.000 Grazer Haushalte und Kleingewerbebetriebe. Daneben verfügt die Energie Graz als Alternative über einen Flex-Tarif mit dynamischer Preisanpassung sowie über einen Naturstrom-Tarif aus 100 Prozent regionalen erneuerbaren Energiequellen.


Die Zukunft der Grazer Mobilität nimmt Gestalt an: Alstom und die Holding Graz haben die erste Flexity™ Graz Straßenbahn im Werk präsentiert. Die 15 neuen Fahrzeuge werden 2026 den Linienbetrieb aufnehmen und die Fahrgastkapazität in Graz um 30 % erhöhen. Damit werden spürbare Entlastungen der Innenstadt sowie ein verbessertes Fahrgastangebot erzielt. Weltmarktführer Alstom liefert damit eine zukunftsweisende Ergänzung für das urbane Verkehrsnetz. Bereits 2019 und 2020 wurden im Zuge einer europaweiten Ausschreibung Probefahrten und umfassende Tests durchgeführt, um den hohen Anforderungen in puncto Lärm- und Erschütterungsarmut gerecht zu werden. Nach Abschluss des Auswahlverfahrens 2023 fiel die Entscheidung auf Alstom (damals Bombardier).
Saubermacher und die Meinhardt Städtereinigung GmbH & Co. KG bauen im südhessischen Ginsheim-Gustavsburg eine der modernsten Batterierecyclinganlagen Europas. Diese verarbeitet bis zu 100 Tonnen Haushaltsbatterien pro Tag. Auch Elektroaltgeräte (EAG) werden in der hochautomatisierten und KI-gestützten Anlage aufbereitet. Die Investition im zweistelligen Millionenbereich wird von den Partnern gemeinsam finanziert. Saubermacher-Gründer Hans Roth: „Mit dem Joint Venture setzen wir ein starkes Zeichen für Innovation. Hier bündeln zwei Umweltprofis ihre Kompetenzen, um das Recycling von Batterien und Elektroaltgeräten nach vorne zu treiben und damit die Vision „Zero Waste“ gemeinsam Wirklichkeit werden zu lassen.“

Energie Steiermark Vorstands-Team Martin Graf (li.) und Werner Ressi
Die Energie Steiermark hat im Jahr 2024 mit Investitionen von rund 300 Mio. Euro ein deutliches Zeichen für Nachhaltigkeit und wirtschaftliche Impulse im Süden Österreichs gesetzt. Im Fokus stehen der Ausbau erneuerbarer Energie und die Modernisierung der Netzinfrastruktur.
Wir sind einer der größten Impulsgeber für Wirtschaft und Arbeitsmarkt der Region“, so die Vorstände Martin Graf und Werner Ressi bei der Präsentation der Bilanz. Diese zeigt ein solides operatives Ergebnis (EBIT) von 113,6 Mio. Euro sowie eine deutlich gestärkte Eigenkapitalquote von 42,6 %.
Der operative Cashflow beträgt 310,9 Mio. Euro – ein kräftiger Umschwung gegenüber dem Minus des Vorjahres. Standard & Poor’s bestätigte die Bonität mit einem „A“-Rating. Als Eigentümer erhält das Land Steiermark eine Dividende von 70 Mio. Euro, ein Plus von 10 Mio. gegenüber 2023.
Grüner Strom mit Rückenwind
Ein besonderer Fokus liegt auf Windkraft: Drei Großprojekte – Freiländeralm II, Soboth-Eibiswald und die nun genehmigte Stubalm – repräsentieren allein fast 500
Mio. Euro an Investitionsvolumen. Parallel laufen Verfahren für neue Wasserkraftund Photovoltaikprojekte, wie etwa der 22-MWp-Solarpark in Dobl. Auch neue Wege werden beschritten: Eine Wasserstoff-Tochtergesellschaft wird 2025 gegründet, um diesen Zukunftsbereich in enger Abstimmung mit der Industrie zu entwickeln.
Ein Leuchtturmprojekt ist zudem das Geothermie-Vorhaben für Graz: Gemeinsam mit OMV und Energie Graz soll bis 2030 rund die Hälfte des Fernwärmebedarfs mit Tiefenwärme gedeckt werden – Investitionssumme: über 400 Mio. Euro. LH Mario Kunasek und Finanzlandesrat Willibald Ehrenhöfer sehen in der Energie Steiermark einen Schlüsselfaktor für Versorgungssicherheit und Standortqualität und sind erfreut, dass mit der avisierten Strompreissenkung eine merkliche Entlastung für die Kunden zu erwarten ist.

Christian Krainer, Vorstandsdirektor der ÖWG Wohnbau
Die ÖWG feiert heuer ihr 75-jähriges Bestehen und blickt auf zahlreiche Meilensteine zurück. Welche Weichenstellungen planen Sie in nächster Zeit?
Als Unternehmen mit einer Verpflichtung für die nächsten Generationen stehen wir für qualitätsvolles ökologisches Bauen zu sozial adäquaten Preisen. Durch die Kostendeckung der Gemeinnützigkeit gewährleisten wir nachhaltig günstige Mieten und leistbare Preise für Eigentumswohnungen.
Welche ökologischen Herausforderungen meinen Sie konkret?
Die ökologische Ausrichtung liegt insbesondere in der Nachverdichtung und dem bewusst sorgsamen Umgang mit Grund und Boden. ÖWG Wohnbau ist sowohl auf „Neubau“ als auch auf „Sanierung“ ausgerichtet. Wir investieren insbesondere in den energetischen Zustand unserer Objekte, um so die Betriebskosten für die Bewohner nachhaltig zu senken. Auch das Thema der Überhitzung von urbanen Räumen ist durch die Ausgestaltung von Neubauprojekten mit Bepflanzungen und Wassersicherstellungen am Grundstück wesentlich.
Die Leistbarkeit von Wohnen ist ein zentrales Thema, Welche Rolle sehen Sie in diesem Zusammenhang für die ÖWG?
In der Partnerschaft mit den ausführenden Professionisten ist es unsere vordringliche Aufgabe, die Errichtungskosten niedrig zu halten. Eigentumsbildung ist derzeit für junge Menschen sehr schwer möglich. In diesem Zusammenhang suchen wir nach Wegen und schaffen Bewusstsein, dass Eigentum für soziale Stabilität sorgt und insbesondere der Altersarmut vorbeugt.

Fazitgespräch
Von Johannes Roth und Johannes Tandl mit Fotos von Jorj Konstantinov

In unsicheren Zeiten sind Versicherungen besonders gefordert. Die Risiken steigen, die Regularien werden immer strenger und die Veranlagung der Kundengelder wird immer schwieriger. Wir haben Grawe-General Klaus Scheitegel gefragt, wie er die Lage beurteilt.

Die vergangenen Jahre mit ihren multiplen Krisen waren für Versicherer nicht leicht. Inflation, unsichere und sich verändernde Auslandsmärkte, ein schwieriges Veranlagungsumfeld – all das macht die Bilanzsaison von Finanzinstituten heuer noch einen Tick spannender als sonst.
Neben den Naturkatastrophen, die die Ergebnisse von Versicherungsunternehmen spürbar beeinflussen können, war es vor allem die Zinswende, die die Veranlagungsspezialisten herausforderte. Glücklich, wer sich hier auf eine Strategie verlassen kann, die in Jahrhunderten gewachsen ist. Die von Erzherzog Johann gegründete Grazer Wechselseitige Versicherung ist Paradebeispiel dafür, wie man sich durch konservative Veranlagungsstrategien auf der einen und innovativer Produktpolitik auf der anderen Seite als stabiler Partner positioniert. Dementsprechend fiel auch die Bilanz 2024 aus, in der sich zwar Naturkatastrophen widerspiegeln, die aber dennoch mit beeindruckenden Kennzahlen punkten kann.
Denn im Unterschied zu anderen Playern am Markt muss Grawe-Generaldirektor Klaus Scheitegel sein Ergebnis nicht bloß im Hinblick auf laufende Vorstandsperioden bewerten, sondern auch danach, ob die Grazer Wechselseitige Versicherung auch in 50 Jahren noch dieselbe Stabilität und Sicherheit verspricht, wie sie es seit bald 200 Jahren tut.

Wir kaufen Immobilien nur dann, wenn sie zu unserer Veranlagungsstrategie passen.
Klaus Scheitegel
Herr Generaldirektor, aus der Bilanz 2024 geht hervor, dass die Grawe sich hervorragend entwickelt hat. Die Zahlen sind beeindruckend – insbesondere beim Prämienvolumen. Gleichzeitig ist das Vorsteuerergebnis in Österreich zurückgegangen. Warum? Das ist das Geschäft des Versicherers. Der Ergebnisrückgang erklärt sich vor allem aus zwei großen Unwetterereignissen. Das eine war im Juni in der Steiermark – betroffen waren Übelbach, Deutschfeistritz, Sankt Radegund, teilweise sogar bis Hartberg. Das zweite war das Hochwasser in Niederösterreich im September. Insgesamt sprechen wir von rund 36,4 Millionen Euro Schadenaufwand für diese zwei Ereignisse. Alles in Allem sind unsere Schadenleistungen im Inland um 121 Millionen Euro auf 696,2 Millionen gestiegen. Das hat natürlich das EGT [Anmerkung: Ergebnis der gewöhnlichen Geschäftstätigkeit] beeinflusst – es sank um 14,8 Prozent auf 69,6 Millionen Euro.
Solche Schäden sind aber doch rückversichert, oder? Natürlich. Ohne Rückversicherung wäre unser EGT nicht nur um rund zehn Millionen Euro gesunken, sondern um fast 38 Millionen. Das zeigt, wie wichtig professionelles Risikomanagement ist. Dennoch bleibt die logistische Herausforderung. Innerhalb von ein paar Tagen mehrere tausend Schadensmeldungen abzuarbeiten, ist eine enorme Belastung.
Der Solvabilitätsgrad liegt trotzdem bei über 313 Prozent. Was sagt diese Zahl aus?
Sie zeigt, wie tragfähig unser Geschäftsmodell ist. Der Gesetzgeber verlangt 100 Prozent – wir liegen mehr als dreimal darüber. Das bedeutet, wir sind extrem robust aufgestellt und können auch große Schadenserien verkraften, ohne unsere Substanz anzugreifen. Es ist aber auch unsere Aufgabe, jederzeit leistungsfähig zu bleiben. Unsere Kundinnen und Kunden verlassen sich auf uns – sei es im Schadenfall oder bei langfristigen Vorsorgeprodukten. Das beginnt bei einem simplen Einbruchsschaden und endet bei einer Lebensversicherung mit jahrzehntelanger Laufzeit. Dafür braucht es finanzielle Stabilität.
Sie veranlagen enorme Vermögenswerte und das offenbar sehr erfolgreich. Was macht die Grawe im Hinblick auf ihre Veranlagungsstrategie anders als andere Versicherungsunternehmen?
Wir setzen auf Sicherheit. Ein guter Teil unserer Assets sind in Immobilien investiert. Der Rest in Staatsanleihen und festverzinsliche Wertpapiere. Spekulative Veranlagungen – wie Kryptowährungen oder riskantes Stock-Picking [Anmerkung: gezieltes Investieren in einzelne börsennotierte Unternehmen] – haben bei uns keinen Platz. Wir denken langfristig. Das müssen wir auch. Denken Sie an Lebensversicherungen, manche unserer Investitionsentscheidungen zielen auf einen Horizont von 30 Jahren und mehr.
Die Immobilienstrategie der Grawe gilt als legendär. Wie haben Sie diese so nachhaltig aufgebaut?
Wir verdanken vieles unseren Vorgängern. Einige unserer Gebäude stammen noch aus der Gründerzeit – etwa unser Hauptsitz von 1895. Viele dieser Häuser sind seit Jahrzehnten in unserem Besitz, sie wurden für uns errichtet. Das ist Teil unserer DNA. Und hoffentlich freuen sich auch unsere Kundinnen und Kunden darüber –denn letztlich ist es ihr Geld, mit dem wir wirtschaften. Wir kaufen Immobilien nur dann, wenn sie zu unserer Veranlagungsstrategie passen. Wenn sich ein Objekt nicht sinnvoll in unsere Verwaltungslogik einfügt oder die Rendite nicht passt, lassen wir die Finger davon. Einfach gesagt: Wir können, aber wir müssen nicht. Heuer haben wir zwei Häuser gekauft – beide haben perfekt zu uns gepasst. Eines lag direkt neben einem unserer bestehenden Objekte – das vereinfacht Verwaltung und Bewirtschaftung.
Konzentrieren Sie sich bei Immobilienkäufen auf Graz? Nicht nur. Wir investieren gezielt in Graz, Wien und anderen Landeshauptstädten – also dort, wo wir auch geschäftlich präsent sind und eigene Teams haben.
Es gibt Speckgürtel rund um Städte, in denen höhere Mieten erzielt werden als im Hauptort. Reizt Sie das nicht?
Nein. Das ist nicht unser Modell. Immobilien sind für uns Teil der Wertschöpfungskette – wir kaufen, bauen, verwalten. Ideal ist es, wenn ein Mieter bei uns wohnt und gleichzeitig Versicherungskunde ist. Das Zusammenspiel von Bank, Immobilien und Versicherung ist Teil unserer strategischen Ausrichtung. Aber wir verkaufen nichts. Wir kaufen auch nichts in der Hoffnung, es in fünf Jahren teurer weiterzugeben. So denken wir nicht.
Das heißt, eine Bilanzierung nach IFRS-Regeln (International Financial Reporting Standards, also internationale Rechnungslegungsvorschriften) bringt Ihnen keinen Vorteil?
Genau. Sie würde uns keinen Mehrwert für die Unternehmenssteuerung liefern. Aber wir bilanzieren ohnehin nach UGB [Anmerkung: Unternehmensgesetzbuch] – also bei Immobilien zum Anschaffungswert abzüglich der Abschreibungen.
Ist das der Grund, dass Banken in der Regel keine Immobilien besitzen, Sie als Versicherung jedoch schon?
Das Geschäftsmodell einer Bank unterscheidet sich grundlegend von dem einer Versicherung. Wir schließen beispielsweise heute Verträge mit 25- bis 30-jähriger Laufzeit ab. Wenn jemand mit 30 eine Zusatzpension für den 65. Geburtstag anspart, müssen wir heute schon sicherstellen, dass wir diese Zusage auch einhalten können. Deshalb müssen unsere Veranlagungen auf der Aktivseite extrem solide sein – belastbar, langfristig, mit verlässlicher Rendite. Wenn ich heute ein Zinshaus mit 3,5 oder 4 Prozent Rendite kaufe, dann muss das auch in zehn Jahren noch tragfähig sein.
Ist die Grawe eigentlich noch primär Versicherung oder nicht schon mehr eine Bank?

Wir sind eine Versicherung. Unser Spitzeninstitut ist die Grawe-Versicherung. Aber die Frage ist berechtigt. Wir gelten regulatorisch als Finanzkonglomerat. Das heißt, sowohl Bank als auch Versicherung müssen an die FMA berichten – und zusätzlich wir als Holding noch einmal konsolidiert alles.
Ein Vorteil – Sie kennen die Spielregeln beider Welten, also Basel und Solvency.
Genau. Und deshalb investieren wir gezielt in Beteiligungen, die zu uns passen – Banken, Immobilien, Versicherungen. Wir würden zum Beispiel nicht in den Tourismus einsteigen.
Aber es gibt Gerüchte über ein Interesse an der Energie Steiermark? Ich sage es so: Wir beobachten unser Umfeld. Konkretes gibt es derzeit aber nicht zu berichten.
Kommen wir zurück zu der Unterscheidung zwischen Bank und Versicherung. Wie hoch ist denn der Ergebnisanteil der Bankensparte im Vergleich zur Versicherungssparte?
In Österreich ist das Ergebnis der Bankengruppe etwa gleich hoch wie das österreichische Versicherungsergebnis. Dazu kommen dann aber noch die Ergebnisse unserer ausländischen Versicherungsgesellschaften. Also in Österreich Versicherung und Bank etwa 50 zu 50. Im Ausland rein Versicherung und Immobilien. So ist das Konzernergebnis von der Versicherung dominiert.
Es war ein sogenanntes »Window of Opportunity«. Wir hatten zu diesem Zeitpunkt bereits die Capital Bank im Konzern und wollten in Wien stärker Fuß fassen. Wien ist wirtschaftlich gesehen unverzichtbar – dort präsent zu sein, war strategisch wichtig. Die Schelhammer Capital ist die älteste Privatbank Österreichs, gegründet 1832. Sie hatte viel Potenzial, das wir heben konnten. Und der Verkäufer hatte offenbar ebenfalls den Eindruck, dass wir das gut können.
Wie geht es eigentlich Ihrer durchaus innovativen Direktbank, der Dadat-Bank?
Was unsere Leute in der Dadat machen, ist hochgeschätzt. Wir haben große Freude mit der Marke, weil sie neue Kundenschichten anspricht. Es gibt Kunden, die sind gleichzeitig bei der Bank Burgenland, der Grawe-Versicherung und bei der Dadat. Das passt gut zusammen – unterschiedliche Kundenbedürfnisse, ein Konzern. Das ist gelebte Diversifikation.
Sie haben vergangenes Jahr Bankfilialen in Kärnten übernommen?
Ja, genauer gesagt, unsere Konzerntochter, die Bank Burgenland, hat die ehemaligen Anadi-Bankfilialen übernommen. Manche haben uns gefragt, wer braucht heute noch eine Bankfiliale? Aber es gibt Kundenschichten, die genau das wollen. Das Leben ist bunt – manche brauchen persönliche Beratung, andere wollen alles digital. Die Dadat etwa ist eine reine On-
Hannes Schwarz Klubobmann



Apropos Schelhammer Bank. Die Bank hatte ja den Ruf einer Kirchenbank. Ist sie das immer noch?
Ja, das war ihr Image. Sie war die erste Bank mit einem Ethikbeirat. Gerade bei Fragen ethischer Veranlagung war sie Vorreiter. Heute würde man das unter ESG [Anmerkung: Environmental, Social und Governance, Rahmenwerk zur Bewertung der nachhaltigen und ethischen Praktiken von Unternehmen] zusammenfassen – also Nachhaltigkeit in der Geldanlage.
Sie haben sich also ESG eingekauft?
Wenn Sie so wollen, ja. Und wir haben ESG seitdem stark ausgebaut. Das verlangen ja auch die Regularien. Unser Geschäftsbericht 2024 hat in gedruckter Form 200 Seiten mehr als jener von 2023 – das ist dem ESG-Regularien geschuldet. Das Thema nimmt mittlerweile einen enormen Stellenwert ein.
Das muss ja auch einen enormen Aufwand bedeuten. Wer betreut das bei Ihnen?
Wir haben dafür eine eigene Stabsabteilung im CFO-Bereich. Der ESG-Bericht ist sehr granular. Sie finden darin etwa, wie viel Strom wir verbrauchen, wo wir investieren, wie viele Ausbildungstage unsere Mitarbeiter haben. Der Bericht wird übrigens auch von unseren Wirtschaftsprüfern kontrolliert.
Die Raika hat einen Bereich namens »Beyond Banking« geschaffen, in dem all diese Initiativen gebündelt sind. Planen Sie etwas Ähnliches? Die Frage ist immer, will man so etwas am Markt positionieren oder nicht? Wir haben eine Stabstelle für Nachhaltigkeit. Uns ist
klar, alles, was wir da tun, kostet. Und die Frage ist, ob die Kunden bereit sind, das mitzutragen. Governance und Compliance – da sind wir ganz vorne dabei. Aber vieles davon ist inzwischen auch gesetzlich verpflichtend.
Stichwort Governance. Ihr Vorstand ist rein männlich. Wie gehen Sie mit dem Thema Gendergerechtigkeit um?
Wir lassen uns da nicht in ein Korsett zwingen. Wir haben hervorragende Frauen im Haus, die in den nächsten Jahren den Schritt in den Vorstand machen könnten – und vermutlich auch werden. Die letzten Karriereschritte auf der zweiten Ebene waren fast ausschließlich Frauen. Das wird sich von selbst entwickeln.
Aber der Regulator erwartet das …
Die FMA [Anmerkung: Finanzmarktaufsicht] schaut vor allem auch auf das Thema »Fit & Proper«. Ich halte nichts davon, das zu einem Geschlechterkampf zu machen. Die Frage muss sein: Ist die Person geeignet? Und ja, ich bin überzeugt, dass die nächste Vorstandsfrau schon bei uns im Haus arbeitet. Auf Konzernebene haben wir ein sehr gutes Verhältnis. 50 Prozent unserer 80 Führungskräfte sind Frauen. In vielen Tochtergesellschaften – Bulgarien, Moldau, Kroatien – gibt es bereits weibliche Vorstände.
Lassen Sie uns noch einmal zu den Naturkatastrophen zurückkommen. Immer wieder wird eine verpflichtende Versicherungslösung diskutiert. Halten Sie so etwas für realistisch?
Im aktuellen Regierungsprogramm ist das Thema nicht explizit enthalten. Aber ich bin überzeugt, dass sich der Druck aus dem


Wenn es um einen Partner in Finanzfragen geht, dann ist es gut, wenn beide dieselbe Sprache sprechen. Als Bank mit starken lokalen Wurzeln fühlen wir uns den Menschen in unserer Region verpflichtet. Deshalb ist es uns wichtig, Sie bei der Verwirklichung Ihrer Ideen und Träume zu unterstützen.
BKS Bank AG, 8010 Graz, Kaiserfeldgasse 15, T: 0316/811 311-0, www.bks.at Unser Herz schlägt für Ihre Wünsche.
Klaus Scheitegel wuchs in Leoben auf und ging dort zur Schule. Der heute 58-jährige Generaldirektor der Grazer Wechselseitigen studierte von 1985 bis 1991 Rechtswissenschaften an der Karl-Franzens-Universität in Graz, wo er 1993 auch das Gerichtsjahr absolvierte, bevor er im selben Jahr in die Grawe eintrat. Ab 2007 war Scheitegel Vorstandsmitglied in der slowenischen Tochter der Gruppe, von 2013 bis 2015 war er Vorstandsmitglied der Grazer Wechselseitige Versicherung in Graz, bevor er sich zwei Jahre lang als Stellvertreter des Generaldirektors darauf vorbereitete, diese Position 2017 zu übernehmen. Scheitegel ist verheiratet und hat einen Sohn. Er managt eine Banken- und Versicherungsgruppe mit langer Tradition und hervorragenden Kennzahlen: 2024 lag der Gewinn der GRAWE AG vor Steuern (EGT) bei 69,6 Millionen Euro, per 31.12.2024 wies die GRAWE AG einen Solvabilitätsgrad (Solvency II) von 313,8 Prozent aus. Das EGT der GRAWE-Group betrug 195,7 Millionen Euro, die Gruppe beschäftigt rund 5.000 Mitarbeiterinnen und Mitarbeiter und betreut mehr als 2,65 Millionen Kundinnen und Kunden in 13 zentral-, ost- und südosteuropäischen Ländern.

In Österreich neigt man dazu, zu vergessen oder zu verdrängen. Das erschwert Reformen.
Klaus Scheitegel
europäischen Umfeld erhöhen wird. Deutschland etwa hat das Thema bereits im Koalitionsvertrag verankert, Italien hat für den Gewerbebereich eine verpflichtende Lösung umgesetzt, Slowenien arbeitet an einem Modell. Für uns wäre ein gemeinsamer Ansatz zwischen Erstversicherern, Rückversicherern und dem Staat ideal – zum Beispiel über eine staatliche Haftung. Damit könnte man den Katastrophenfonds entlasten.
Also würde der Katastrophenfonds integriert werden? Genau. Ziel wäre es, ein einheitliches System zu schaffen – mit einem klaren Rechtsanspruch für Betroffene. Die Mittel aus dem Katastrophenfonds würden dann dort mit einfließen. Wir waren nach dem Hochwasser in Niederösterreich eigentlich schon weiter. Aber in Österreich neigt man dazu, zu vergessen oder zu verdrängen. Das erschwert Reformen. Man muss auch immer zwischen Gewerbe- und Privatkunden unterscheiden. Für beide muss aber eine solche Versicherung wirtschaftlich darstellbar sein – und das gelingt nur, wenn alle mitmachen. Es braucht also einen solidarischen Ansatz. Hochwasser trifft vielleicht das Tullner Feld, Lawinen Tirol und Muren das Bergland. Man kann nicht sagen, Pech, dass du dort wohnst. Solidarität ist das Grundprinzip von Versicherung.
Aber wie verhindert man, dass sich dann niemand mehr um Eigenvorsorge beim Bauen kümmert?
Das ist einer der zentralen Punkte. Wir dürfen keine Fehlanreize schaffen. Deshalb haben wir vorgeschlagen, die Naturkatastrophenversicherung als Baustein der Feuerversicherung zu integrieren. Fast alle Gebäude in Österreich sind gegen Feuer versichert. Würde man dort den Elementarschutz einbinden, hätten wir eine faktische Pflicht, nicht jedoch juristisch.
Halten Sie eine Pflegepflichtversicherung für notwendig?
Ein heikles Thema. Wir sind im Pflegebereich derzeit nicht aktiv, sondern konzentrieren uns auf finanzielle Vorsorge und Krankenversicherung. Klar ist, dass wir die Menschen länger im Erwerbsleben halten müssen – das betrifft auch das Pensionsantrittsalter. Und wir müssen dafür sorgen, dass sie länger gesund bleiben. Denn die klassische Großfamilie, wo jemand zu Hause betreut wurde, gibt es immer seltener. Die Pflegebelastung wächst.
Können Produkte wie »MyMed« dabei helfen? Ja, wenn man früh genug einsteigt. Je jünger man eine Krankenversicherung abschließt, desto günstiger ist sie. In höherem Alter wird sie oft unverhältnismäßig teuer. Und man muss wissen, die
teuersten Lebensjahre aus Sicht der Krankenversicherung sind die letzten zwei.
Wie läuft denn Ihre neue Gesundheitssparte? Die ist ja nun ziemlich genau ein Jahr am Markt, vor der Haustüre haben Sie starken Mitbewerb in diesem Segment.
»MyMed« läuft sehr gut. Wir haben im ersten Jahr über 5.700 Kunden gewonnen – das ist deutlich über Plan. Unser Ziel ist es, uns langfristig im Gesundheitsbereich zu positionieren. Interessant ist auch, dass »MyMed« das erste Produkt ist, das bei uns zu 100 Prozent digital läuft – von der Antragstellung bis zur Leistungsabrechnung.
Andere Versicherer – wie die Merkur – sind hier über die Betriebsräte aber deutlich präsenter am Markt.
Die Merkur ist seit über 200 Jahren rein auf Krankenversicherung spezialisiert und daher weit voraus. Sie ist der zweitgrößte Anbieter in Österreich. Wir haben da noch viel Potenzial. Aber mit MyMed setzen wir einen ersten, wichtigen Schritt.
Wie ist eigentlich Ihre Digitalisierungsstrategie und wie gehen Sie mit dem heiklen Thema KI um?
Unser Ziel ist nicht, möglichst viele Leute durch Technik zu ersetzen, sondern die Arbeit sinnvoller und erfüllender zu machen. In der Krankenversicherung etwa funktioniert vieles automatisch –der Kunde scannt seine Rechnung, das System löst die Zahlung aus. Aber wir wollen, dass unsere Mitarbeiterinnen und Mitarbeiter Freude an ihrer Arbeit haben. Und dazu gehört persönliche Kommunikation.
Wie entwickelt sich der Vertrieb aktuell? Wird der Maklervertrieb stärker?
Ja, deutlich. Vor allem im Gewerbebereich ist der Makler inzwischen dominierend. Der Eigenvertrieb ist stärker im Privat- und Landwirtschaftsbereich. Ausschließlichkeitsagenten gibt es kaum noch – wir arbeiten fast nur mit angestelltem Vertrieb und Maklern.
Die Kooperation mit der Merkur im Partnervertrieb ist beendet? Richtig. Diese Vereinbarung gibt es nicht mehr. Aber ich betone, mit der Merkur haben wir ein anständiges, korrektes Verhältnis. Wir sind zwei große steirische Unternehmen – da gibt es viele Berührungspunkte.
Herr Scheitegel, vielen Dank für das Gespräch.

Trinkgelder sind von der Einkommensteuer ausgenommen, wenn sie in ortsüblicher Höhe und ohne Rechtsanspruch für den Dienstnehmer gewährt werden. Des Fiskus Begehren setzt allerdings bei der Umsatzsteuer an. Zwar nicht beim Arbeitnehmer, da dieser nicht unternehmerisch tätig ist und sein Trinkgeld daher keiner Umsatzsteuer unterliegt. Diese Beurteilung gilt auch dann, wenn der Arbeitgeber zunächst das Trinkgeld kassiert und dann an die Arbeitnehmer weitergibt. Der vom Unternehmer in Rechnung gestellte Bedienungszuschlag zählt hingegen immer zur USt-Bemessungsgrundlage, auch wenn er zur Gänze an die Arbeitnehmer weitergeleitet wird. Empfängt der Unternehmer Trinkgelder und gibt sie nicht an die Arbeitnehmer weiter, oder erhält er selbst die Trinkgelder, sind diese als zusätzliches bzw. freiwilliges Entgelt seitens der Kunden grundsätzlich umsatzsteuerpflichtig. Trinkgelder zählen außerdem zur Sozialversicherungsbeitragsgrundlage und sind somit beitragspflichtig. Aus Gründen der Praktikabilität sind die Versicherungsträger ermächtigt, die Höhe der zu berücksichtigenden Trinkgelder auch pauschal anzunehmen. Betroffen sind Beschäftigte in Branchen, in denen es üblicherweise zur Leistung von Trinkgeldern kommt. Die Folge davon ist, dass es für jede Branche je nach Bundesland unterschiedlich hohe Trinkgeldpauschalen gibt. So viel zur Verwaltungsvereinfachung, meint Ihr …

Teure Energie, hohe Lohnkosten, lähmende Bürokratie: Österreichs Wirtschaft kämpft mit strukturellen Problemen, die längst nicht mehr nur theoretisch sind. Die Folgen sind konkret messbar – und alarmierend. Die heimische Industrie befindet sich im dritten Rezessionsjahr, Unternehmensinsolvenzen steigen massiv, Investitionen wandern ins Ausland ab.
Sowohl aktuelle Studien als auch Stimmen aus der Praxis machen deutlich: Der Standort steht unter Druck, und das Zeitfenster für wirksame Gegenmaßnahmen schließt sich rapide. Wie tief die Krise bereits greift, zeigen aktuelle Daten der Creditreform. Allein im Bereich Sachgütererzeugung stiegen die Unternehmenspleiten im Vorjahr um 42 Prozent. Der Rückgang der Wettbewerbsfähigkeit ist dabei kein Naturereignis, sondern hausgemacht. Österreich wurde im internationalen Competitiveness Report des
IMD in den letzten fünf Jahren von Platz 16 auf Platz 26 durchgereicht. Im europäischen Vergleich liegt die Alpenrepublik nur noch auf Rang 12 – mit zunehmendem Abstand zu den Top-Ländern wie Schweiz, Dänemark und Irland.
Standortfaktoren unter Druck – Bürokratie, Steuern, Arbeitsmarkt Harald Breit, CEO von Deloitte Österreich, warnt vor einer Bruchlandung: „Wir brauchen eine Trendumkehr. Österreich muss vom Sinkflug wieder in den
Steigflug kommen, sonst drohen schwerwiegende Folgen für Wohlstand und sozialen Zusammenhalt.“ Die von Deloitte im Rahmen einer Sondererhebung befragten Top-Führungskräfte sehen dringenden Reformbedarf –nicht nur in Steuersystem und Verwaltung, sondern auch beim Arbeitsmarkt, der Infrastruktur und der Innovationskraft. Die überbordende Bürokratie gilt unter den befragten Unternehmen als größtes Hemmnis: 63 % vergeben dafür die Noten „Nicht genügend“ oder „Genügend“. Bei der Einkommensbesteuerung sind es 59 %, beim Wirtschaftswachstum 61 %. Auch die Staatsverschuldung macht vielen Sorgen – nicht nur wegen ihrer Höhe, sondern wegen der fehlenden Perspektive für eine nachhaltige Konsolidierung.
Ökonomin Monika Köppl-Turyna, Direktorin des Thinktanks EcoAustria, bringt es auf den Punkt: „Kurzarbeit oder Strompreisbremsen sind kein Ersatz für echte Standortpolitik.“ Statt temporärer Hilfen brauche es eine Reformoffensive, die strukturelle Schwächen adressiert – etwa durch den Abbau von Abgaben, schnellere Genehmigungsverfahren und Investitionen in Bildung, Digitalisierung und Netzinfrastruktur.
Reformideen gibt es – nur der politische Wille fehlt Tatsächlich zeigt der Blick ins Ausland, wie es besser geht. Dänemark etwa punktet mit seinem Flexicurity-Modell, das flexible Beschäftigung mit sozialer Absicherung kombiniert. Die Schweiz setzt mit gezielter Jobvermittlung
auf Effizienz, während die Niederlande internationale Fachkräfte durch smarte Visaregelungen anziehen. Österreich hingegen leidet unter Fachkräftemangel, einem unflexiblen Arbeitsmarkt und unzureichender Qualifizierung.
Auch beim Thema Zukunftsinvestitionen hinkt die Republik hinterher. Digitalisierung, Künstliche Intelligenz und Big Data gelten als Schlüsselbereiche – dennoch bewerten zwei Drittel der Führungskräfte diese Faktoren als höchstens mittelmäßig. Dabei wäre genau hier das Potenzial, den Turnaround zu schaffen. Schweden etwa zeigt mit der staatlichen Plattform „AI Sweden“, wie Innovation zur Triebfeder des wirtschaftlichen Aufschwungs werden kann.
Das Vertrauen in die Politik schwindet jedoch – nicht nur wegen fehlender Taten, sondern auch aufgrund symbolpolitischer Maßnahmen wie überzogenen Pensionsanpassungen oder wenig zielgerichteten Subventionen. „Es braucht Mut zur Veränderung“, mahnt Köppl-Turyna. „Nicht ein Herumschrauben an Details, sondern ein echter Befreiungsschlag.“
Handeln – bevor es zu spät ist
Der Wirtschaftsstandort Österreich steht an einem Wendepunkt. Ohne echte Strukturreformen droht der dauerhafte Abstieg. Doch mit klaren politischen Signalen, mutigen Maßnahmen und Orientierung an erfolgreichen internationalen Vorbildern könnte der Sinkflug noch gestoppt werden. Die Zeit dafür läuft – jetzt.

Die RLB-Steiermark-Vorstände Rainer Stelzer, Ariane Pfleger, Gen.-Dir. Martin Schaller und Florian Stryeck blicken auf ein operativ erfolgreiches Jahr 2024 zurück und wähnen die Wirtschaft in der Talsohle der aktuellen Krise.
überwiegt Sparkasse präsentiert Rekordzahlen
Die Raiffeisenlandesbank (RLB) Steiermark spürt die Auswirkungen der Russland-Risiken der Raiffeisen Bank International (RBI) deutlich in ihrer Konzernbilanz: Das Ergebnis nach IFRS fiel 2024 um rund zwei Drittel auf 116,5 Millionen Euro. Ursache ist eine hohe Wertberichtigung auf die RBI-Beteiligung, die sich in der RLB-Bilanz niederschlägt. Doch im operativen Geschäft sieht man sich gut aufgestellt.
Wir sprechen von einem sehr ordentlichen Ergebnis in einem schwierigen Umfeld“, sagt RLB-Vorstandschef Martin Schaller. Die Bilanzsumme blieb mit 16,9 Milliarden Euro stabil, die harte Kernkapitalquote erhöhte sich leicht auf 22,3 Prozent – doppelt so hoch wie gesetzlich gefordert. Das Betriebsergebnis nach UGB sank vor allem zinsbedingt von 662 auf 595 Millionen Euro. Trotz rezessionsbedingter Investitionszurückhaltung konnten im
Vorjahr Neukredite über 2,6 Milliarden Euro vergeben werden. Das von Raiffeisen Steiermark verwaltete Kundengesamtvolumen – Kredite, Einlagen, Veranlagungen – stieg um 2,4 Prozent auf rund 54 Milliarden Euro. Das Kundenvermögen legte um 5,2 Prozent auf 29,5 Milliarden zu, insbesondere das Depotvolumen wuchs um über zehn Prozent.
Optimismus herrscht beim Thema Wohnbaufinanzierung. Die RLB rechnet mit sinkenden Zinsen – zwei EZB-Senkungen erwartet Schaller bis Jahresende – und einer Belebung der Nachfrage. Auch das Auslaufen der strengen KIM-Verordnung dürfte der Kreditvergabe Auftrieb verleihen. Schaller warnt allerdings vor einer „Schatten-KIM“ – also internen Kriterien, die weiterhin gelten dürften. Aufmerksam beobachtet die Bank den Anstieg notleidender Kredite, deren Anteil von 2,75 auf 3,69 Prozent stieg – vorrangig getrieben durch Herausforderungen in Bau, Immobilien und Handel. Laut Risikovorstand Florian Stryeck seien 97,5 Prozent der Kredite entweder besichert oder bilanziell abgesichert. Bei privaten Kunden seien Ausfälle nach wie vor marginal.
Die Zahl der Kunden steigt weiter: Exakt 760.644 Steirerinnen und Steirer sowie über 71.000 Unternehmen haben eine Geschäftsbeziehung mit der Bankengruppe, die aktuell aus der RLB und 40 regionalen Raiffeisenbanken mit 254 Standorten besteht – 65 davon SB-Filialen. Trotz zunehmender Digitalisierung wächst der Personalstand leicht: 3.448 Beschäftigte zählt Raiffeisen Steiermark, rund 100 mehr als im Vorjahr. Laut Personalvorständin Ariane Pfleger sei der Bedarf durch neue regulatorische Anforderungen sowie altersbedingte Abgänge begründet.
Im heurigen Jahr fusionieren zudem die Raiffeisenbanken Deutschlandsberg und Voitsberg – der neue Hauptsitz wird Voitsberg sein. Der formale Fusionsbeschluss steht allerdings noch aus. Für den weiteren Jahresverlauf zeigt sich Schaller vorsichtig zuversichtlich: „Ein zaghaftes Licht ist sichtbar. Wir kommen langsam aus der Talsohle heraus – doch wir brauchen Konjunkturbooster und ein Regulierungs-Sabbatical.“

Die jüngste Konjunkturumfrage unter Kärntner Industrieunternehmen zeigt, dass sie von einer leichten Verbesserung der wirtschaftlichen Entwicklung ausgehen. Wenn der Standort wettbewerbsfähig bleiben soll, brauche es dringend Lohnneben- und Energiekostensenkungen, strukturelle Reformen und Bürokratieabbau. Im Strategiepapier der IV Kärnten finden sich die Handlungsempfehlungen in Bezug auf den Standort. „Von einem Aufschwung sind wir noch immer weit entfernt“, sagt Claudia Mischensky, GF der IV Kärnten. Etwas positiver als noch im Jänner laute die Einschätzung der Unternehmen in Bezug auf die Beschäftigten. Im Jänner war noch mehr als die Hälfte aller Industriebetriebe in Kärnten davon ausgegangen, Mitarbeiter abbauen zu müssen.

Der Vorstand der Hypo Vorarlberg: v.l: Philipp Hämmerle, Michel Haller (Vorstandsvorsitzender), Stephan Sausgruber (im Vorstand ab 1, 5. 2025) und Wilfried Amann (im Vorstand bis 30.4.2025)
Trotz der anhaltenden Rezession und einer schwächelnden Konjunktur in Österreich konnte die Hypo Vorarlberg im Geschäftsjahr 2024 ein solides Ergebnis erwirtschaften. Der Konzern erzielte ein IFRS-Ergebnis vor Steuern von 58,1 Mio. Euro (2023: 53 Mio. Euro).
Wir sind als Bank ein Gradmesser der Wirtschaft – und diese war 2024 stark gefordert“, erklärt Vorstandsvorsitzender Michel Haller. Besonders die Unternehmensbonitäten litten unter der angespannten Lage, was zu Risikovorsorgen in Höhe von 66 Mio. Euro führte.
Im Privatkundenbereich blieben die Risiken bislang gering. Allerdings belastete die KIM-Verordnung das Neugeschäft mit Wohnbaufinanzierungen erheblich. Insgesamt sank die Bilanzsumme leicht auf 15,3 Mrd. Euro. Positive Impulse kamen hingegen aus dem Wertpapiergeschäft: Die „Assets under Management“ stiegen auf 1,1 Mrd. Euro.
Die Hypo Vorarlberg investierte weiter in Personal und IT, was sich im gestiegenen Verwaltungsaufwand widerspiegelt. Dennoch konnte die Bank ihre stabile Eigenmittelausstattung weiter ausbauen. Mit einer Kernkapitalquote von 16,21 % sieht man sich gut aufgestellt. Für 2025 rechnet der Vorstand mit anhaltenden Unsicherheiten, sieht sich mit ihrer breit aufgestellten Strategie aber weiterhin als verlässlicher Partner für Kunden und Unternehmen in der Region.

Schutz vor Kellerüberflutung: (v.l.) Grawe-Gruppenleiter
Rene Peter Peheim, ZT-Kammer-Präs. Gustav Spener, LR.in Simone Schmiedbauer, GSA-Obfrau Sabine Haßler und stv. GSA-Obmann Stephan Schrotter
Ein Rückstau von Abwasser im Kanalnetz kann verheerende Folgen haben. Hausbesitzer sollten daher im Eigeninteresse ihre Keller vor Überflutung schützen.
Die Gemeinschaft Steirischer Abwasserentsorger (GSA) startet gemeinsam mit dem Land Steiermark, der ZT-Kammer, der Grawe sowie mit Städte- und Gemeindebund eine Informationsoffensive, um die Bevölkerung umfassend zu informieren. Das Hauptaugenmerk liegt auf der direkten Information über Info-Kanäle der Gemeinden, regionale Abwasserverbände sowie die beteiligten Partner.
Landesrätin Simone Schmiedbauer erklärt: „Wir unterstützen die Gemeinden mit Infrastrukturmaßnahmen – aber auch die Eigenverantwortung aller Steirerinnen und Steirer ist entscheidend, um Überflutungen wirksam zu verhindern. Wer seinen Keller nicht gegen Rückstau sichert, riskiert teure Schäden.“
Sicherung durch technische Systeme
Bedingt durch den Klimawandel nehmen Starkregenereignisse zu und führen sehr oft zu Überlastungen des Kanalsystems. Durch große Wassermassen in so kurzer Zeit kommt es leicht zu Rückstau in der Kanalisation. Sind Gebäude nur ungenügend gegen diesen Rückstau gesichert oder vorhandene Rückstausicherungen nicht funktionsfähig, dringt das Wasser über WC, Waschbecken, Waschmaschinen oder Gullys in tiefer liegende Wohn- oder Kellerräume ein und führt oft zu großen Sachschäden an Heizsystemen, elektrischen Anlagen, Haustechnik etc.
Sabine Haßler, Obfrau der Gemeinschaft Steirischer Abwasserentsorger: „Überflutete Keller sind kein Einzelfall – Schutz beginnt mit Information. Wer sein Zuhause rechtzeitig sichert, schützt nicht nur sein Eigentum, sondern auch Lebensqualität.“ Alle Räume, die unter der Rückstauebene liegen (Straßenoberkante plus 15 cm), müssen gegen eindringendes Abwasser aus dem Kanal mit einer Rückstausicherung geschützt werden.
Infos unter: www.denkklobal.at
Der SPAR-Supermarkt in der Grazer
Kapellenstraße bekam vor kurzem die begehrte SPAR-interne Auszeichnung „Goldene Tanne“ verliehen. Diese Trophäe wird jährlich an die besten Spar-Standorte Österreichs vergeben.
Die erfahrene Marktleiterin Claudia Kriegl und ihre Stellvertreterin Monika Meitz sorgen mit ihrem 21-köpfigen Team mit viel Fachkompetenz und ausgeprägtem Servicegedanken vor Ort für ein kundenorientiertes Einkaufserlebnis.
Auszeichnung für Spitzenleistung
Die Entscheidung der Jury basierte auf einer Vielzahl von verschiedenen Kriterien, um die Auswahl aus den besten SPARMärkte in der Steiermark zu treffen. Neben der hervorragenden Warenpräsentation überzeugte der SPAR-Supermarkt in der Grazer Kapellenstraße durch hohe Kompetenz in den Bereichen Frische und Feinkost sowie durch herausragende Freundlichkeit und fachlicher Kompetenz des gesamten Teams. Auch die Umsatzsteigerung im Vergleich zum Vorjahr spielte bei der Bewertung eine große Rolle.
Große Freude über „Goldene Tanne“
„Wenn man für seine Leistung belohnt und in feierlichem Rahmen geehrt wird, dann ist das ein unglaubliches Erlebnis. Ich kann mich glücklich schätzen, ein so tolles Team zu haben, und wirklich alle unsere Mitarbeiter und Mitarbeiterinnen haben sich sehr über die Auszeichnung gefreut. Eine Bestätigung und Ansporn zugleich“, so Marktleiterin Claudia Kriegl.

Claudia Kriegl, Marktleiterin des SPAR-Supermarktes in der Grazer Kapellenstraße, freut sich mit ihrem gesamten Verkaufsteam über die Auszeichnung.

Mit rund 200 Teilnehmern aus Wirtschaft, Forschung und Politik fand am 23. und 24. April das das neue Format „Transform Energy – Forum EnergieZukunft 2025“ in Weiz und Gleisdorf statt. Organisiert von der Energie-Zukunft Weizplus, rückte die Veranstaltung zentrale Zukunftsfragen in den Fokus: Wie werden Energiegemeinschaften zu sektorübergreifenden, flexiblen und sozial gerechten Modellen, die lokale Energiesysteme stärken? „Erneuerbare-Energie-Gemeinschaften sind vor allem ein regionales und gesellschaftliches Projekt. Sie bieten die Chance, die Energiewende regional zu gestalten, mit Beteiligung aller – kostengünstig, solidarisch und erneuerbar,“ betont Rafael Bramreiter, Vorstand der Energie-Zukunft Weizplus.

Der Wildpark Mautern verfügt zwar nur über einen kleinen Streichelzoo, die Streicheleinheiten durch den Landesrechnungshof (LRH) erstrecken sich jedoch auf den gesamten Betrieb, der seit rund zehn Jahren unter dem Titel „Der Wilde Berg Mautern“ firmiert. Denn der jüngste LRH-Bericht spart nicht mit Lob an diesem Freizeitbetrieb im oberen Murtal, der Ende 2014 direkt vom Land Steiermark übernommen wurde und seither von der PlanaiHochwurzen-Bahnen GmbH als Management-Partnerin geführt wird. Da der aktuelle Bestandvertrag für das Areal des Wildparks im Jahr 2027, also in zwei Jahren, ausläuft, empfiehlt der LRH einige Anpassungen für die angestrebte Verlängerung dieses Vertrages mit dem Eigentümer der Liegenschaft.

Am 15. Mai 2025 feierte die Steiermärkische Sparkasse ihr 200-jähriges Jubiläum. Höhepunkt der Jubiläumswoche war der Festakt mit Jubiläumskonzert am Vorabend des Geburtstags. Mit Kunden und Gästen wurde auf das Jubiläum der angestoßen. Recreation –Das Orchester, langjähriger Kulturpartner der Steiermärkischen Sparkasse, gratuliert dabei mit Rachmaninows 3. Klavierkonzert. „Unser Morgen braucht auch eine lebendige Kulturszene, die uns begeistert, ermutigt und Orientierung gibt. Es ist das Wesen der Steiermärkischen Sparkasse, Partner wie Recreation zu unterstützen und die Region zu stärken. Dieses gesellschaftliche Engagement werden wir auch künftig mit Stolz und Überzeugung fortsetzen“, erklärte Vorstand Gerhard Fabisch.

(v.l.n.r.) BKS-Filialleiter Deutschlandsberg Joseph Albrecher, Manfred Geiger – Leiter der BKS Bank-Direktion Steiermark, SFG-GF Christoph Ludwig, KWFVorstand Roland Waldner, Diethmar Wölle – Leiter der BKS Bank-Direktion Kärnten und BKS-Filialleiter Wolfsberg Karlheinz Schwaiger
Als regionaler Bankpartner ist die BKS Bank seit Jahrzehnten auf beiden Seiten des Koralmtunnels zu Hause. Eine Diskussion über die noch bessere Nutzung der Chancen aus dem Bau der Koralmbahn führte die BKS Bank-Direktionen Steiermark und Kärnten sowie Kärntner Unternehmen und Stakeholder am 8. Mai zusammen.
In der Steinhalle in Lannach konnten mehr als 100 interessierte Kunden sowie Partner aus Wirtschaft und Politik von Manfred Geiger, Leiter der BKS-Bank-Direktion Steiermark, und Diethmar Wölle, Leiter der BKS-BankDirektion Kärnten, begrüßt werden. Vorgestellt wurde das Projekt Koralmbahn von Jürgen Egger, Gesamtkoordinator der ÖBB. Moderatorin Ute Pichler führte durch den Abend und die beiden Podiumsdiskussionen, welche die langfristige Wirkung der Bahnstrecke diskutierten. Die große Bedeutung für den Wirtschaftsraum wurde auch vom steirischen Wirtschafts-LR Willibald Ehrenhöfer unterstrichen.
Chance Metropolregion
Im Anschluss an die informative Keynote von Seiten der ÖBB wurde in zwei Podiumsdiskussionen die neue Area Süd aus unterschiedlichen Perspektiven be-
leuchtet. In Teil eins wurde das Jahrhundertprojekt mit den Wirtschaftsdelegierten Bettina Trojer, Christian Lassnig, Thomas Eduard, Wolfgang Spazier und ICS-GF Karl Hartleb aus der Sicht unserer Nachbarländer betrachtet. Teil zwei widmete sich den daraus entstehenden Chancen und Strategien heimischer Unternehmen. „Neben der Verkürzung der Fahrzeit zwischen Klagenfurt und Graz auf nur 45 Minuten schafft die Koralmbahn eine Metropolregion mit gut einer Million Menschen, 155.000 Unternehmen und 770.000 Beschäftigten. Damit entsteht der zweitgrößte Ballungsund Wirtschaftsraum Österreichs und einer der größten im deutschsprachigen Raum, und damit wird einem die internationale Bedeutung dieses Jahrhundertprojektes erst so richtig bewusst“, so Nikolaus Juhász, Vorstandsvorsitzender der BKS Bank, der sich per Videobotschaft zu Wort meldete.

Heilthermen Resort Bad Waltersdorf
Die Heiltherme Waltersdorf feiert heuer ihren 40. Geburtstag, was sind die Höhepunkte und Angebote zu diesem Anlass?
Wir feiern 40 Jahre Heiltherme Bad Waltersdorf – ein Jubiläum, das wir mit besonderen Wohlfühlangeboten, exklusiven Aktionen und kleinen Überraschungen das ganze Jahr über begehen. In den letzten Jahren haben wir zudem kräftig investiert und damit erneut Trends gesetzt – von neuen Wohlfühlwelten mit unserer Hoteltherme bis zu modernen Rückzugsorten in den neuen Zimmern und Suiten, die echten Mehrwert für unsere Gäste schaffen.
Was ist den Thermengästen heutzutage beim Aufenthalt in einem Resort besonders wichtig?
Unsere Gäste suchen nach echter Erholung, Naturerlebnissen und persönlichem Service. Sie schätzen die Balance aus wohltuendem Thermalwasser, sanften Anwendungen und der umliegenden Natur, die unser Resort umgibt. Hier können Körper und Geist wieder in Einklang kommen – fernab von Hektik und Stress.
Inwiefern ist die Therme in das touristische Angebot der Region eingebettet?
Das Heilthermen Resort Bad Waltersdorf, als touristischer Leitbetrieb des Thermen- und Vulkanland Steiermark, ist regional stark verankert. Umgeben von sanften Hügeln, regionalen Genussbetrieben und blühender Natur, bietet es Gästen vielfältige Möglichkeiten zur Erholung und zum Entdecken der Region. Sie lädt zum Radfahren, Wandern und Golfen ein. Wir arbeiten eng mit regionalen Partnern zusammen, um unseren Gästen echte Genussmomente zu bieten.
Von Peter Sichrovsky

Jedem Menschen steht eine Meinung zu. Ihm diese abzusprechen, bedeutet, ihm einen Teil seiner Freiheit zu nehmen, ihn in Unfreiheit zurückzulassen. Jedem Menschen steht es auch zu, sich über Tatsachen zu informieren, die seine Meinung beeinflussen könnten. Es ist auch der umgekehrte Weg möglich. Die Suche nach Tatsachen, bevor man sich eine Meinung bildet. Derzeit wird viel über das Budget gesprochen, vor allem über Einsparungen. Da ließ zum Beispiel das Bundeskanzleramt verlautbaren, dass bei der Reinigung gespart werde. Zum Thema Einsparungen hat das Justizministerium verlautbart, dass die Gerichtsgebühren erhöht werden. Das Außenministerium will weniger Dienstfahrzeuge anschaffen. Der Finanzminister hielt eine schnell gesprochene, dennoch endlos lange Rede über Einsparungen. Weniger Geld soll ausgegeben werden. Betroffen sind Bevölkerungsgruppen, die keine Lobby haben, sich nicht als Kollektiv wehren können, wie Familien, Pensionisten, und Pass und Führerschein werden teurer. Nicht ein Wort des Finanzministers über
die katastrophale Wirtschaftslage. Parallel zum Sparen fehlen Ideen und Konzepte, wie man mehr einnehmen und die Arbeitslosigkeit reduzieren könnte. Weniger Geld zahlen ist einfacher, als mehr Geld zu verdienen. Für das eine genügt der rote Stift, für das andere sind Idee und Strategien notwendig. Eine Familie, in der einer der Eltern den Job verliert, kann sehr schnell das Familienbudget reduzieren, indem zum Beispiel die Urlaube gestrichen werden. Einen neuen Job zu finden, auf der Einnahmenseite einzugreifen, ist schon wesentlich schwieriger. Warum weicht die Regierung dem Problem der Optimierung der Einnahmen aus? Vielleicht, weil die Lage noch hoffnungsloser ist, als es mit simpler Meinung kommuniziert werden könnte? Hier ein paar Tatsachen, um die Dramatik zu verdeutlichen:
Das Consulting Unternehmen »AT Kearney« veröffentlicht jedes Jahr ein Ranking für Auslandsinvestitionen, den FDI (Foreign Investment Index). Österreich scheint in der Liste nicht auf. Unter den Top 25 Ländern sind UK, Deutschland, Frankreich, Italien, Spanien, Schweiz, Schweden, Portugal, Norwegen, Belgien – zehn westeuropäische Länder. Die drei wichtigsten Kriterien (an denen Österreich scheitert) sind die hohe Steuerbelastung, eine komplizierte Bürokratie und fehlende Fachkräfte.
Der FDI-Intelligence-Index reiht nicht Länder, sondern Städte nach Potenzial für Investitionen internationaler Unternehmen. Drei Gruppen gibt es: Großstädte, mittelgroße Städte und Kleinstädte. In keiner der Gruppen ist eine Stadt aus Österreich zu finden. Der Wiener Bürgermeister hat als sensationelle Idee vor der Wahl angekündigt, den Verkehr aus dem 1. Bezirk zu verdammen. Um internationale Konzerne nach Wien zu holen, ist ihm nichts eingefallen. Hallstatt haben die Chinesen schon nachgebaut. Irgendwann werden sie einfach den 1. Bezirk nachbauen.
Der »Consumer Confidence Index«, das Vertrauen der Konsumenten in die Zukunft, fiel im April 2025 auf minus 21 Prozent. Positive Werte haben Tschechien, Italien, Frankreich, Schweden, Spanien und Irland. Der »Manufacturing Index PMI«
zeigt die Entwicklung der Produktivität. Werte unter 50 stehen für einen Rückgang. Der Wert für Österreich ist von März 2025 von 46,9 auf 46,6 im April gefallen. Polen hat 50,2, Israel 50,2, Griechenland 53,2, Schweden 54,2. Sogar der Wert von Russland mit 49,3 liegt über dem Wert von Österreich. Der Export österreichischer Waren ging zurück, in Dänemark stieg er. Im Ranking »BCI« (Business Confidence Index), dem Vertrauen der Industrie auf eine Besserung der Wirtschaftslage, ist Österreich nicht in den Top Ten zu finden, sehr wohl aber Dänemark, Schweden, Schweiz und Norwegen. Die Veröffentlichungen von wissenschaftlichen Arbeiten ging in den letzten zehn Jahren um über fünf Prozent zurück. Im »Innovation Index« nahm Österreich 2021 den 16. Platz ein, 2024 den 20. Platz. Und in Bezug auf die ewig diskutierte Pensionsreform haben uns andere europäische Länder längst abgehängt. Das Pensionsalter in zahlreichen Ländern Europas wurde und wird stufenweise angehoben. 2070 werden die Griechen mit 72,5 Jahren, Dänen mit 74 Jahren, Italiener mit 70 Jahren und die Schweden mit 70 Jahren in Pension gehen. Für Österreich fehlt jeder Plan. Jetzt warte ich auf die nächsten Reden des Finanzministers und Wirtschaftsminister. Vielleicht helfen den Beiden diese Zahlen bei der Meinungsbildung. n
Sie erreichen den Autor unter peter.sichrovsky@wmedia.at
Dear brother Leo! I hope you will allow me to call you brother. When I was a child, I was surprised every sunday when the priest called us »brothers and sisters« and I asked myself: Does he mean me too? What does he mean? Als Kind glaubte ich, dass Christus, wir haben ja denselben Namen, mein Bruder sei. Nach dem Abendgebet rückte ich zur Seite, damit er sich an den Rand meines Bettes setzen und mich trösten konnte. Als Du zum Oberhaupt der römisch-katholischen Kirche gewählt wurdest, begannen in Graz alle Kirchenglocken zu läuten. Ein Freund sandte mir ein Video vom Glockengeläut unserer Grazer Herz-Jesu-Kirche und teilte mir so seine große Freude mit. Es war ein schöner, wundersamer und unvergesslicher Tag. Auch ich freute mich und dachte, was für ein Heiliges Kirchenjahr 2025 und was für ein ereignisreicher Wonnemonat. Leise begann ich mein Lieblingslied zu singen: »Komm lieber Mai und mache die Bäume wieder grün und lass uns an dem Bache die Veilchen wieder blüh‘n.« Seit dem Tag setzen viele Menschen in Dich große Hoffnungen und Erwartungen. So auch ich, weil ich hoffe, dass das Wort Gottes durch Dich neues Gewicht erhält. Ich habe schon viele Kommentare in der Weltpresse und auch Briefe gelesen, in denen Dir alles Gute gewünscht wird und in welchen Bitten an Dich herangetragen werden. Als ich meinen Freunden und Freundinnen sagte, dass ich Dir einen Brief mit meinen Gedanken schreiben will, winkten sie ab – Du würdest meinen Brief nie zu Gesicht bekommen. We’ll see. So möchte ich Dir von meinem Glauben und Zweifel erzählen und auch hier zum Ausdruck bringen, wie ich die Lage des christlichen Glaubens und der katholischen Kirche vor allem in meiner Heimat sehe. Gegen das Unglück und die Schmerzen der Welt, den Wahnsinn des Krieges und die Ungerechtigkeit bei der Verteilung der Güter und die damit verbundene Entwürdigung der so Entrechteten, hatte Franziskus bis zu seinem letzten Atemzug seine Stimme erhoben. Caritas und Mitgefühl zeichneten sein Pontifikat aus und er hat viele Menschen der Kirche wieder näher gebracht. Aber trotzdem: die Zahl der Kirchenaustritte hat nicht abgenommen. Die immer wieder vorgebrachten, bekannten Kritikpunkte an der Kirche überschatten die große, ursprüngliche und befreiende Botschaft. In meinem Heimatland scheint der Glaubenskern immer mehr verloren gegangen zu sein und immer weniger Menschen orientieren sich am Christentum, da sie die religiösen Lehren nicht mehr verstehen, sie gar nicht mehr kennen oder weil sie ihnen fremd geworden sind. Dass sich das ändert, ist meine Hoffnung in Dich.
Vom kindlichen Glauben über den Zweifel zur Einsicht
Ich bin in Graz geboren, katholisch getauft und meine Muttersprache ist Deutsch. Ich erwähne meine Muttersprache ausdrücklich deshalb, weil ich zur Erkenntnis gekommen bin, dass mein Verständnis für das, woran ich glaubte und zweifelte, durch den »Vater der deutschen Sprache«, Martin Luther, geprägt wurde und begründet ist. Seine Zweifel wurden auch meine, ich aber konnte sie nicht durch die Annahme, dass der Glaube nur durch Gnade ermöglicht wird, auflösen. Während ich als Kind gutgläubig den Religionslehrern folgte und mir gern Wundergeschichten anhörte, entfernte ich mich als h eranwachsender, kritischer Jugendlicher immer mehr vom Glauben. Meine Gedanken standen im Widerspruch zu vielen Dogmen der Kirche. So habe ich erst spät durch die Philosophie und die Erkenntnistheorie großer Geister zu einem Weltbild gefunden, auf das ich bauen und vertrauen konnte und kann. Worte wie Metaphysik, Transzendenz, Absolution etc. erschwerten das Nachdenken über Gott und den Geist. Der Zweifel hat in deutschsprachigen Ländern eine lange Tradition, die mit der Übersetzung der Bibel durch Martin Luther begonnen hat. Er durchzieht die Philosophie, die Erkenntnistheorie und die Sprache selbst. Schon im ersten Satz der Genesis zeigt sich die ganze Schwierigkeit, die einen Übersetzer beschäftigen muss.
Nach den Essays über den Niedergang und die Wiederauferstehung des Christentums sowie über den Glauben in den USA nun dieser Brief nach Rom. An den neu gewählten Papst Leo XIV.

Christian Wabl, geboren 1948 in Graz, Studium der Kunst und Lehramt Deutsch an der Universität von Amsterdam sowie Studien in den Sprachwissenschaften, Hebräisch und Philosophie. Er ist Mitbegründer mehrerer Alternativschulen und arbeitete lange bildungspolitisch in der Grünen Akademie Steiermark.
Dear Brother Leo! Lieber Bruder Leo!
Was Grundlage des Glaubens ist, wird schon deshalb nicht erkannt, weil viele eben gar nicht mehr wissen, was geschrieben steht, welche Dogmen die Kirche gelehrt hat und welche für sie noch immer gültig sind.
Was können wir glauben?
Gott erschuf Himmel und Erde. Was ist der Himmel und was die Erde? Was bedeuten die sechs Tage? Hitzige Debatten werden auch heute noch geführt, wie der »Urknall« zu verstehen ist. Welche Bedeutung hat die Zeit, die mit einem solchen verbunden wird? Wird in der jüdischen Übersetzungen Gott nicht mit »Der Ewige« übersetzt? Und wer kann sich das Ewige denken? Zahllose Vorstellungen wurden mit dem Unaussprechlichen und seinen ihm zugeschriebenen Eigenschaften verknüpft, die zu Widersprüchen und schrecklichen Vorwürfen führten: Wie kann Gott Kriege zulassen? Steht der erste Satz der Genesis nicht überhaupt im Widerspruch zur Entstehungsgeschichte, wie sie im Prolog des Johannesevangeliums geschrieben steht?
Im Anfang war das Wort und das Wort war bei Gott und das Wort war Gott.
Erscheint es da nicht logischer, dass mit dem Wort (Logos) die große Erkenntnisgeschichte der Religion und des Menschen begann? Und im Weiteren im Buch der Bücher immer wieder die Untergänge und der Kampf um das, was wahr und falsch, gut und böse ist, beschrieben werden? Die Diskussionen über die Geschichte dieser Auf- und Untergänge befindet sich gegenwärtig in einem Erschöpfungszustand, in einer Phase der Orientierungslosigkeit, die schwer erträglich ist. Die vorherrschende Lebensweise steht in krassem Widerspruch zu den Glaubenssätzen und der Moral der Lehre Christi. Nach deren Lebensregeln können nur wenige Gemeinschaften bestehen, aber die Mehrheit der Menschen lebt zumindest im Westen allein. Allzu leicht wird in »konservativ« und »progressiv« eingeteilt und unterschieden. Was Grundlage des Glaubens ist, wird schon deshalb nicht erkannt, weil viele eben gar nicht mehr wissen, was geschrieben steht, welche Dogmen die Kirche gelehrt hat und welche für sie noch immer gültig sind. So habe ich als Kind zum Beispiel noch fest an die Hölle und das Fegefeuer nach dem Tod geglaubt. Mir hat das Angst gemacht und als Erwachsener empfinde ich das nur mehr unverständlich. Angst war überhaupt ein wesentlicher Bestandteil der religiösen Erziehung. Dass heute Menschen das Wort »Sünde« aus ihrem Sprachschatz verbannt haben, ist – in diesem Licht betrachtet – nicht verwunderlich. Heute wollen viele die Seele von Schuld und Sühne auf andere Weise befreien.
Sexualmoral, Unschuld und Befriedigung
Dazu, wie man schon früh und früher in die Liebe eingeweiht wurde, eine kleine Geschichte. Eine Frau erzählte mir, dass sie als kleines Mädchen wieder einmal zur Beichte gehen musste und sie dachte sich: »Warum soll ich immer dieselben Sünden beichten?« Und so ließ sie sich etwas Neues einfallen. Sie beichtete dem Pfarrer, dass sie Unkeuschheit getrieben hätte, worauf dieser verwundert fragte: »In Gedanken oder in Taten?« Nicht wissend, was der Unterschied sei, antwortete sie: »In Gedanken«, worauf der Pfarrer erleichtert seufzte und das Mädchen mit den Worten »das sei nicht so schlimm« zu beruhigen versuchte. Aber nicht nur solche Erfahrungen wie dieser Frau, haben zum Austritt geführt. Und: Wer weiß denn heute, was der Unterschied ist? Die bis in die Sechzigerjahre vertretene Sexuallehre, die im Verbot der Antibabypille in der Enzyklika »Humanae Vitae« durch Papst Paul VI. zum Ausdruck kam, war für viele auch ein Anlass, mit der Kirche zu brechen. Die Wunden, die durch die Verfehlungen der in der Kirche Tätigen verursacht wurden, haben die Glaubwürdigkeit und die Autorität der Kirche untergraben. Was noch Gültigkeit hat, ist zum dauernden Gegenstand der Diskussion geworden. Paare besprechen ihre Sorgen nicht mehr mit einem überforderten Pfarrer, sondern mit dem Paartherapeuten. Dass die Menschen im 21. Jahrhundert die überlieferten Gebote nicht befolgen und dass sie mit dem anderen Geschlecht und auch dem eigenen nur schwer zu Rande kommen, ist offensichtlich. Eine neue Aufklärung über eine befriedigende und sehnlich gewünschte Liebe erscheint unumgänglich.
Was können wir wissen?
»Der Mensch lebt nicht vom Brot allein«, doch die Welt scheint von allen guten Geistern verlassen und von unseligen Vorstellungen in die Irre geführt zu sein. Immer wieder kommt mir da in den Sinn: »Ich nenne euch nicht mehr Knechte, denn der Knecht weiß nicht, was
sein Herr tut. Vielmehr habe ich euch Freunde genannt, weil ich euch alles kundgetan habe, was ich von meinem Vater gehört habe.« (Joh. 15,15) Christus gibt auf die Frage von Nikodemus: Was geht aus dem Geist hervor, die einfache Antwort: »Wahrlich, wahrlich, ich sage euch: Was wir wissen, davon reden wir, und was wir gesehen haben, bezeugen wir. Ihr aber nehmt unser Zeugnis nicht an. Wenn ich von den irdischen Dingen zu euch geredet habe und ihr glaubt nicht, wie werdet ihr glauben, wenn ich von den himmlischen Dingen zu euch rede?« (Joh. 3,11) Ist das schwer zu verstehen? Das gilt für die Wissenschaft, wobei die himmlischen Dinge als die Grundlagen des Geistes und der Geisteswissenschaft verstanden werden könnten, wie Sprachstruktur und Logik, deren Gesetze befolgt werden müssen, damit bestimmt werden kann, was wahr und was falsch ist. Warum kann nicht das, was die Liebe und das Zusammenleben betrifft, für die Moral und die modernen Glaubenssätze zur Geltung und mit den Folgen und »Früchten« daraus in Zusammenhang gebracht werden? Würde das nicht auch ein gesichertes Wissen über das von den Menschen erwünschte und erhoffte Leben ergeben und, verglichen mit den tradierten Geboten und Empfehlungen, in einem neuen Licht erscheinen? Könnten wir in diesem Sinn Freunde werden? Es sind die Grundsätze und Gesetze, die im Geiste also im Himmel geschrieben stehen, von unsichtbaren Engeln also Gedanken an jene Menschen herangetragen werden, die den Glauben an den Wert der Überlieferungen und Traditionen verloren haben und die Erfahrungen der Alten prinzipiell ignorieren und alles ausschließlich selbst erproben wollen. Lieber Absolvent der Universität von Philadelphia, hilf uns die Brücke zwischen Geist, Religion und Wissenschaft zu bauen!
Ideologien und Religion
Und gilt das nicht auch für die großen Ideen und Ideologien, die das 19. und 20. Jahrhundert bestimmt haben, in denen das Menschliche und göttlich Genannte außer Acht gelassen wurde und ins Unglück geführt hat? Heute, wo der materialistische Wirtschaftskrieg die dominante Erscheinungsform ist und über die Sprache des Geldes abgehandelt wird, scheint der moralische Appell auf verlorenem Posten zu stehen. Wir Gläubige sollten uns mit den faktischen Normen und Grundsätzen der Weltwirtschaft genauso auseinandersetzen, wie mit den moralischen. So könnte eine Gesellschaft entstehen, die der Würde der Menschen und ihren Bedürfnissen gerecht wird und entspricht, und die Gläubigen nicht nur den Armen und Opfern helfen und Trost spenden und um Almosen bitten, sondern auch mit den Vertretern der Regierungen, den Mächtigen über menschliche Finanzgesetze und mit den Bankern und Börsianern über ihre Taten und Entscheidungen reden. Ich denke, es genügt nicht, die Weltwirtschaft als »tödlich« zu brandmarken, sondern es muss bei den Vorschriften, wie bei den Geboten auch ein menschliches »Du sollst« stehen. Es sind ja die bestehenden Normen und Gesetze, die vorschreiben, was zur Zeit geschehen soll und geschieht. Könige und Regierungschefs, die sich am Grabe vor Franziskus verbeugten, scheinen sein flehentliches Beten und Bitten um Frieden, Menschlichkeit und Gerechtigkeit beim Verfassen von Vorschriften und Gesetzen rasch zu vergessen.
Lieber Bruder, lieber Bischof von Rom, hilf uns, diese wesentlichen Grundsätze zu klären und neuen zum Durchbruch zu verhelfen. Dear brother Leo, you said: I come like a brother I would like so much that you come and visit us in Graz! Dann könnten wir an einem wärmenden Lagerfeuer gutes Brot essen und herrlichen Wein trinken, »Großer Gott wir loben Dich«, »My sweet Lord« und »Komm lieber Mai und mache die Bäume wieder grün« in der Südsteiermark (die ist so schön wie die Toskana) singen. Dann könnte ich Dir alle meine Brüder und Schwestern und die Frau vorstellen, die geweint hat, als sie hörte, dass es für sie aus theologischen Gründen nicht möglich sei, zum Priester geweiht zu werden. Das kann sie nicht verstehen und empfindet es als tief verletzend. Du könntest uns vieles erklären. Wir könnten vieles gemeinsam klären und zu einem fruchtbaren, tieferen und aufklärenden Glauben finden.
Dann ... könnte ich dir auch den Blick von meinem Fenster aus auf den Platz zeigen, wo Stephanus leidvoll gegen den Himmel blickt. Wir könnten auch das Kloster der Franziskaner besuchen. Oder in einem meiner Stammlokale, wie Kirby‘s American Kitchen oder im Gut Schlossberg, Cafe Turners oder im Gatto, dem Café im Volkskundemuseum – alles um die Ecke – gemeinsam eine Tasse Kaffee trinken, bevor Du Deine Reise nach Wien fortsetzt. Lieber Leo, sei unser Gast! n
Wir Gläubige sollten uns mit den faktischen Normen und Grundsätzen der Weltwirtschaft genauso auseinandersetzen, wie mit den moralischen.

Karl Brodschneider wurde am 9. Jänner 1964 als ältestes von drei Kindern in eine Wundschuher Bauernfamilie geboren. Er ist verheiratet, hat zwei erwachsene Kinder und war mehr als zwei Jahrzehnte Bürgermeister von Wundschuh. Er ist seit 1986 Redakteur bei »Neues Land« vom Steirischen Bauernbund, seit 2019 Chefredakteur und seit 1999 Schriftleiter des Steirischen Bauernkalenders. Weiters Redakteur der Wundschuher Gemeindezeitung, ÖKB-Obmannstellvertreter und geschäftsführender Wirtschaftsrat der Pfarre Wundschuh.
Volker Schögler trifft auf Karl Brodschneider
Die Redaktionsräume der Wochenzeitung des Steirischen Bauernbundes »Neues Land« im »Steiermarkhof« sind im Grazer Bezirk Wetzelsdorf symbolträchtig situiert, denn der vormalige »Raiffeisenhof« oder »Schweizerhof«, ein modernes Bildungs- und Veranstaltungszentrum mit Hotel, verbindet mit seiner Lage am Rande von Graz den urbanen und den ländlichen Raum. Diese Funktion wird von Karl Brodschneider (61), dem Chefredakteur des Blattes, seit vielen Jahren geradezu perfekt verkörpert. Als der Wundschuher Bauernsohn und heutige Berufsschreiber mit zehn Jahren »in die Stadt« an das Oeversee-Gymnasium kam, war es für ihn ein Kulturschock: »In Deutsch waren meine ersten Noten 5, 5, 2, 4, 1, 1 – und dann ist es so weitergegangen. Diese Umstellung hat also offenbar gedauert.« Aber er hat Grundsätze und Traditionen mitgebracht und auch beibehalten, die zum Teil an alte steirische Bauernregeln erinnern (»Es hat alles seine Zeit«), die auch in seiner Gläubigkeit wurzeln, die Bodenhaftung und Verlässlichkeit sowie eine wohltuende Bescheidenheit erkennen lassen und ihm zweifellos dazu verholfen haben, gewaltige Arbeitspensen und Aufgaben zu erfüllen, nicht zuletzt als beliebter Regionalpolitiker – mit anderen Worten, von diesem Mann kann man bedenkenlos einen Gebrauchtwagen kaufen.
Doch der Reihe nach: Ausdruck von Brodschneiders Konstanz ist die kontinuierliche Beschäftigung als »Neues Land«-Redakteur im 40. Jahr, wo er seit sechs Jahren Chefredakteur ist. Ebenfalls seit 1986 ist er hauptverantwortlicher Redakteur der Wundschuher Gemeindezeitung. Und ebenfalls seit 1986 engagiert er sich in der Politik. Zunächst drei Jahre als Ortsobmann der JVP, dann 24 Jahre als ÖVP-Ortsparteiobmann. Mit 31 wurde er Vizebürgermeister, mit 32 Bürgermeister von Wundschuh, was er mehr als 22 Jahre lang auch blieb. Brodschneider: »In der Zeit als Bürgermeister, der ein Fulltimejob ist, war ich beim Bauernbund teilzeitbeschäftigt, mit sehr flexiblen Arbeitszeiten.« Als leidenschaftlicher Wundschuher, der »in der Stadt« arbeitet, hat Brodschneider von Anfang an seine Spur gefunden. Nach Matura und Bundesheer arbeitete er kurz in der Genossenschaft als Leiter eines kleinen Lagerhauses und einige Monate im damaligen Steirischen Landwirteverband. Zur Bauernbund-Wochenzeitung »Neues Land« kam er über Vermittlung seines damaligen Publizistik-Lehrers am Bundesseminar Ober-St.-Veit in Wien, wo er noch eine Ausbildung zum Landwirtschaftslehrer und -berater gemacht hatte. Dafür musste er sich zunächst noch in einem dreimonatigen Praktikum bei der Landwirtschaftskammerzeitung »Landwirtschaftliche Mitteilungen« bewähren, wo er in der Abteilung Landjugend seine Frau Rosemarie kennenlernte. Das unter Einbeziehung der Vorgänger
»Bauernbündler« oder »Sonntagsbote« im Jahr 1869 gegründete »Neue Land« ist im Übrigen die älteste Wochenzeitung in der Steiermark. Brodschneider: »So bin ich eigentlich zufällig zu diesem Beruf gekommen, worüber ich sehr glücklich bin.«
Und wieso wird man dann eigentlich Bürgermeister? »Für andere zu arbeiten bedeutet letztendlich auch eigene Lebensqualität, weil so viel Schönes zurückkommt, so dass man sich auch selbst weiterentwickelt und auch Glücksmomente empfinden kann. Das ist mir oft passiert, sowohl über die Vereinsarbeit als auch über die politische Arbeit als Bürgermeister.« Und Brodschneider weiter: »Als Dorfbürgermeister kann man wie in kaum einer anderen Funktion Vertrauen aufbauen, man ist zugleich in einer kleinen überschaubaren Gemeinde doch eine Autorität, die von vielen anerkannt wird. Ich habe unglaublich gute Mitarbeiter gehabt und konnte meine Ziele und Visionen auch umsetzen.« Der Vater zweier erwachsener Kinder macht noch etwas, wofür er im ganzen Land bekannt ist und das titelgebend für diesen Artikel ist: Er ist der Kalendermann, weil er für den Bauernbund als Schriftleiter den Steirischen Bauernkalender produziert. Ein im ländlichen Bereich beliebtes Jahrbuch mit aktuell über 250 Seiten, dessen Auflage von 20.000 Stück um 15 Euro pro Buch auch wirklich verkauft wird. Und das seit gefühlt einer halben Ewigkeit für Beständigkeit und Verlässlichkeit steht, Informationen vermittelt, unterhält und Generationen verbindet. Und weil der Bauernbundmitgliedsbeitrag noch persönlich eingehoben wird, ist der Kalender immer ein Türöffner gewesen: Man geht Kalender verkaufen und meint damit Inkasso machen: »Das ist auch eine Stärke des Bauernbundes, dass der Kontakt zu den Mitgliedern sehr groß ist. So werden zumindest einmal im Jahr die Mitglieder persönlich aufgesucht.« Verkauf und Inserate machen aus dem Bauernkalender, einer gelungenen Mischung aus Kalender und Geschichten, ein wertvolles Produkt, namentlich auch in finanzieller Hinsicht.
Der nunmehrige Altbürgermeister Karl Brodschneider hat sein Amt Anfang 2019 an jüngere Hände übergeben und blickt auf viele realisierte Projekte zurück: »Mein persönliches Highlight war die Ersteigerung des ehemaligen Ziegelwerk-Areals im Jahr 2010, auf dem sich heute der Bauhof, eine Vereinslagerhalle und ein großer Eislaufplatz befinden.« Heute sitzt Sohn Martin im Gemeindrat und da sagt der Senior wieder dieser Satz: »Es hat alles seine Zeit. Und man verbraucht sich auch, da ist Ehrlichkeit zu sich selbst notwendig.« – Sagt der Chefredakteur, der Schriftleiter, der Gemeindezeitungsredakteur, das engagierte Mitglied mehrerer Vereine und der geschäftsführende Wirtschaftsrat der Pfarre Wundschuh. Wie meint er das bloß? n
Carola Payer über den gepflegten Streit

Dr. Carola Payer betreibt in Graz die »Payer und Partner Coaching Company«. Sie ist Businesscoach, Unternehmensberaterin und Autorin. payerundpartner.at
Haben Sie in Ihrer Buchhaltung eine eigene Kontenklasse für Konfliktkosten? Zeigt Ihre Gewinn- und Verlustrechnung, wie viel Sie in nicht effektiv ausgetragene oder verdrängte Konflikte bzw. Harmoniesucht investiert haben? Berechnet Ihre Controllingabteilung die Opportunitätskosten für Kommunikation über Dritte statt direkter Klärung von Spannungen? Nein? Dann sollten Sie Ihre Unternehmenskultur zumindest auf die »Kompetenzen der positiven Reibung« oder die Tendenz zur Harmoniesucht überprüfen.
Fehlen von Kritik
Führungskräfte, die auf Harmonie achten, sind charmant, freundlich, loyal und beliebt. Sie sorgen für ein gutes Betriebsoder Teamklima, loben ihre Mitarbeiter und haben immer ein offenes Ohr und eine offene Tür. Mitarbeiter werden nicht nur als Ressource betrachtet, sondern der Mensch dahinter wird wahrgenommen. Lauter gute Qualitäten, die dazu beitragen, dass Mitarbeiter sich gut aufgehoben fühlen. Dominiert jedoch die Harmonie, artet diese zur Harmoniesucht aus. Harmoniesüchtige Führungskräfte vermeiden es, unangenehme Dinge anzusprechen. Sie wollen um keinen Preis jemanden verletzten, sondern beliebt bleiben. Die Konsequenzen daraus sind fehlendes kritisches Feedback oder »schwammig« formulierte Rückmeldungen mit vielen Weichmachern: »Wären Sie so lieb, … vielleicht könnten Sie mal, ich bin total zufrieden mit ihnen, aber da wäre vielleicht noch ein klein wenig …« Menschen mit zu hoher Toleranz akzeptieren von den Erwartungen abweichende Verhaltensweisen zu lange und fördern damit die Weiterentwicklung von Eigenheiten und destruktiven Kooperationsmustern. Schwierige Mitarbeiter in einem Team werden oft von Führungskräften durch fehlende klare Führungshandlungen »mitkonstruiert«. Harmoniesucht macht sich ebenso bemerkbar in nicht getroffenen oder hinausgeschobenen Entscheidungen. Klare Positionierung zu einem Standpunkt bietet eine Angriffsfläche. Konfrontationen werden vermieden, Graubereiche werden aufrechterhalten. Mitarbeiter leiden dann unter fehlender Klarheit in ihrem Wirkungsbereich. In Besprechungen herrscht die Suche nach Konsens oder das Zurückhalten der eigenen Meinung vor. Unterschiedliche Sichtweisen werden als unangenehm empfunden oder als Konflikt inter-
»Harmoniesucht
führt leicht zu fehlender Klarheit, Missverständnissen und dem Auftrechterhalten von Konflikten. Der reduzierte Meinungsaustausch geht auf Kosten der Kreativität. «
CAROLA PAYER
pretiert. Die offene Tür führt dazu, dass Mitarbeiter diese zu oft nutzen, was bei der Führungskraft zu Überlastung und bei Mitarbeitern zu geringerer Selbstständigkeit führt. Helfen wollen führt zu Abhängigkeitsverhältnissen. Mitarbeiter nutzen diesen Wunsch nach positiven Beziehungen, um für sich Vorteile durchzusetzen. Fehlende positive Dominanz der Führungskraft wird oft mit negativer Aggression im Team ausgeglichen. Fehlende Entscheidungsfähigkeit wird als Führungsschwäche gesehen. Harmonisches Verhalten von Führungskräften ist keine bewusste Führungshandlung, sondern wird unbewusst von den eigenen inneren Antreibern nach Sicherheit, Harmonie, fehlendem Selbstbewusstsein, Angst vor Ablehnung, Wunsch nach Zugehörigkeit, Anlagen zum Helfersyndrom und Anerkennung verursacht. Erkennen der eigenen Muster hilft zu einem klareren Führungsstil. Gute Beziehungen zu den Mitarbeitern brauchen Augenhöhe und Reibung und dürfen nicht von der Angst vor offener Kritik dominiert werden. Kritik ist nicht negativ, sondern eine Chance. Der eigene Selbstwert muss stabilisiert werden und darf nicht von der Sympathie der Mitarbeiter abhängen.
Die Kuschelgruppe: Harmoniesucht in Teams Teamfähigkeit und Kollegialität sind wesentliche Spielregeln in Teams. Jedoch sollte das nicht zu Dauerkonformismus und Konfliktscheue führen. Wie viel Harmonie ist gut und wann wird sie zum Hemmschuh? Produktive Teams zeichnen sich dadurch aus, verschiedene Sichtweisen aufs Tapet zu bringen und konträre Aussagen lustvoll zu diskutieren. Die Zuspitzung von Standpunkten wird zugelassen. Harmoniesüchtige Team-
mitglieder erleben eine andere Sichtweise oft als Angriff auf die eigene Idee und nehmen das persönlich. Produktive Teams achten bei konfliktträchtigen Ansätzen, ob diese der Sache, dem Projekt oder dem Kunden dienen. Falsche Entscheidungen werden als Experiment betrachtet und es wird schnell ein neuer Weg gesucht.
Feedback als Entwicklungschance
Harmoniesüchtige Teams achten darauf, was richtig oder falsch ist. Die Angst vor Fehlern ist groß, da sie dem eigenen Image und der Beliebtheit schaden können. Produktive Teams sind offen für Feedback und sehen es als Entwicklungschance. Harmoniesüchtige Teams vermeiden offen Kritik, lieben die Meinungsmonokultur und wurschteln lieber weiter, statt direkt nachzufragen. Mauscheln, jammern, mobben, verdrängen, subtile verdeckte Machtkämpfe ersetzen klare Auseinandersetzung bei persönlichen Problemen. Kleine Konflikte können über die Zeit zu Konfliktbomben werden. Oberflächliches »Wir schätzen uns alle« verhindert wahre Wertschätzung der Stärken und Schwächen jedes Einzelnen. Schönreden von Situationen ist eine beliebte Strategie.
In Summe führt Harmoniesucht zu fehlender Klarheit, Missverständnissen und dem Auftrechterhalten von Konflikten. Der reduzierte Meinungsaustausch geht auf Kosten der Kreativität. Kulturelle Gärprozesse und Umgehungstaktiken statt Konfliktlösung werden initiiert. Effektive und effiziente Kooperation ist dadurch gefährdet und kostet Energie, Nerven und Geld. »Wo alle gleich denken, denkt keiner mehr viel.« Bedenken Sie das bei Ihrer nächsten Bilanz. n

Die Politik hat mit der Staatsgießkanne herum pritschlt und wir ham wie halt üblich eingstraft und brav den Mund ghalten.



Liebe Steirer und Innen! Es grüßt Euch ganz herzlich wie immer Euer Sepp Oberdengler zu einer Nachschau im Mai sowie einer Vorschau in den Juni. Alles neu macht der Mai, er macht Herz und Hirne frei, sagt der Volksmund.
Mir geht es jedenfalls so wenn ich jetzt durch die Natur geh, es is einfach nur schön, Frische und Aufbruch überall. Das reißt einen mit, jedenfalls mich. Das is positiv und des brauch i auch mehr denn je. Denn wenn wir diese Folter durch Vollspaltenböden nicht bald ganz abschaffen, sind wir die wahren Schweindln, so wie wir mit den Schweinen umgehen.
Und wenn ich mir den Schuldenberg im Bund, dem Steirerland und den der Gemeinden anschau, macht meine Maifreude eine endgültige Vollbremsung. Koste es, was es wolle, hat es zur Coronazeit politisch geheißen, und es wurde praktisch mehr Geld als nötig quasi verschenkt. Mia hams ja, hab ich damals kritisch aber ungehört bemerkt und jetzt hama den Scherbn auf. Spoarn, das ist schwer.
Besser die anderen sparn, warum i, klingts von der Höh. Über Jahre is Göld mit vollen Händen verschiedenst außigeschmissen worden, weil man das für die Lösung hielt, und jetzt san ma pleite. Aber Politik braucht weniger Göld, dafür mehr Hirnschmalz. Wer is also schuld? Die Politiker fallen uns als Erstes ein, sie können halt mit Göld net umgehen, vor allem mit unserem. Guat, die Pandemie, wer hat schon gwusst, wie man damit richtig umgeht, obwohl jetzt manche Populisten alles besser gwusst haben wollen.
Nur die vielen und sehr hohen, auch oft unnötigen Coronaförderungen – wie man hört, sogar für Bundesligafußballvereine und manchen gutgestellten Unternehmer –, hat des sein müssen? Ich hoffe, dass das genau geprüft und wenn nötig, rückerstattet wird. Aber die Hand aufghalten ham auch wir, die Bürger, sogar
beide Händ. Oder? Ich habe niemanden ghört, der seinen Klimabonusscheck zruckgeben hat oder gsagt hat, na i zahl gern die Umsatzsteuer für den Heizungswechsel oder irgend a andere Förderung abglehnt hätt? Die Politik hat mit der Staatsgießkanne herum pritschlt und wir ham wie in solchen Fällen üblich eingstraft und brav den Mund ghalten. Jetzt müssma dafür den Gürtl enger schnallen, aber net alle, die, die wirklich Kohle haben, die trifft es ja net wirklich, und die Pensionen werden sowieso nicht angrührt, denn wer das tut, ist politisch tot.
Mut und Fantasie sind gefragt, schaun wir mal, Fantasie hätt ma ja, aber mit Mut ist das so eine Sache. Besser wir schwurbeln und mauscheln so weiter, bis ma letztlich an fettn Zipfl erwischn, schon san ma aus dem Schneida und so schlimm wird es eh net, denk ma uns. I bin I, und die andern san ma wurscht.
Doch es wird schlimm, liebe Freunde, denn nicht nur wirtschaftlich schwächelt Österreich gewaltig, auch Europas Schwierigkeiten drücken auf uns, und die Weltpolitik, die findet keinen deutlichen und gangbaren Weg mit Trump, Putin, Netanjahu und Konsorten. Und dass sich die Welt immer rechter in Richtung Autoritarismus dreht, macht die Aussichten nicht rosiger. Wir können das schaffen, aber nur mit Vernunft und gemeinsam.
Ich hoffe auch sehr auf Papst Leo den 14., der wie Franziskus neben dem Fischerring auch Gesundheitsschuhe trägt, dass er sich mit einer klaren Haltung für Frieden, Gerechtigkeit und die Armen dieser Welt einsetzen wird. Und natürlich hoffe ich auf die Mithilfe des Heiligen Geistes, der ihn uns ja auch geschickt hat. Egal welchem Glauben man angehört, wir können jede Hilfe brauchen, in diesem Sinne noch einen schönen Mai, für den Juni Gesundheit und Mut, der tät uns allen gut. Achso, einen Buchtipp hätt ich auch noch: »Feigheit« von Adelheit Kastner, ein unbestechlicher Spiegel für uns alle.
Also, Euch alles Gute und bis zum Nächsten Mal, Euer Sepp Oberdengler.
PS. Aufpassen! Der Teif’l schloft net!

Seit beinah 130 Jahren begleitet die Grazer Bestattung die Menschen in Graz in ihren schwersten Stunden. Verlässlich, respektvoll und professionell achtet sie darauf, dass am Ende alles passt.
Als städtisches Unternehmen ist die Grazer Bestattung den Grazer:innen besonders verbunden: Keine andere Bestattung in Graz kann auf eine so reichhaltige und lange Erfahrung in der Begleitung von Hinterbliebenen und der Organisation von Trauerfeiern verweisen.
Ein verlässlicher Partner
Diese Verbundenheit sieht die Grazer Bestattung auch als Verpflichtung der Grazer Bevölkerung gegenüber: Ausschließlich bestens geschulte hauptberufliche Bestatter:innen, die über das nötige Fachwissen und die Empathie verfügen, stehen den Hinterbliebenen in ihrer schweren Zeit bei. Mit dem denkmalgeschützten Jugendstil-Zeremoniensaal am Urnenfriedhof, dem Urnenfriedhof selbst und der Aufbahrungshalle in Mariatrost verfügt die Grazer Bestattung zudem über hauseigene Einrichtungen, die sich für die Allgemeinheit erhält und betreut. Diese

ausgezeichnete Infrastruktur von Aufbahrungshallen und Verabschiedungsmöglichkeiten bietet die Grazer Bestattung ihren Kund:innen ohne zusätzliche Kosten wie Mieten, Gebühren oder Aufschläge an.
Rundum bestens betreut
Der Service das Bestattung Graz umfasst alle Leistungen einer würdevollen Bestattung. Dazu gehören unter anderem die Organisation der Trauerfeier, die Auswahl von Sarg und Urne, die Gestaltung von Trauerdrucksachen sowie Unterstützung bei sämtlichen Behördenwegen. Bei vielen Menschen werden neben den klassischen Erd- und Feuerbestattungen naturnahe Bestattungsformen immer beliebter. Die Grazer Bestattung schafft mit der Baumbestattung in einer Parkanlage am Urnenfriedhof oder einer Rasenbestattung ganz besondere Orte der Erinnerung. Die Urnen werden somit nicht in den Wald gebracht, sondern die Natur auf den Friedhof geholt.

Damit wird die öffentliche Erreichbarkeit ebenso sichergestellt wie der barrierefreie Zugang und die vorhandene Infrastruktur. Auch beim wichtigen Thema der Kosten setzt die Grazer Bestattung auf absolute Preistransparenz. Ohne nachträgliche Verrechnungen kann man sich so darauf verlassen, dass es beim vereinbarten fairen Preis bleibt.
Aus Graz, für Graz
Wenn ein geliebter Mensch stirbt, will man, dass rund um das Begräbnis alles so einfach und reibungslos wie möglich abläuft. Die Grazer Bestattung verfügt über ein eigenes Krematorium. Die Hinterbliebenen können daher darauf vertrauen, dass die Verstorbenen ohne Umwege in Graz kremiert werden und dafür nicht über die Stadt- oder gar Landesgrenzen gebracht werden. Die Grazer Bestattung wird ihrem Ruf als kommunaler Top-Dienstleister im Auftrag der Menschen in Graz jeden Tag aufs Neue gerecht.
24/7 für Sie da Die Grazer Bestattung ist 24 Stunden am Tag, sieben Tage die Woche für Sie unter 0316 887-2800 erreichbar.
grazerbestattung.at

„Unsere 210.000 Versicherten erhalten ein neues Gesundheitszentrum mit Facharzt-, Diagnose- und Therapiezentrum sowie telemedizinischer Begleitung. Mit diesem umfassenden Angebot stärken wir die Prävention und leisten einen Beitrag zur regionalen Versorgung“, erklärt SVS-Obmann Peter Lehner bei der Präsentation des SVS-Gesundheitszentrums (GZ) am 14. Mai in Graz. „Mit dem neuen Gesundheitszentrum wird ein weiterer Schritt für eine hochwertige Gesundheitsversorgung in der Steiermark gesetzt“, betont auch LR Karlheinz Kornhäusl. Das Gesundheitszentrum entsteht im neuen SVS-Gebäude am Campus der Wirtschaft auf dem WKO-Areal. Umsetzungspartner sind die Vinzenz Gruppe und der Konvent der Barmherzigen Brüder Graz.


In den vergangenen beiden Jahren haben sich die Layjet Open im Sportaktivpark Bad Waltersdorf als drittgrößtes Herren-Tennisturnier in Österreich etabliert. Vom 14. bis 21. September 2025 erlebt dieses ATP-125er-Challenger-Turnier im südoststeirischen Thermen- und Vulkanland, heuer mit einem Preisgeld von 181.250 Euro, seine dritte Auflage. „Mit der dritten Auflage der Layjet Open darf man schon von einer kleinen Tradition sprechen. Das ist in zweierlei Hinsicht extrem erfreulich – einerseits sportlich, weil wir dabei sind, dieses Turnier fix in internationalen Tennis-Kalender zu positionieren. Andererseits wirtschaftlich für den Tourismus und die Umsätze in der Region“, sagt Turnierdirektor Sascha Freitag.
Zum 19. Mal hat der Finanz-Marketing Verband Österreich (FMVÖ) die Recommender Awards verliehen. Im Jubiläumsjahr darf sich die Steiermärkische Sparkasse besonders freuen: Als einzige steirische Bank wurde sie gleich mit zwei Auszeichnungen prämiert. Neben dem FMVÖ-Recommender-Gütesiegel für „Hervorragende Kunden-Orientierung“ konnte auch der begehrte Sonderpreis „Bank mit der besten Kunden-Beratung“ entgegengenommen werden. „Als verlässliche Finanzpartnerin stehen wir unseren Kunden in allen Lebenslagen persönlich und digital zur Seite. Insbesondere unseren Mitarbeitern ist es zu verdanken, dass wir für das hervorragende Kundenservice prämiert wurden”, betont Vorstandsmitglied Oliver Kröpfl.

(v.l.n.r.) AMS-Mitarbeiter Helge Röder, Moritz Minarik, Bettina Haberler (beide Accupower) und AMS Steiermark-GF Karl-Heinz Snobe
Unter dem Motto „Packen wir es gemeinsam an!“ tourte das AMS Steiermark von Ende April bis Ende Mai 2025 einmal mehr durch das Bundesland, um mehrere hundert Unternehmen persönlich zu besuchen. Ziel der Aktion ist es, die Firmen über nachhaltige Personalarbeit und aktuelle Fördermöglichkeiten zu informieren.
AMS-Landes-GF Karl-Heinz Snobe betont die Bedeutung der Zusammenarbeit mit der Wirtschaft: „Das AMS ist ein starker und verlässlicher Partner der steirischen Wirtschaft. Gerade in Zeiten des demografischen Wandels unterstützen wir Betriebe dabei, neue Mitarbeitende zu gewinnen und langfristig zu halten.“ Bereits bei der letzten Business Tour 2024 hatte das AMS Steiermark übrigens mit mehr als 1.800 die meisten Unternehmen im Vergleich aller Bundesländer besucht.
Professionelle Hilfe für Personalsuche Ein Highlight zum Tourstart war der Besuch bei Accupower, einem Spezialisten für mobile Energie. Der zur Moons Group zugehörige Spezialist für mobile Energie durfte kürzlich mit der Natrium-IonenBatterie NATEC eine nachhaltige Energielösung präsentieren. COO Bettina Haber-
ler lobt die Kooperation mit dem AMS: „Als stark wachsendes Hightech-Unternehmen brauchen wir gerade in der Fachkräfteentwicklung Partner, die lösungsorientiert sind und über den Tellerrand schauen können. Durch die professionelle Unterstützung konnten wir unser Team erfolgreich erweitern und schwierige Bedingungen meistern.“
Mit im Gepäck hatte das AMS eine Vielzahl an Förderprogrammen: von Eingliederungsbeihilfen bis hin zu Lehrstellenförderungen für über 18-Jährige. Durch arbeitsplatznahe Ausbildungen können künftige Fachkräfte direkt im Unternehmen praxisnah geschult werden. Auch bestehende Beschäftigte profitieren – etwa durch die Qualifizierungsförderung. Zusätzlich gibt es Impulsberatungen mit externen Experten und Expertinnen zur Steigerung der Arbeitgeberattraktivität.

Die Grünen werfen der Landesregierung vor, den Lufthunderter ohne fachliche Grundlage abgeschafft zu haben. Warum war das für Sie so wichtig?
Wir bekennen uns zu einer den Mobilitätsbedürfnissen entsprechenden Verkehrspolitik. Die Emissionswerte der Fahrzeuge haben sich verbessert und die Grenzwerte wurden seit Jahren eingehalten. Die rechtlichen Rahmenbedingungen und die Datenlage geben es daher sehr wohl her. Unsere Aufgabe ist es, Entscheidungen zu treffen, und das haben wir gemacht.
Auf den Sozialbereich kommen budgetäre Einschnitte zu. Wie wollen Sie das System treffsicherer machen?
Das Sozialbudget beträgt über eine Milliarde Euro, wobei 93 Prozent Pflichtausgaben betreffen. Ja, wir befinden uns momentan in einer schwierigen Budgetlage. Wir werden alle Möglichkeiten ausschöpfen, damit das Sozialsystem weiterhin unseren Staatsbürgern offensteht, die auf die Hilfe der Solidargemeinschaft angewiesen sind.
Sie sprechen von Strukturreformen im Sozialsystem. Wie lassen sich die mit sozialer Gerechtigkeit in Einklang bringen?
Unsere Sozialpolitik konzentriert sich vor allem auf die eigenen Staatsbürger sowie jene, die bereits einen Beitrag zu unserem System geleistet haben. Diese Solidargemeinschaft steht in der Verantwortung, Risiken durch Alter, Behinderung, Arbeitslosigkeit, Krankheit, Unfälle und Schicksalsschläge abzumildern. Das österreichische Sozialsystem wurde für in Not geratene Landsleute geschaffen und nicht als Zuwanderungshilfe.


Seit vielen Jahrzehnten ist die Volkshochschule Steiermark ein wichtiges Element in der Bildungslandschaft des Bundeslandes mit dem betonten Bekenntnis zu lebenslangem Lernen und gesellschaftlicher Teilhabe. Mit einem breiten Kursangebot und moderner Infrastruktur hat sich die VHS mit ihren zwölf Zweigstellen zu einem zentralen Bildungsanbieter in der Region entwickelt.
Beim breiten Bildungsangebot der VHS Steiermark, das sich neben bewährten Inhalten auch am Puls der Zeit und gesellschaftlichen Entwicklungen orientiert, stehen jährlich rund 4.000 Kurse auf dem Programm. Die VHS ermöglicht damit Menschen aller Altersgruppen und sozialen Hintergründe, sich weiterzubilden, neue Fähigkeiten zu erlernen und aktiv am gesellschaftlichen Leben teilzunehmen. Die bunte Palette reicht von Sprachen, digitalen Kompetenzen und Gesundheit bis hin zu Kreativität und Bewegung. Ein besonderes Augenmerk liegt auf aktuellen Themen wie Nachhaltigkeit und Energieeffizienz. Für die Vermittlung der umfangreichen und vielfältigen Inhalte in den einzelnen Kursen sorgt ein Pool von rund 1.500 freien und selbstständigen Dienstnehmerinnen und Dienstnehmern. Hinter der Organisation, Evaluierung sowie der Entwicklung der Programme steht ein Team von steiermarkweit 39 Mitarbeiterinnen und Mitarbeitern. Eine davon ist Birgit Niederl, verantwortlich für die Kursprogramme im AK-
Bildungszentrum in Graz: „Als Programmgestalterin achte ich sehr darauf, was den Menschen, die uns besuchen, wichtig ist, welche Themen sie sich von uns wünschen und in welchen Bereichen sie dazulernen wollen. Da gehört es auch immer dazu, neue Trends aufzuspüren und dafür gemeinsam mit den Kursleitenden passende Formate zu gestalten.“
Das Konzept lebenslangen Lernens
Die Tradition der Volkshochschulen reicht bis in das 19. Jahrhundert zurück, als deren Gründung auf Initiativen von Vereinen mit dem Ziel der Arbeiterbildung erfolgte. Aus diesen humanistischen Wurzeln ist der Bildungsbegriff nach dem Werteverständnis der VHS im ganzheitlichen Sinn zu sehen, umfasst also den ganzen Menschen, der nicht nur Wissen erwirbt, sondern dieses auch reflektiert, kritisch überprüft und im praktischen Handeln anwendet. Dabei wird keine klare Trennlinie zwischen beruflicher
Birgit Niederl ist für die Erstellung des Programms im Bildungszentrum Graz verantwortlich

und allgemeiner Weiterbildung gezogen, denn nur im Zusammenwirken beider Bereiche kann der Erwerb von Fähigkeiten und Kenntnissen den Qualifikationsanforderungen in der heutigen Berufswelt gerecht werden, erklärt Christof Kröpfl, Geschäftsführer der VHS Steiermark: „Wir verstehen uns als wichtiger Bildungspartner der steirischen Bevölkerung. Bildung ist ein zentraler Bestandteil des Lebens und hier leisten wir als Volkshochschule einen wesentlichen Beitrag.“
Eine neue Ära der Erwachsenenbildung
Im September 2019 hat die VHS Graz ihr neues Bildungszentrum in der Köflacher Gasse 7 eröffnet. Ein neuer Standort wurde notwendig, als man erkennen musste, dass die Institution aufgrund steigender Teilnehmerzahlen aus ihren alten Räumlichkeiten hinausgewachsen war. Mit einer Investition von rund 20 Mio. Euro durch die Arbeiterkammer Steiermark entstand auf rund 6.000 Quadratmetern im Westen von Graz eine der modernsten Bildungseinrichtungen Europas. Das achtgeschossige Gebäude beherbergt 43 modernst ausgestattete Seminarräume, darunter ein Ton- und Filmstudio, eine Schauküche, eine große, in mehrere Sektoren abteilbare Turnhalle mit Boulderwand sowie Ateliers fürs Töpfern, Malen und Zeichnen. Für kleine Pausen oder zum gemütlichen Lunchen lädt das Café „frederik“ im Haus mit italienischem Flair zum Verweilen ein.
Ein Ort der sozialen Begegnung
Ein zentrales Anliegen der Volkshochschule ist es, mit ihrem Angebot breite Kreise der Bevölkerung anzusprechen. Da die VHS Steiermark als Verein nicht gewinnorientiert agiert, werden die Kurse zu möglichst kostengünstigen Preisen angeboten. Um einen niederschwelligen Einstieg zu ermöglichen, fördert die Arbeiterkammer Steiermark die Weiterbildung ihrer Mitglieder mit einem Bildungsscheck von 80 Euro pro Halbjahr, der auch für VHS-Kurse eingelöst werden kann. Diese Unterstützung unterstreicht das Engagement der AK für Bildungsgerechtigkeit und lebenslanges Ler-
nen, um so „Bildungsprozesse professionell in Gang zu bringen, zu begleiten und zu unterstützen“, betont AK-Präsident Josef Pesserl. Ein weiteres attraktives Angebot für junge Eltern ist das Karenzbildungskonto, damit bekommen AK-Mitglieder in Elternkarenz 1.000 Euro gutgeschrieben. Dieses Guthaben ist für VHS-Kurse bis zum zweiten Geburtstag des Kindes einlösbar.
Digitalisierung und Online-Angebote
Die zunehmende Digitalisierung der Lebenswelt schlägt sich auch im Kursangebot der Volkshochschule nieder. Für Einsteiger und Einsteigerinnen jeden Alters gibt es „Digital überall“-Workshops, eigene Kurse für ältere Menschen etwa zum Umgang mit der BusBahnBim-App, bzw. im fortgeschrittenen und professionellen Bereich finden sich Angebote zur praktischen Anwendung von Künstlicher Intelligenz (KI), Grafik- und Audiosoftware etc. für Beruf, Hobby und Alltag. Die VHS hat auf die Herausforderungen der digitalen Transformation entsprechend reagiert und bietet neben Präsenzkursen auch zahlreiche Online-Formate an. „Dies ermöglicht flexibles Lernen und erweitert den Zugang zu Bildung für Menschen mit unterschiedlichen Lebensumständen“, erklärt Christof Kröpfl: „Es ist wichtig, auch Online-Kurse im Angebot zu haben, für alle jene, denen es nicht möglich ist, zu den Kursorten zu gelangen. Primär aber ist die VHS ein Ort der Begegnung, wo sich Menschen mit gleichen Interessen treffen und sich gemeinsam mit Freude weiterbilden.“
Anmeldung und Kontakt:
• Das gesamte Kursangebot finden Sie auf der Website der VHS Steiermark. Die Anmeldung zu den Kursen ist online, telefonisch oder persönlich vor Ort möglich.
• Online: vhsstmk.at
• Telefonisch: +43 57799-5000
E-Mail: vhs@akstmk.at Öffnungszeiten Graz: Montag bis Donnerstag von 08:00 bis 16:00 Uhr, Freitag von 08:00 bis 13:00 Uhr.

VHS-GF Christof Kröpfl: „Die VHS soll ein Treffpunkt sein, um miteinander zu lernen, aufeinander zuzugehen und in Diskurs zu treten.“


(v.r.) IWS-Leiter Ewald Verhounig, ZAM-GF Renate Frank, WKO Stmk-Präs. Josef Herk und EnergieErlebnisregion-Manager Michael Lamprecht
Trotz des Anstiegs der Arbeitslosigkeit verzeichnet die Steiermark einen akuten Fachkräftemangel in klimarelevanten Berufen. Laut einer aktuellen Bedarfsanalyse geben 85 % der Unternehmen an, Schwierigkeiten bei der Rekrutierung von Personal zu haben.
Österreichweit sind fast 13.000 sogenannte „Green Jobs“ unbesetzt – in der Steiermark allein über 1.500. Besonders betroffen sind Branchen wie Elektrotechnik, Installations- und Lüftungstechnik, Dachdeckerei und Ofenbau, in denen zum Teil auf eine arbeitslose Person zwei offene Stellen kommen. Um dieser Entwicklung entgegenzuwirken, hat die WKO Steiermark mit drei Klima- und Energiemodellregionen (Hügelland, Weiz-Gleisdorf, Liebochtal) und weiteren Partnern ein Pilotprojekt gestartet: Im Mai fanden fachspezifische Informationsmessen statt, die sich gezielt an Quer- und Wiedereinsteiger richten.
Potenziale sichtbar machen
WKO-Präsident Josef Herk betont, dass bis 2030 in der Steiermark rund 40.000 Personen im erwerbsfähigen Alter fehlen. Er sieht in der Erwachsenenmesse einen innovativen Ansatz zur Fachkräftesicherung. Michael Lamprecht, Manager der Energie-Erlebnisregion Hügelland, verweist auf das neue Veranstaltungsformat „Jobmotor“, das Potenziale sichtbar mache und konkrete Maßnahmen zur regionalen Fachkräftesicherung setze.
Ewald Verhounig vom Institut für Wirtschafts- und Standortentwicklung betont, dass die Umweltwirtschaft allein in der Steiermark einen Umsatz von über sieben Mrd. Euro und eine Wertschöpfung von 2,5 Mrd. Euro erwirtschaftet, „und mit dem Boom der Umweltwirtschaft geht auch ein Boom der Greens Jobs einher.“ Renate Frank vom zam Steiermark betont insbesondere das Potenzial von Frauen als „stille Reserve“ auf dem Arbeitsmarkt. Sie seien besonders engagiert im Bereich Nachhaltigkeit und könnten als „kraftvoller Jobmotor“ wirken, wenn entsprechende Rahmenbedingungen geschaffen würden.

Der spielerische Einstieg in die Robotik macht sichtlich viel Spaß.
Am 15. Mai 2025 fand die siebte Auflage der Robo League statt – ein RobotikWettbewerb, bei dem 120 Jugendliche aus zehn Schulen der Steiermark und Kärnten in fünf Disziplinen gegeneinander antraten.
Die von Knapp organisierte Veranstaltung erfreut sich immer größerer Beliebtheit: Die Registrierung musste wegen des großen Andrangs bereits einen Monat vor Anmeldeschluss geschlossen werden. Insgesamt 45 Teams traten mit eigens programmierten Robotern an, um knifflige Aufgaben zu lösen. Dabei kamen moderne Robotik-Systeme wie Makeblock® mBot2 und Lego® Mindstorms EV3 zum Einsatz, die von den Schülern und Schülerinnen mit code-basierter Programmiersprache gesteuert wurden. Eine der Disziplinen war „Follow the Road“, bei der der Roboter eine vorgegebene Strecke möglichst fehlerfrei absolvieren musste.
Einstieg in digitale Welten
Seit 2017 bietet die Robo League Schülern und Schülerinnen eine Plattform, auf der sie spielerisch die Welt der digitalen Technologien entdecken können. Unterstützt wurden die Bewerbe auch in diesem Jahr von 20 Knapp-Lehrlingen, die als Schiedsrichter und Organisatoren mitwirkten. Die intensive Vorbereitung im Unterricht – unterstützt durch umfangreiche Schulungsunterlagen – zahlte sich aus: Die Leistungen waren beeindruckend. Als Sieger gingen die Teams aus der PMS Dobl, der MS Wildon, der MS Semriach, dem BRG Petersgasse und dem Peraugymnasium Villach hervor. Für die Nachwuchs-Talente gab es eine Siegerehrung mit viel Applaus und die Überreichung der Preise in Form von Kino-Gutscheinen.
„Wir brauchen junge Talente, die den technologischen Fortschritt mitgestalten. Die RoboLeague ist ein wichtiger Beitrag dazu“, betont Wolfgang Skrabitz, Managing Director bei Knapp Industry Solutions. Das Unternehmen ist nicht nur Veranstalter, sondern auch Gründungsmitglied der Mintality-Stiftung, die speziell Mädchen für technische Berufe begeistern will.

(v.l. hinten): UMJ-GF Marko Mele, FLiP-Co-Kuratorin
Timna Pachner, LR Karlheinz Kornhäusl, SteiermärkischeVorstand Gerhard Fabisch, UMJ-kaufm.-GF Josef Schrammel, (v.l. vorne) KIMUS-GF Jörg Ehtreiber und KIMUS-Kuratorin-Gerlinde Andraschek
Am 8. Mai 2025 hat im Grazer Joanneumsviertel das FLiP im CoSA eröffnet: Der interaktive Erlebnispark nimmt Jugendliche und Erwachsene auf eine abenteuerliche und anschauliche Reise durch die faszinierende Finanzwelt mit.
In fünf Themenbereichen – von Budgetplanung über Investitionen bis hin zu globalen Zusammenhängen – lernen Besucher und Besucherinnen im Center of Science Activities den bewussten Umgang mit Geld. Statt trockener Theorie erwarten sie virtuelle Abenteuer mit Fitnessrädern, Containerschiffen oder Haushaltsplanungen. Eine FLiP-Karte begleitet durch die Ausstellung, hilft beim Punktesammeln und ermöglicht dadurch eine individuelle Auswertung der eigenen Finanzkompetenz.
Finanzbildung als Erlebnis
Anlässlich ihres 200-jährigen Bestehens hat die Steiermärkische Sparkasse der Region mit ihrer Finanzierung dieses Projekts ein Bildungsprojekt geschenkt, das Finanzwissen spielerisch, alltagsnah und unterhaltsam vermittelt. „Finanzielle Gesundheit ist Grundlage für ein selbstbestimmtes Leben“, betont Gerhard Fabisch, Vorstand der Steiermärkischen Sparkasse, „Wer finanziell gesund sein und bleiben möchte, sollte sich möglichst früh mit Finanzbildung beschäftigen.“ KIMUS-GF Jörg Ehtreiber ergänzt: „Mit FLiP wird dieser Anspruch lebendig – kostenlos, barrierefrei und zweisprachig. FLiP im CoSA macht aus Finanzbildung ein Erlebnis – interaktiv, inklusiv und mit Mehrwert für die ganze Gesellschaft.“
Lehrpersonen erhalten begleitendes Unterrichtsmaterial, ein Besuch dauert rund zwei Stunden. Individualbesucher und kleine Gruppen ohne Buchung können das FLiP im CoSA selbstständig entdecken und den Besuch im eigenen Tempo gestalten. Das Projekt wurde gemeinsam mit der KIMUS Graz GmbH und dem Universalmuseum Joanneum realisiert und ist Teil eines Social-Franchise-Modells der gemeinnützigen FLiP-Initiative.


Auf dem Dach des NOVAPARK Flugzeughotels Graz bieten eine BOEING B-727 und eine Iljuschin Il-62M (am Bild nicht ersichtlich) einzigartige Locations in 22 Metern Höhe.
Der perfekte Ort in Graz für Seminare, Events & außergewöhnliche Aufenthalte
Ob Business-Meeting, Kongress oder exklusives Event – das Flugzeughotel NOVAPARK in Graz ist der verlässliche Partner für ein Rundum-Erlebnis der besonderen Art. Mit 22 flexibel gestaltbaren Seminar- und Tagungsräumen für Veranstaltungen jeder Art bietet das Familienunternehmen Raum, Technikausstattung und Service für bis zu 900 Personen.
Zahlreiche Zimmer, Suiten, Studios und Appartements ermöglichen ideale Aufenthalte für Geschäftsreisende sowie Eventgäste, denen darüber hinaus ausreichend Parkplätze direkt vor Ort zur Verfügung stehen. Entspannung pur findet man in der 3.000 m² großen Wellnessoase und Saunawelt oder in der Corrida Bar mit beeindruckendem Aqua-Terrarium und Live-Pianomusik. In der 80er Fliegerbar & Restaurant Iljuschin werden Gäste mit steirischen Spezialitäten in 22 Metern Höhe kulinarisch verwöhnt oder lassen den Tag mit einem Cocktail bei Live-DJ-Musik und Blick auf den Grazer Schlossberg ausklingen. Actionfans erleben im GATE-08 Flight Simulation Center die Faszination des Fliegens hautnah im Cockpit.
Exklusiv buchbar! Für besondere Anlässe checkt man im Flugzeugrestaurant BOEING ein und lässt sich in First-Class-Sitzplätze sinken. In der originalen BOEING 727-200 setzt man auf ein EventSetting, das in Erinnerung bleibt. Das erfahrene NOVAPARK-Team erstellt Veranstaltungspakete nach Maß für individuelle Bedürfnisse, vom Workshop bis zur Galanacht und begleitet jeden Kunden nicht nur professionell, sondern vor allem persönlich.
NOVAPARK Flugzeughotel Graz – alles unter einem Dach!

„AYPT 2025“ an der Montanuni Leoben
Vom 25. bis 27. April fand an der Montanuni Leoben der Österreichische Vorentscheid AYPT (Austrian Young Physicists Tournament) für die jährliche Physik-Weltmeisterschaft statt. Der Ausscheidungswettbewerb für die diesjährige Physik-Weltmeisterschaft in Lund, Schweden (29. Juni. bis 06. Juli), wurde auch heuer wieder unter der Leitung von Gerhard Haas in Kooperation mit dem Europagymnasium Leoben und dem Verein AYPT durchgeführt. „Wir freuen uns sehr, dass unsere Universität erneut Gastgeber ist. Dieses Turnier bringt nicht nur junge Talente aus der ganzen Welt zusammen, sondern ist eine ideale Plattform, um wissenschaftliches Denken, Teamarbeit und Begeisterung für Forschung früh zu fördern“, so Oskar Paris, Lehrstuhl-Leiter für Physik.

Spitzenergebnis für die FH Campus 02
Die FH Campus 02 wurde wieder in die Spitzengruppen der deutschsprachigen Hochschulen gereiht. Im aktuellen CHE-Hochschulranking bestätigt der Studiengang Automatisierungstechnik einmal mehr seine Spitzenstellung. „Die hervorragenden Bewertungen zeigen, dass wir mit unserer konsequenten Qualitätsstrategie auf dem richtigen Weg sind. Unser klarer Fokus auf Praxisnähe und eine studierendenzentrierte Betreuung bestätigt sich auch im aktuellen Ranking. Dass unsere berufstätigen Studierenden diese Qualität so hoch einschätzen, ist für uns ein starkes Zeichen und zugleich Ansporn, diesen Weg weiterzugehen“, freut sich Erich Brugger, GF der Campus 0202. Die Studierendenurteile bestätigen hohe Qualität des Studienganges.



Sommerbetreuung 2025 in Graz „Neun Wochen Ferien sind eine lange Zeit“, weiß Bildungs-, Familien- und Sportstadtrat Kurt Hohensinner, selbst auch zweifacher Familienvater, „für mich gibt es keine wichtigere Investition als in das Wohl und die Zukunft unserer Kinder. Gerade im Sommer ist es unser Ziel, dass die Kinder nicht nur betreut sind, sondern auch die Möglichkeit haben, Neues auszuprobieren, Abenteuer zu erleben und ihre Stärken zu entfalten. Im Programm des heurigen Jahres ist deshalb wieder für jeden Geschmack etwas dabei.“ In diesem Jahr wird ein neuer Schwerpunkt gesetzt. Inklusion steht im Vordergrund und so gibt es neben den „Camps for Champs“ Angebote des Fischereiverbandes oder auch der Kunstuniversität, die speziell auch Kinder mit Behinderung ansprechen.
JR Graz präsentiert neuen E-Rennwagen
Am 9. Mai stellte das Formula-Student-Team, Joanneum Racing Graz, im Audimax der FH Joanneum seinen neuesten Elektro-Rennwagen, den JR25, vor. Das Auto ist der vierte eigenständig gebaute Elektro-Rennwagen von Joanneum Racing Graz. Nach einer erfolgreichen Saison 2024 startet das Team motiviert in das neue Rennjahr und wird 2025 an drei internationalen Events des renommierten Konstruktionswettbewerbs Formula Student teilnehmen. Zur feierlichen Präsentation versammelten sich neben den Teammitgliedern – bekannt als „Weasels“ – auch zahlreiche Unterstützer und Unterstützerinnen, darunter Sponsoren, Mitarbeitende der FH Joanneum sowie Familienangehörige und Freunde. Gemeinsam wurde der offizielle Startschuss für eine neue Saison gesetzt.
Kreativ, engagiert und voller Unternehmergeist: So präsentierten sich die 14 Junior Companies aus zehn steirischen Schulen beim Junior Landeswettbewerb 2025 in der WKO. Schüler zwischen 15 und 19 Jahren stellten die Ergebnisse ihrer Arbeit vor – in Form von selbst gegründeten Unternehmen mit echten Produkten und innovativen Ideen. Den Landessieg holte sich das Team „[re]whey“ vom BG/BRG Stainach mit einem überzeugenden Konzept rund um Molkepulver. Das innovative Produkt, ohne Zusatzstoffe und industriellen Zucker, überzeugte die Jury durch seine vielseitigen Verwendungsmöglichkeiten und die unternehmerische Umsetzung. Mittlerweile wird dieses nicht nur mehr in im eigenen Onlineshop vertrieben, sondern auch in zwölf obersteirischen SPAR-Filialen.

Das Institut Diätologie und die Abteilung ZML − Innovative Lernszenarien der FH Joanneum arbeiten seit 2023 gemeinsam mit der Medipol University of Medicine Istanbul im EU-Projekt „BERNICA“ an der Etablierung der Ernährungsmedizin im Medizinstudium und der Förderung der Ernährungsforschung in Kirgistan, Kasachstan, Usbekistan und Tadschikistan. Manuela Konrad vom Institut Diätologie: „Das Projekt zielt darauf ab, Mediziner und Berufsgruppen aus dem Gesundheitsbereich in Ernährungsgrundlagen und deren Kenntnisse im Zusammenhang mit gesundheitsfördernder Ernährung und Ernährungstherapie zu erweitern. Dadurch sollen das Ernährungsverhalten der Bevölkerung verbessert und die Ernährungskompetenz gefördert werden.“

Heuer durften Lehrlinge erstmals beim EUROSPAR im Kastner-&-Öhler-Haus das Ruder übernehmen.
Bereits zum achten Mal führten SPAR-Lehrlinge im Mai eigenständig einen Supermarkt –heuer erstmals den EUROSPAR-Markt im Kastner & Öhler in der Grazer Innenstadt. Neu war heuer der intensive Austausch mit Lehrlingen des traditionsreichen Kaufhauses.
Wenn Erfahrungen und Perspektiven ausgetauscht werden, sind Synergien zu erwarten: Die SPAR-Lehrlinge holten sich Tipps zur Kundenansprache und Warenpräsentation aus der Textilbranche, während umgekehrt der K&Ö-Nachwuchs Einblicke in den Lebensmittelhandel erhielt. Das gemeinsame Fazit: Freundlichkeit und aktives Zugehen auf Kunden machen den Unterschied.
Starkes Vertrauen in die Lehrlinge Für die SPAR-Kundschaft hat es schon eine Tradition, dass die Lehrlinge das Ruder übernehmen. Von 5. bis 9. Mai kamen gleich 31 Jugendliche zusammen, um den EuroSPAR im Kastner & Öhler Haus in der Grazer Innenstadt zu managen. Die Lehrlinge haben sich intensiv vorbereitet und waren hoch motiviert, ihr Wissen in die Praxis umzusetzen. Vor acht Jahren feierte die Initiative „Lehrlinge führen einen Supermarkt“ ihre Steiermark-Premiere. Damals wie heute sind die Lehrlinge eine Woche lang für die Leitung des Standorts und für alle Tätigkeiten in den einzelnen Abteilungen verantwortlich. Das heißt konkret: Frische und Trockensortiment, Beratung der Kundschaft, Kassa, Bürotätigkeiten, aber auch Warenbestellung, Warenübernahme und Warenversorgung. Dabei setzen Lehrlinge ihr Fachwissen um und gehen auf Menschen zu. Dadurch haben die Jugendlichen die Chance, sich persönlich weiterzuentwickeln.
Neue Perspektiven entwickeln
Dass der Kontakt mit anderen Branchen neue Blickwinkel eröffnet, ist kein Geheimnis. Aus diesem Grund haben sich dieses Jahr SPAR und Kastner & Öhler zum ersten Mal in der Lehrlingsausbildung zusammengetan. „Eine Kooperation war naheliegend, auch wegen der räumlichen Nähe im selben Gebäude“, erklärt Christoph Holzer, GF von SPAR Steiermark und Südburgendland. Sowohl SPAR als auch Kastner & Öhler engagieren sich für
Lehrlingsprojekte, die weit über die Norm hinausgehen. „Es geht uns hier stark um Vertrauen. Wir tragen das Vertrauen in unsere Jugendlichen mit Freude nach außen“, betont Holzer. Er ergänzt: „Heuer hat uns auch die Zusammenarbeit mit Kastner & Öhler und das gegenseitige Kennenlernen vorangebracht. Ich freue mich über die begeisterten Reaktionen von Lehrlingen, Kunden und Ausbildner.“
Spannende Herausforderung
„Es ist sehr herausfordernd, die Verantwortung für einen Supermarkt zu tragen. Angefangen von der Personaleinteilung über Kundenanfragen bis hin zu Aktivitäten, welche wir uns vor Ort überlegt haben, wickeln diese Woche meine Lehrlingskollegen und ich hier alles ab. Die Aufgabe macht sehr viel Freude“, so Fabian Marcel Klöckl, der in dieser Woche gemeinsam die Aufgabe der Marktleitung übernommen hatte. „Unseren Kundinnen und Kunden bieten wir diese Woche auch viele Schwerpunkte: So gibt es unter anderem Käse, Schinkenspezialitäten und Obst zu verkosten“, so Klöckl weiter.
Mode und Lebensmittel lernen voneinander
Der Handel hat viele Facetten, denn unterschiedliche Branchen setzen unterschiedliche Schwerpunkte im Service am Kunden. „Es hat sich für unsere Mode-Lehrlinge zu 100 Prozent gelohnt, persönlich in den Lebensmittelhandel einzutauchen und sich das eine oder andere bei Servicequalität, Freundlichkeit und Warenpräsentation vom Eurospar mitzunehmen“, freut sich Reinhard Wittreich, GF für Personal und Expansion bei Kastner & Öhler. Work hard, party hard: Das gemeinsame Feiern von Erfolgen ist ein Zeichen von Wertschätzung. So rundete ein abschließendes „After Work“-Event mit gemeinsamen Essen, Drinks und DJ die gelungene Lehrlingskooperation ab.

Das interdisziplinäre, englischsprachige Masterstudium „Safety and Disaster Management“ an der Montanuniversität Leoben kombiniert technische, natur-, sozial- und wirtschaftswissenschaftliche Fachgebiete: Risiko-Manager und Führungskräfte von morgen werden in praxisorientierten Seminaren und Trainings darauf vorbereitet, Risiken zu erkennen, adäquat zu kommunizieren, Gefahren abzuwehren und durch soziale Kompetenzen langfristig die Resilienz von Menschen zu fördern, die psychologische Folgewirkungen davontrugen. „Besonders problematisch sind seltene, aber katastrophale Ereignisse, da hier oft die Erfahrung fehlt“, so die Studiengangsverantwortliche Renate Renner und der Studiengangsbeauftragte Harald Raupenstrauch.

Bienenforschung erhält 15.000 Euro von SPAR
Das Handelsunternehmen SPAR unterstützt die Bienenforschung an der Universität Graz mit einer Spende von 15.000 Euro. Die neu gegründete Arbeitsgruppe „Honigbiene, Umwelt und Gesellschaft“ an der Karl-Franzens-Universität Graz erhält damit Mittel für ihre Forschung zur Bienengesundheit. „Wir erforschen, welche Hinweise Bienen auf den Zustand der Umwelt geben, wie sich Umweltveränderungen auf sie auswirken und welche Maßnahmen man zu ihrem Schutz ergreifen kann“, erklärt Bienenforscher Robert Brodschneider. „Ein konkretes Projekt für 2025 ist die Entwicklung von Konzepten zu Bienenschutz und der Bedeutung von Bestäubern für das Ökosystem, die in den Schulunterricht integriert und öffentlich zugänglich gemacht werden“, so Brodschneider. Das Studienzentrum Weiz ist übersiedelt!

Steiermark präsentiert
Die Zukunft der Steiermark als moderner Bildungs-, Wirtschaftsund Innovationsstandort hängt entscheidend davon ab, wie gut es gelingt, Kinder und Jugendliche früh für Mathematik, Informatik, Naturwissenschaften und Technik zu begeistern. Eine MINT-Strategie soll helfen, der Herausforderung strukturiert zu begegnen. LR Willibald Ehrenhöfer erklärt: „Mathematik, Informatik, Naturwissenschaften und Technik sind Themen, die vielversprechende berufliche Chancen in der Steiermark bieten. Die heimische Wirtschaft benötigt gerade in technischen Berufen die Fachkräfte der Zukunft. Wir müssen unsere Kinder und Jugendlichen frühzeitig dafür begeistern und ihre Talente fördern. Die neue steirische MINT-Strategie ist ein wesentlicher Baustein dafür.“

Die Uni Graz versteht sich als Ort freier Wissenschaft, als Raum für kritisches Denken und als Plattform für gesellschaftlichen Dialog. Mit Uni Vibes, dem Fest, das Grenzen überwindet, bringt die Uni Graz diese Haltung sichtbar zum Ausdruck. So hat sich der UniCampus am 23. Mai in eine Bühne für Kunst, Wissenschaft, Musik und Tanz verwandelt: „Vielfalt wird nicht nur gezeigt, sondern mit Uni Vibes gefeiert“, so der Rektor Peter Riedler. Das Programm von Uni Vibes wurde gemeinsam mit La Strada kuratiert. Das Team rund um Intendant Werner Schrempf bringt künstlerische Formate mit Poesie, Musik, Tanz und Akrobatik auf den Campus der Uni Graz, die Grenzen zwischen Alltag, Kunst und Forschung verschwimmen lassen.
Mit Jänner 2025 hat die Studien- und Technologie Transferzentrum Weiz GmbH in der Weizer Innenstadt in der Nähe des Rathauses eine neue Heimat gefunden. Neben modernen Büroflächen stehen in dem neuen Gebäude zwei Seminarräume mit 120 und 70 Quadratmetern sowie ein Foyer, getrennt von den Büroflächen, zur Verfügung. Die neue Standort des Studienzentrum Weiz befindet sich am Hauptplatz 4, A-8160 Weiz und die neuen Telefonkontakte lauten: Festnetz: +43 / 3172 / 94 110 bzw. Fax: +43 / 3172 / 94 110 94. Auf der Webseite www.aufbaustudium.at finden Interessierte alle Kursangebote, aktuellen Termine und weitere Informationen.
FG-Obfrau Daniela Gmeinbauer (li.) und WKO-Vize-Präsin Gabi Lechner (re.) mit den Gewinnern: Ernst Grießauer (PI Pischelsdorf), Marlies Goldschmidt (PV ZAR Graz), Sonja Pichler (voestalpine Böhler Welding Austria GmbH) sowie Katrin und Mario Nerad (Vibes Fitness GmbH)

im Job“ feiert die Gewinner
Mehr als eine Viertelmillion Mitarbeiter haben von den gesunden Initiativen der heimischen Betriebe profitiert, die in den vergangenen 23 Jahren unter dem Titel „fit im job“ zu einer Erfolgsformel wurden. Die Sieger des Wettbewerbs 2025 wurden am 12. Mai in vier Kategorien mit viel Beifall zum dritten Mal in der Seifenfabrik in Graz unter anderem von Gesundheitslandesrat Karlheinz Kornhäusl gefeiert. Eben ganz nach dem Motto: Gesundheit verpflichtet.
Mehr als 800 Projekte wurden in über zwei Jahrzehnten bei „fit im job“ eingereicht. Eine Initiative, mit der Initiator Wolfgang Kasic 2002 Meilensteine gesetzt hat und die als Förderpreis für körperliche und geistige Gesundheit fix in der weißgrünen Unternehmerlandschaft verankert ist. Mit zunehmender Akzeptanz spielt doch der eklatante Facharbeitermangel „fit im job“-Betrieben ein weiteres Werkzeug in die Hand, sich als attraktive Arbeitgeber zu positionieren. Das wiederum hat auch die Liste der Kooperationspartner in den 23 Jahren von drei auf 14 wachsen lassen. Darunter allen voran Land Steiermark und WKO Steiermark, die AK, die SVS, die BVAEB, die AUVA, die Ärztekammer, Pensionsversicherung oder die ÖGK.
Wanderpass, Schauküche und Workshops
Die gesunden Projekte, ob von Newcomern oder regelmäßigen Teilnehmern, über die Jahre hinweg sind beeindruckend: Sie reichen von ausgefeilten Sportprogrammen für Mitarbeiter, dem gesunden Mittagstisch über Betriebskindergärten bis hin zu psychologischen Beratungen. Die Polizeiinspektion Pischelsdorf am Kulm, heuer Sieger in der Kategorie bis 10 Mitarbeiter, überzeugte die Jury mit Workshops und Fitnessgeräten, während die Vibes Fitness GmbH (Sieger Kategorie 2) mit Sitz
in Graz ihre Mitarbeiter mit Betriebsausflügen, inidividuell abgestimmten Arbeitszeiten oder einem offenen Zugang zu den eigenen Angeboten im Studio gewährt. „Fit im Team“ ist das Motto des Reha-Zentrums PV ZAR Graz (Sieger Kategorie 3), das auf Bewegungseinheiten am Arbeitsplatz wie auch auf geführte Meditationen und eine Schauküche setzt, um die Leistungen der Mitarbeiter anzuheben. Die voestalpine Böhler Welding Austria GmbH in Kapfenberg (Sieger Kategorie 4) hat für die 340 Mitarbeiter einen Wanderpass eingeführt, bei dem für jeden Stempel ein Euro für einen guten Zweck gespendet wird. Auch Pilates- und Yogakurse sowie reservierte Tennisplätze stehen den Mitarbeitern zur Verfügung. WKO-Vizepräsidentin Gabi Lechner zollte als Laudatorin vor allem jenen Betrieben Respekt, „die in einer Zeit die Initiative aufgegriffen haben, als Gesundheit am Arbeitsplatz noch gar kein Thema war“. Beatrice Erker (ÖGK) brachte – ebenso wie LR Karlheinz Kornhäusl – den ökonomischen Effekt auf den Punkt: „Jeder eingesetzte Euro rechnet sich mehrfach, weil gesunde Mitarbeiter einfach viel produktiver sind.“ LR Willibald Ehrenhöfer hob hervor: „Einsatzfreudige Mitarbeiter sind die Basis für den Erfolg eines jeden Unternehmens. Deren Gesundheit und Motivation wirkt sich nicht nur auf die Zufriedenheit, sondern auch auf die

Produktivität des Teams positiv aus.“ Daniela Gmeinbauer, FG-Obfrau Sport- und Freizeitbetriebe, hat auch mit der heurigen Preisverleihung bewiesen, wie wichtig es ist, Unternehmer vor den Vorhang zu holen, „weil der Applaus ein wichtiges Triebmittel für solche Initiativen ist“.
Die Award-Gewinner Award Betriebliche Gesundheitsförderung:
• 1 bis 10 Mitarbeiter: Polizeiinspektion Pischelsdorf am Kulm
• 11 bis 50 Mitarbeiter:
Vibes Fitness GmbH Graz
• 51 bis 250 Mitarbeiter: Reha-Zentrum PV ZAR Graz
• Über 250 Mitarbeiter: voestalpine Böhler Welding Austria GmbH Kapfenberg

Das Schloss Vasoldsberg in Graz-Umgebung war heuer wieder Treffpunkt für Unternehmer aus der Kfz-Technik und dem Fahrzeughandel: Fast bis auf den letzten Platz gefüllt waren die Räumlichkeiten beim „Tag der steirischen KfzWirtschaft“. Rund 300 Teilnehmer waren zum jährlich stattfindenden Branchentreff gekommen. Auf dem Programm stand neben dem Netzwerken viel fachlicher Input – von den Quotenvorgaben in der E-Mobilität über Änderungen im Bereich der „NoVA“ bis zu Vertriebsstrukturen und Nachhaltigkeit in der Schadensreparatur. Zu guter Letzt begeisterte Publikumsliebling Andreas Goldberger mit seinem Vortrag über die „Lebensschule Spitzensport“, wo er in puncto Leistung Parallelen zwischen Sport und Wirtschaft zog.



Großer Andrang bei „Female Business Convention“
Mehr als 200 Unternehmerinnen folgten der Einladung von „Frau in der Wirtschaft“ zum hochkarätigen Business- und Netzwerkevent „Female Business Convention“, das diesmal unter dem Motto „Find your inner power“ stand. Auf der Bühne referierten Speakerinnen wie Verena Böhm, Katrin Nerad und Blanka Vötsch über Resilienz, körperliche und mentale Fitness sowie Zeitmanagement. „Das immense Interesse an der Veranstaltung zeigt, wie groß das Bedürfnis ist, sich als Unternehmerin nicht nur fachlich weiterzuentwickeln, sondern auch im persönlichen Austausch Kraft zu schöpfen“, so Landesvorsitzende Gabi Lechner. Nach mehr als 20 Jahren übergab GF Elke Jantscher-Schwarz das Zepter an ihre Nachfolgerin Celina Dohr.
Bei der Hauptversammlung der BKS Bank am 15. Mai 2025 wurde eine Dividende von EUR 0,40 je Aktie beschlossen. Der thesaurierte Teil des Gewinns trägt dazu bei, die Kernkapitalquote der BKS Bank weiter zu stärken. Seit dem Börsengang im Jahr 1986 hat die BKS Bank jedes Jahr eine Dividende ausgeschüttet. Der vom Aufsichtsrat gebilligte Jahresabschluss wurde vorgelegt. „Es hat uns sehr gefreut, dass die Aktionäre so zahlreich und aktiv an der Hauptversammlung der BKS Bank teilgenommen haben. Den persönlichen Austausch, den wir mit vielen Aktionären führen konnten, schätzen wir sehr. Wir danken allen für ihre rege Teilnahme und freuen uns schon auf ein Wiedersehen im nächsten Jahr“, so Vorstandsvorsitzender Nikolaus Juhász.
Der Mediziner Markus Fritsch hat die Nachfolge von Prim. Gernot Maurer als Abteilungsvorstand für Anästhesiologie und Intensivmedizin am UKH Steiermark – Standort Kalwang angetreten und wurde nach der einjährigen Befristung im April 2025 nun zum Primarius für Anästhesie und Intensivmedizin bestellt. Der heute 42-jährige Grazer arbeitete insgesamt sieben Jahre am LKH Leoben und rotierte währenddessen ins Unfallkrankenhaus sowie auf die Universitätsklinik nach Graz. Zu seinen fachlichen Schwerpunkten zählen aktuell neben der Notfallmedizin und der anästhesiologischen Traumaversorgung die perioperative Sonographie, ultraschallgezielte Punktionen und Regionalanästhesie sowie die interventionelle Schmerzmedizin.
Auf breite Zustimmung aus der steirischen Tourismus-Branche stößt die Aufstockung der Saisonkontingente, die die Bundesregierung beschlossen hat. Johann Spreitzhofer, Obmann der Sparte Tourismus und Freizeitwirtschaft in der WKO Steiermark, sieht darin „eine Maßnahme umgesetzt, die wir schon lang mit Nachdruck gefordert haben.“ Konkret werden die Kontingente auf 5.500 Saisonarbeitsplätze aufgestockt, dazu kommt noch ein weiteres Kontingent von 2.500 Arbeitsplätzen für Arbeitskräfte aus den EU-Beitrittsländern des Westbalkan. „Eine höchst sinnvolle Maßnahme, um den hohen Fachkräftebedarf decken zu können“, so Spreitzhofer. Gerade in wirtschaftlich schwierigen Zeiten sei es wichtig, den Konjunkturmotor Tourismus gut am Laufen zu halten, ist Spreitzhofer überzeugt.

Gute Nachrichten: Die Energie Steiermark senkt ihre Strompreise mit 1. Oktober um ein Viertel. Die mehr als 260.000 Privat-Kunden mit einem Fix-Tarif erhalten in den kommenden Wochen eine entsprechende Verständigung. „Mit dieser deutlich spürbaren Reduktion reichen wir die Vorteile aus einem günstigeren Markt-Umfeld weiter und können damit einen konkreten Beitrag zur Entlastung heimischer Haushalte leisten“, so die Vorstände der Energie Steiermark, Martin Graf und Werner Ressi. Die jährliche Ersparnis für einen durchschnittlichen steirischen Haushalt mit einem Verbrauch von 3.500 Kilowattstunden wird rund 200 Euro betragen. Die Energie Steiermark gehört damit zu den günstigsten Landesenergie-Unternehmen in Österreich.

Die Golf-Saison 2025 startet mit einer großartigen Innovation: Im Rahmen eines weiß-grünen Schulterschlusses haben sich unter der Führung des Steirischen Golfverbandes 21 Anlagen zusammengeschlossen und bieten zukünftig mit der „Steiermark Golf Card“ allen Urlaubsgästen sowie den 15.000 steirischen Golfern eine gemeinsame, digitale Greenfee-Karte an. Die Initialzündung entstand in einem Gespräch mit der Tourismusabteilung. „Wir waren zu einem Treffen eingeladen und dabei kam diese Idee auf den Tisch. Da beide Seiten von diesem neuen Produkt überzeugt waren, konnten wir rasch in die Umsetzung gehen“, erklären Karl Fussi, Tourismusvorstand des Steirischen Golfverbandes, und StGVPräsident Kurt Klein.
Ausgelassene Feier mit 0 Promille
Beim „Soda Klub“ wurde im Club Circle Thalia zu Beats von DJ Mama Feelgood vollkommen nüchtern gefeiert. Die Obsession Sisters eröffneten die Tanzfläche. Über 100 Gäste erlebten einen Abend voller funkelnder Lichter, rhythmischer Beats und köstlichen alkoholfreien Drinks. Die Veranstalter, Caritas Steiermark und die Initiative „Weniger Alkohol – Mehr vom Leben“ des Gesundheitsfonds Steiermark, haben damit ein klares Zeichen gesetzt: „Sober Events sind gekommen, um zu bleiben“, so Petra Wielender vom Gesundheitsfonds Steiermark. LR Karlheinz Kornhäusl: „Veranstaltungen wie diese setzen ein wichtiges Zeichen und unterstützen die Menschen dabei, gesunde Alternativen zu entdecken und ein bewusstes, genussvolles Leben zu führen.“
Lercher kritisiert Aussagen

Mit scharfer Kritik reagiert der steirische SPÖ-Chef Max Lercher auf Aussagen des steirischen WK-Präs. Josef Herk: „Ja, die Wahrheit ist den Menschen zumutbar, aber die Wahrheit ist eine andere, als sie von LR Ehrenhöfer und dem WK-Präs. Herk gepredigt wird. Während Alt-LH Hermann Schützenhöfer noch an einer aktiven Arbeitsmarktpolitik gearbeitet hat und viele Errungenschaften der letzten Jahre bei seinem Abschied gelobt hat, bricht die ÖVP nun komplett mit ihrer Vergangenheit. Die Politik von Ehrenhöfer und die Aussagen von Herk zeigen vor allem eine Wahrheit: Nämlich, dass die Khom-ÖVP mit ihrer Vergangenheit nichts mehr zu tun haben will und auch mit verdienten Politikern wie Hermann Schützenhöfer bricht“, sagt Lercher und warnt zudem vor den geplanten Einsparungen von 500 Millionen Euro in der Steiermark.

















































Die Steiermark-Schau ist zu Gast in Mariazell: Der Steiermark-Pavillon mit Werken der Künstler Herbert Brandl, Constantin Luser, Plateau Residue, Karoline Rudolf, Antonia Jeitler und Mito Gegič wurde unweit der Basilika eröffnet. Zu sehen ist die Ausstellung unter dem Titel „Ambition & Illusion: History Repeating?“ bis Ende Juli, danach macht sie Station in Leoben. Die Verbindung von Landschaft, Geschichte und Identität steht im Mittelpunkt. Die künstlerischen Arbeiten reflektieren Natur, Kultur, Erinnerung und gesellschaftlichen Wandel. Die feierliche Eröffnung wurde von LR.in Simone Schmiedtbauer übernommen: „Kunst in die Regionen zu bringen ist enorm wichtig. Mein herzlicher Dank gilt dem Team des Universalmuseums Joanneum.«
Jetzt ist es schon wieder passiert und die Freude ist ungebrochen: Der BKS Bank wurde am 13. Mai im Wiener Palais Niederösterreich der VÖNIX-Nachhaltigkeitspreis 2025 der Wiener Börse in der Kategorie „Financials“ verliehen. Damit gewinnt sie einen der renommiertesten Finanz-Auszeichnungen des Landes zum insgesamt vierten Mal. Claudia Höller, Vorständin der BKS Bank, nahm den Preis persönlich entgegen. „Diese Auszeichnung macht uns besonders stolz, denn sie honoriert unseren Weg, der zeigt, dass Nachhaltigkeit und Finanzindustrie zusammenpassen und dass Nachhaltigkeit ein positiver Innovationstreiber sein kann. Wir sehen den Preis auch als Ansporn, weiter Verantwortung für morgen zu übernehmen“, so Höller.

2018 wurde die Arbeit des Grazer Künstlerarchitekten Clemens Luser „SlowMotion HighSpeed“ – ein Denkmal zu Ehren des Pioniers der Technik der Zeitlupe August Musger – erstmals installiert. Ein technisches Gebrechen hat es notwendig gemacht, die Büste zu ersetzen. Die neue Aluminiumbüste wurde mittels innovativem 3D-Druck-Verfahren hergestellt. Ab sofort dreht sich die Skulptur wieder am Bergmannplatz in Eisenerz. Am 1. Mai wurde das Projekt des Instituts für Kunst im öffentlichen Raum Steiermark gemeinsam mit den Verantwortlichen, darunter die Leiterin Gabriele Mackert, Künstler Clemens Luser, Bürgermeister Thomas Rauninger und Albert Wiltsche von der Technischen Universität Graz, wiedereröffnet.

SPÖ-Schwarz: Community Nurses vor dem Aus?
Das Vorzeigeprojekt „Community Nursing“ war am 20. Mai erneut Thema im Steirischen Landtag. „Wir haben bereits mehrfach davor gewarnt, dass die Community Nurses nicht weiter im Unklaren über die Zukunft gelassen werden dürfen und es dringend eine Lösung zur Finanzierung braucht. Auch heute wurde von der blau-schwarzen Landesregierung keine Lösung in Aussicht gestellt – Gesundheitslandesrat Kornhäusl schweigt neuerdings überhaupt zu diesem Thema. Für uns ist klar: Die Community Nurses leisten tagtäglich wertvolle Arbeit in der Gesundheitsversorgung und haben sich endlich Klarheit verdient. Ein so erfolgreiches Projekt darf keinesfalls eingestampft werden. Dafür werden wir mit aller Kraft eintreten“, erklärt SPÖ Klubobmann Hannes Schwarz.
Auch in diesem Jahr wird die Exkursionsreihe NOSW des Instituts für Kunst im öffentlichen Raum fortgesetzt. Die vier Ausfahrten, die in verschiedene Gegenden der Steiermark führen, widmen sich dem Ende des Zweiten Weltkriegs, das sich 2025 zum 80. Mal jährt. Unter dem Titel „Strapazierte Heimat“ führen die von Alexandra Riewe konzipierten Tagesausflüge zu Kunstwerken von Michael Schuster, Ingrid Wiener, Helmut & Johanna Kandl, Manfred Erjautz, Moya Hoke und vielen mehr. „Der Begriff ,Heimat‘, dem nachgesagt wird, dass er so nur in der deutschen Sprache existiert, stand und steht in Kunstprojekten immer wieder im Zentrum kritischer Untersuchungen“, so Alexandra Riewe-Foitl, die für das Konzept verantwortlich ist.

Der ukrainische Künstler Anton Tkachenko – seit 2023 in Graz lebend – schuf für das Foyer des Kunsthauses Graz Landschaften, in denen Berge, Brücken, Häuserzeilen, aber auch Pflanzen, Figuren und Blumen ineinander verstrickt sind: Hoffnung, Vision oder nur mehr Schatten sisyphusartig wiederkehrender Versuche der Widerständigkeit? Über dem Eingang ins historische Eiserne Haus hat der ausgebildete Architekt einen Wandbehang gefertigt. Aus Lagen von im Lager des Kunsthauses, in Caritas-Läden und andernorts gefundenen Plastikbahnen, Stoffen und Fäden schuf er ein durchscheinendes Bild, das zugleich an edle Tapisserien und an Wandfresken des frühen 20. Jahrhunderts erinnert. Zu sehen ist die Foyer-Ausstellung bis 15. Juni bei freiem Eintritt.

Presseclubabend mit Johannes Kübeck
Der langjährige Redakteur der Kleinen Zeitung und ehemalige Präsident des Steirischen Presseclubs, Johannes Kübeck, las am 8. Mai im Rahmen eines Clubabends aus seinem neuesten Buch „Kärnten und Steiermark − Neu erzählt. Mehr als zwei Jahrtausende Geschichte und Geschichten der Menschen in den Ostalpen“ und nahm das Publikum dabei mit auf einen Galopp durch die spannende Entwicklung unserer Heimat. „Das Buch spannt einen Bogen über Prozesse wie Zuwanderung und Zeitenwenden, Innovationen und Invasionen, Hunger und Hochkultur, Überfluss und Umweltzerstörung oder Klimawandel und religiöse Umbrüche“, so der Autor. Der Kreis schließt sich mit dem Blick auf die Chancen des Heute und Morgen, wofür auch die neue Eisenbahn durch die Korralm steht.

Landesrätin Claudia Holzer, Referatsleiter Öffentlicher Verkehr Bernhard Breid und Verkehrsverbund-GF Peter Gspaltl (v.l.).
„Von oben betrachten – unten erleben“ ist das Motto der neuen „BusBahnBim“-Erlebniswelt des Verkehrsverbundes Steiermark. Damit können Öffi-Nutzer ihr Verkehrsnetz in sieben Regionen interaktiv aus der „Drohnenperspektive“ erleben. Ein Highlight ist die Echtzeitauskunft für jede Haltestelle.
Verkehrsverbund-GF Peter Gspaltl freut sich über die steirische Innovation: „Die Neuerung besteht aus dem Zusammenspiel unseres bestehenden Fahrgastinformationssystems mit einer interaktiven Erlebniswelt. Der öffentliche Verkehr präsentiert sich damit in der Steiermark als innovatives Produkt.“
„Von oben sieht man den Verlauf der Strecken von Bahn und Bus sowie alle Haltestellen. Wer auf eine Haltestelle klickt, sieht in Echtzeit, wann die nächsten Züge bzw. Busse fahren, ob sie pünktlich sind oder wie viel Verspätung sie haben. Vorbesetzte Zieladressen im Routenplaner für wichtige Punkte der Regionen geben direkte Öffi-Anreisetipps. Zusätzlich können Ausflugsziele angeklickt werden, über die Informationen ausgegeben werden – immer in Kombination mit der ÖV-Anreise“, erklärt Verkehrslandesrätin Claudia Holzer.
Die BusBahnBim-Erlebniswelt ist vorerst in den Regionen Murau, Aichfeld, Eisenstraße, Schöcklland, Premstätten, Südweststeiermark und Riegersburg-Bad Gleichenberg verfügbar. Die Bewerbung in Bus und Bahn sowie die Verlinkungen bei Wirtschaftspartnern und Ausflugszielen machen auf die alle Möglichkeiten der öffentlichen Anreise aufmerksam. Bernhard Breid, Referatsleiter Öffentlicher Verkehr Land Steiermark, ist froh, „dass ein weiterer Innovationsschritt gesetzt wird, und zwar das Anbringen von QR-Codes an sämtlichen Haltestellen in den sieben Regionen, wodurch ein einfacher Zugang zur Echtzeitauskunft angeboten wird.“ Weitere Regionen wie das Mürztal oder das Ennstal zwischen Schladming und Trautenfels sind in Vorbereitung.

Bauernbund-Kampagne zum Europatag
Zum Europatag am 9. Mai startete der Steirische Bauernbund eine Kampagne, um die neue GAP, die dieses Jahr in Brüssel verhandelt wird, aktiv mitzugestalten. Wir müssen die Zukunft gestalten, denn sonst werden wir gestaltet“, sagt Bauernbundobfrau Simone Schmiedtbauer. „Wir wollen konkrete Ideen und Lösungsvorschläge auf den Tisch legen. Auf einer Webseite wollen wir Ideen sammeln, aber auch konkrete Beispiele für überbordende Bürokratie aufzeigen. Damit haben der EU-Agrarkommissar und unsere Abgeordneten dann Beispiele aus der Praxis, wo es Verbesserungen braucht“, erklärt Schmiedtbauer und ruft zur regen Beteiligung aus der Bauernschaft auf. Bis Ende Juni kann man sich unter www. stbb.at/ausmisten mit Ideen beteiligen.


Die Fachmesse Vitafoods Europe fand vom 20. bis 22. Mai erstmals in Barcelona statt und zog über 20.000 Fachbesucher aus mehr als 160 Ländern der globalen Nahrungsergänzungs- und FunctionalFood-Branche an. Mit einem starken Team von 14 Mitarbeitern präsentierte sich das Grazer Unternehmen Novalabs als innovativer Partner für Lohnherstellung und Produktentwicklung. Besonderes Highlight: der beeindruckende Messestand, eine durchgängige LED-Videowall mit innovativen Screens und Visuals, der bei den Besuchern auf reges Interesse stieß. „Wenn wir auf einer internationalen Fachmesse auftreten, dann wollen wir auch auffallen – das ist uns definitiv gelungen“, freuen sich die beiden GF David Schweiger und Christian Gubik.
Der Urlaub beginnt im Ohr
Der Sommer weckt Sehnsucht nach Erholung – nach Sonnenstrahlen, nach Meeresluft, nach Natur. Unser Gehör reist mit und nimmt mehr auf, als uns oft bewusst ist. Ob ein Song im Auto, das Zirpen der Grillen oder das leise Plätschern eines Hotelpools: Geräusche begleiten uns rund um die Uhr, sogar im Schlaf. Einen „Urlaub für die Ohren“ gibt es nicht, aber wir können ihnen gezielt Entlastung und Ruhe schenken. Der Hörakustikexperte Gerald Icha von Neuroth klärt auf: „Um auch die Hin- und Rückreise deutlich angenehmer und stressfreier zu gestalten, kann ein individuell angepasster Gehörschutz mit speziellem Filter helfen.“. Ganz nach dem Motto: Lärm aus – Entspannung an. Und so steht dem Urlaub für die Ohren nichts mehr im Wege.

Fünf Jahre voller Geschmack, Kreativität und besonderer Momente: Gefeiert wurde dieser kulinarische Meilenstein des Arravané am Merkur Campus in Graz am 22. Mai mit einem exklusiven Dinner. Das fünfgängige Menü wurde von ausgesuchten Weinen des Weinguts Gross begleitet. Unter den Gästen waren Partner und Wegbegleiter der ersten Stunde sowie Gäste des Hauses. Der Abend stand im Zeichen des Genusses und der Wertschätzung – für die Zusammenarbeit und die gemeinsamen Erlebnisse, die das Arravané in diesen fünf Jahren geprägt haben. Küchenchef Thomas Galler bedankte sich bei seinem Team und allen Anwesenden: „Ohne euch wäre das Arravané nicht das, was es heute ist – ein Ort, an dem Kulinarik und Begegnung aufeinandertreffen.“
Die neue Binnenmarktstrategie der EU macht Mut – wenn ihr Taten folgen. Denn von der Vollendung des europäischen Binnenmarktes ist in Sonntagsreden zwar oft die Rede. In der Realität aber blieb das Versprechen bisher jedoch ein Torso – mit jeder Menge Stolpersteinen im Gepäck.
Die Europäische Kommission hat nun eine neue Binnenmarktstrategie vorgelegt, die viele dieser Hemmnisse klar benennt. Für die Industrie ist das ein richtiger und wichtiger Schritt – aber eben nur der Anfang. „Die EU-Kommission hat zentrale Stellschrauben adressiert, um das Potenzial des Binnenmarkts besser auszuschöpfen“, sagt IV-Generalsekretär Christoph Neumayer. Der Knackpunkt sei die konkrete Ausgestaltung und möglichst rasche Umsetzung der Maßnahmen.
Denn noch immer behindern nicht-tarifäre Handelshemmnisse den freien Austausch. Laut IV wirken sie im Warenverkehr mit rund 44 Prozent wie versteckte Zölle, bei Dienstleistungen sogar mit über 100 Prozent. Für exportorientierte Unternehmen bedeutet das hohe unnötige Kosten und verpasste Wachstumschancen.
So gibt es in der EU gibt es 27 unterschiedliche nationale Meldeverfahren im Bereich der Arbeitnehmerentsendung – alle in Landessprache, alle mit eigenen Formalismen. Dass sich die Kom-
mission nun auf eine einheitliche, digitale Entsendemeldung („EDeclaration“) zubewegt, ist begrüßenswert. Außerdem will die EU die „Small Mid Caps“, also mittelgroßer Unternehmen mit bis zu 750 Mitarbeitern entlasten. Diese sollen künftig wie klassische KMU behandelt werden und damit weniger komplexen Vorschriften unterliegen.
Doch so solide das Fundament dieser Strategie auch sein mag –ohne politisches Commitment der Mitgliedsstaaten wird daraus kein tragfähiges Haus, ist man bei der IV überzeugt. „Seit Jahrzehnten ist klar, wo die Schwachstellen im Binnenmarkt liegen“, so Neumayer. „Es braucht endlich einen echten Aufbruch – nicht weitere Jahre des Zögerns.“
Gerade in Zeiten geopolitischer Unsicherheiten, disruptiver Technologien und wachsender Standortkonkurrenz könnte ein starker, funktionierender Binnenmarkt Europas vielleicht wichtigster wirtschaftlicher Stabilitätsanker sein. Die Kommission hat nun vorgelegt. Jetzt liegt der Ball bei den Mitgliedsstaaten.



Die Energie Graz setzt ein starkes Zeichen für Elektromobilität und kooperiert mit der Lebensmittelkette Hofer: An fünf stark frequentierten Grazer Filialen wurden moderne Schnell-Ladestationen errichtet. Doch das ist erst der Anfang: Im Zuge des gemeinsamen Ausbaus mit Hofer plant die Energie Graz bis 2026sieben weitere Standorte. Kunden können ihr E-Auto dort ab sofort bequem während des Einkaufs aufladen – zeitsparend und effizient. Die Partnerschaft mit Hofer ermöglicht es uns, Ladelösungen genau dort anzubieten, wo sie im Alltag gebraucht werden. Laden während des Einkaufs steigert den Komfort und macht den Umstieg auf Elektromobilität noch attraktiver“, so die Energie Graz-GF Josef Landschützer und Boris Papousek.
Graz wurde zur Bühne des ESC
Während Österreich über den ESC-Sieg 2025 in Basel jubelt, ging in Graz bereits das nächste Großevent über die Bühne: die European Sales Competition, Europas größter Verkaufswettbewerb für Studierende. Gastgeberin war die GH Campus 02, die damit einmal mehr ihre Rolle als internationale Ausbildungsplattform bewies. Rund 65 Studierende aus zwölf Ländern traten in Verkaufsgesprächen gegeneinander an. Kommunikationsstärke und Überzeugungskraft waren gefragt. „Ein Event auf höchstem Niveau“, betont Ursula Haas-Kotzegger von der FH. Auch Unternehmen wie Team Viewer und Gartner nutzten die Gelegenheit, Top-Talente kennenzulernen. Den Sieg holte sich Sandra Loburg von der Uni Gießen – mit Kompetenz, Charme und klarer Linie.

Jugend am Werk wirkt vielfältig
Jugend am Werk Steiermark widmet sich bereits zum zweiten Mal dem Thema Vielfalt – heuer mit einer ganzen Diversity Week statt nur eines Tages. Unter anderem wurde eine bunte Modenschau am Mariahilferplatz veranstaltet. „Diversität ist fest in der Unternehmenskultur von Jugend am Werk verankert“, so GF Sandra Schimmler. „Wir sehen die Individualität unserer Kunden und Mitarbeiter als Bereicherung und Stärke. Deshalb setzen wir uns aktiv mit dieser Vielfalt auseinander und fördern sie. Dazu gehören eine eigene interne Diversity-Strategie und ein Diversity-Leitbild. Werte wie Wertschätzung, Respekt und Toleranz prägen unser tägliches Handeln – mit der Aktionswoche wollen wir dieses Bewusstsein weiter stärken.“
Das Kunsthaus Graz lobt Umweltkunstpreis aus Im Jahr 2025 freut sich das Kunsthaus, im Rahmen des Festivals „Markt der Zukunft“ den Umweltpreis der Stadt Graz nicht nur zu erweitern, sondern auch eine künstlerische Ausschreibung ins Leben zu rufen. Der Preis soll eine künstlerische Arbeit unterstützen, die sich mit ökologischer Nachhaltigkeit auseinandersetzt. Getragen wird diese Initiative von der Überzeugung, dass Kunst das Bewusstsein schärfen und in Umweltfragen Veränderungen bewirken kann. Der Zusatzpreis richtet sich an Künstler, die sich mit den Themen Nachhaltigkeit und Umweltschutz befassen. Wie bei den allgemeinen Preisen steht heuer das Thema Ernährung im Fokus. Einreichung des Portfolios und/oder eines max. 2-seitigen PDF mit einem Werk- oder Projektkonzept bis 7. Juni 2025 an office@kunsthausgraz.at mit dem Vermerk: Umweltkunstpreis Kunsthaus Graz.
Die EU-Kommission will territoriale Lieferbeschränkungen verbieten – ein System, das Österreichs Händler bisher stark benachteiligt und die Konsumenten teuer zu stehen kommt. Der Handelsverband sieht ein Einsparpotenzial von 14 Milliarden Euro jährlich und spricht von einem Meilenstein für den Binnenmarkt.
Ein Haarspray kostet in Deutschland 2 Euro, in Österreich 3,20. Dasselbe Produkt, derselbe Hersteller – aber ein anderer Markt. Dieses Beispiel steht sinnbildlich für ein langjähriges Ärgernis im europäischen Binnenmarkt: territoriale Lieferbeschränkungen. Multinationale Konzerne diktieren länderspezifische Vertriebswege, Händler in Österreich dürfen viele Markenprodukte nicht dort einkaufen, wo sie am günstigsten sind, sondern müssen nationale Vertriebsgesellschaften akzeptieren –inklusive saftiger Preisaufschläge. Die EU-Kommission will damit nun Schluss machen.
Im Rahmen ihrer neuen Binnenmarktstrategie kündigte sie ein umfassendes Verbot sogenannter Territorial Supply Constraints (TSCs) an – ein Schritt, den der österreichische Handelsverband seit Jahren fordert. Für Rainer Will, Geschäftsführer des Handelsverbands, ist die Entscheidung ein längst überfälliger „Befreiungsschlag“: „Was der Binnenmarkt verspricht, muss er auch halten. Künstliche Barrieren wie territoriale Lieferbeschränkungen widersprechen seiner Grundidee – sie gehören abgeschafft.“
Milliardenpotenzial für die Volkswirtschaft
Die EU beziffert das Einsparungspotenzial durch ein Verbot der TSCs auf bis zu 14 Milliarden Euro jährlich – Geld, das derzeit in
überhöhten Verbraucherpreisen und übermäßigen Margen internationaler Hersteller verschwindet. Besonders betroffen sind Güter des täglichen Bedarfs wie Lebensmittel, Kosmetik oder Reinigungsmittel. Die Preisdifferenzen zwischen einzelnen Ländern betragen dabei nicht selten bis zu 60 Prozent – eine strukturelle Ungleichheit im europäischen Handel, unter der insbesondere kleinere Märkte wie Österreich leiden.
Laut Handelsverband führt dieses System nicht nur zu Wettbewerbsverzerrungen im B2B-Geschäft, sondern schadet letztlich auch den Endverbrauchern. „Der sogenannte ‚Österreich-Preisaufschlag‘ ist ein reines Körberlgeld für multinationale Konzerne. Unsere Händler zahlen drauf – und geben das notgedrungen an die Kunden weiter“, kritisiert Will.
Jetzt zählt die Umsetzung
Damit aus dem politischen Signal auch konkrete wirtschaftliche Realität wird, fordert der Handelsverband eine rasche und konsequente Umsetzung – auf europäischer Ebene ebenso wie in der nationalen Gesetzgebung. „Die Abschaffung territorialer Lieferbeschränkungen darf kein Lippenbekenntnis bleiben“, mahnt Will. Österreich müsse bei der Umsetzung vorangehen – im Interesse der Konsumenten und der Handelsunternehmen im Land.
Die EU macht endlich Schluss mit territorialen Lieferbeschränkungen durch die Konzerne und kommt damit dem Ziel eines echten Binnenmarktes ein Stück näher.



Anlässlich des Podcasts «Special Monkeys» besuchte der Geschäftsführer von Licht ins Dunkel Mario Thaler die Special People Inclusion Association in der Humboldtstraße in Graz. Im Zentrum des Podcasts stand das Thema Inklusion. Mario Thaler erzählt dabei viele persönliche Erlebnisse und wie er die Spendensituation in Österreich sieht. Auch zur immer wiederkehrenden ORF-Kritik nimmt der gebürtige Tiroler Stellung. Den 30-minütigen Podcast findet man auf Apple Podcast, Spotify und Sound Cloud unter «Special Monkeys» oder einfach auf der Website www.spia.org.
Schwarz fordert wohnortnahe Versorgung

Die Universität Graz startet als erste Hochschule Österreichs den KI-Chatbot „studiGPT“ zur Studienunterstützung. Dieser ist für alle Studierenden kostenlos verfügbar und unterstützt beim Entwurf eines Lernplans, bei der Verbesserung von Texten, Formulierung von E-Mails bis zu kreativer Ideenfindung. Man kann auch Dateien hochladen und Prompts für die weitere Verwendung abspeichern. Beim Info-Event stellte das Team vom Idea Lab die Inhalte des Micro-Degree „KI und Gesellschaft“ vor, von den theoretischen Grundlagen bis zur praktischen Umsetzung in einer Gruppe, die auf die Arbeitsweise in einem Unternehmen vorbereitet. Die transdisziplinäre Zusatzausbildung mit 16 ECTS-Punkten steht allen Bachelor- und Diplomstudierenden offen.
Anlässlich der Aussagen von Vorstand Gerhard Stark zum 40-jährigen Jubiläum der KAGes ruft SPÖ-Klubobmann Hannes Schwarz in Erinnerung, dass eine wohnortnahe Gesundheitsversorgung oberste Priorität haben muss. „Die Steirerinnen und Steirer finanzieren mit ihren hohen Beiträgen das Gesundheitssystem, daher haben sie auch ein Recht darauf, dass es funktioniert“, sagt Schwarz: „Wenn Gerhard Stark die Maßnahmen in Bruck lobt, dann übersieht er die Sorgen von 100.000 Menschen im Bezirk, die mit einem Schlag ihre notfallmedizinische Versorgung verloren haben. Viele von ihnen haben nicht ohne Grund eine Petition für den Erhalt unterschrieben, denn bei Unfällen zählt jede Sekunde. Deshalb ist es für uns essenziell, dass eine Notfallversorgung an allen steirischen Standorten sichergestellt sein muss.“

Steirischer Bautag in Seggau
Im südsteirischen Schloss Seggau ging am 22. Mai der Steirische Bautag über die Bühne. Dabei wurden bereits zum dritten Mal aktuelle Daten aus der „BauEnquete“ der Landesinnung Bau präsentiert. Dabei werden die Bevölkerung und die Bauunternehmen unter anderem zu Trends im Haus- und Wohnbau befragt. Aus den Umfragedaten hat die Landesinnung Bau das Projekt „Wohnbau – radikal neu gedacht“ und einen klaren Auftrag abgeleitet: „Wir wollen das Bauen wieder einfacher und günstiger machen und somit leistbaren Wohnraum in der Steiermark zur Verfügung stellen“, so Bau-LIM Michael Stvarnik. Das Projekt ist ein Forschungsprojekt der Landesinnung Bau in Zusammenarbeit mit der FH Joanneum und der ZAB – Zukunftsagentur Bau.

Finger weg vom Trinkgeld!
Was Kunden freiwillig als Trinkgeld geben, soll sowohl für die Betriebe als auch für die Mitarbeiter steuer- und abgabenfrei sein. Dafür setzt sich die neu gewählte Führungsspitze der Sparte Tourismus und Freizeitwirtschaft in der WKO Steiermark ein. „Unsere Betriebe wurden in den vergangenen Monaten mit zum Teil horrenden Nachzahlungen der ÖGK konfrontiert. Hier braucht es eine Lösung und Rechtssicherheit“, fordert Spartenobmann Johann Spreitzhofer gemeinsam mit Hotellerie-Obmann Alfred Grabner und Gastro-Obmann Klaus Friedl sowie seiner Stellvertreterin Michaela Muster. Unterstützt werden sie dabei von WKO-SteiermarkPräsident Josef Herk: „Trinkgeld als direkter Dank des Gastes gilt dem Service, nicht dem Staatshaushalt“, so Herk.

Bei der Jahresversammlung der Raiffeisen-Landesbank Steiermark am 23. Mai betonten AR-Vorsitzender Josef Hainzl und GenDir. Martin Schaller die Rolle von Raiffeisen als starker Partner für Wirtschaft und Gesellschaft: „Raiffeisen ist ein stabiler Anker in herausfordernden Zeiten. Unsere Stärke liegt in der regionalen Verankerung, der engen Kundennähe und dem starken Zusammenhalt innerhalb der Raiffeisen-Bankengruppe.“ „ Trotz herausfordernder Rahmenbedingungen ermöglichte die Bankengruppe 2024 neue Finanzierungen in Höhe von 2,6 Mrd. Euro und erzielte ein Betriebsergebnis von 595 Mio. Euro. In sieben strategischen Handlungsfeldern – von Nachhaltigkeit über Innovation bis IT – treibt die RLB ihre Weiterentwicklung gezielt voran. Sichtbare Initiativen sind u. a. das Bildungsprojekt Bank2School (mit 2600 Schülern und Schülerinnen), 3,6 Mio. Euro im Sozialbereich sowie der Start-up-Accelerator Hummelnest. Raiffeisen positioniert sich damit als verantwortungsvoller Arbeitgeber, Investor und Innovationstreiber in der Steiermark.
Was tun mit nicht mehr verwendeten Werbeplanen von Bauzäunen? SPAR hat daraus mit „Jugend am Werk“ stabile LonglifeTaschen nähen lassen. Die Planentaschen sind in neun ausgewählten EUROSPAR-Filialen erhältlich, solange der Vorrat reicht.
Aus Alt mach Neu: In der „Jugend am Werk“-Werkstätte in der Grazer Kärntnerstraße war eine besondere Upcycling-Aktion im Gang. Denn SPAR lieferte dutzende nicht mehr verwendete Bauzäune mit Werbebotschaften an, damit daraus in Handarbeit hochwertige Taschen hergestellt werden. Das Ergebnis kann sich sehen lassen: Aus den alten Planen sind rund 300 auffällige Longlife-Taschen in bunten Farben entstanden.
In Handarbeit entstehen bei Jugend am Werk aus alten SPARBauzaunplanen farbenfrohe Longlife-Taschen.

Kooperation mit sozialem Mehrwert
Die Jugend am Werk Steiermark GmbH zählt zu den führenden Anbietern sozialer Dienstleistungen in der Steiermark und arbeitet seit fünf Jahren mit SPAR zusammen. Direkt in der SPAR-Zentrale Graz sind etwa sechs Klienten und Klientinnen von „Jugend am Werk“ damit beschäftigt, Schritt für Schritt Sekt, Schokolade & Co. in ansprechende Geschenke zu konfektionieren. Diese Geschenke werden an die Märkte geliefert, um der SPAR-Kundschaft Mitbringsel für alle Anlässe bereitzustellen. Mittlerweile arbeitet man neben der Zweigstelle Graz auch mit „Jugend am Werk“ in Liezen, Kapfenberg und Knittelfeld zusammen.
Re-Use in Spitzenqualität
Bei der Planen-Taschen-Produktion war eins für SPAR klar: „Wir kennen unseren Partner ‚Jugend am Werk‘ und wissen, dass hier auf jeder Ebene professionell und verlässlich gearbeitet wird. Daher haben wir mit Freude auf das Know-how dieser Integrationseinrichtung zurückgegriffen“, macht GF von SPAR Steiermark und Südburgenland Christoph Holzer deutlich. „Die Idee der Wiederverwertung von Bauzaunplanen zu Taschen ist genial: Es sind lauter Unikate entstanden. Dank der Umsetzung durch Jugend am Werk stehen sie für gelebte Inklusion.“

Nach 25 Jahren Funktionärstätigkeit für die WKO Steiermark, davon 20 Jahre als Obmann der Fachgruppe der Immobilienund Vermögenstreuhänder, hat Gerald Gollenz am 24. April 2025 seine Funktion an jüngere Hände übergeben.
Zum neuen Obmann der Fachgruppe wurde der Sprecher der steirischen Bauträger, Andreas Kern, gewählt, der sich der Wahl gestellt hat, wofür ihm Gollenz herzlich dankte. „Es ist nicht selbstverständlich, dass sich ein sehr erfolgreicher Unternehmer in den Dienst der Branche stellt, die gerade in den letzten Monaten turbulente Zeiten erlebt hat und leider auch noch immer durchlebt“, so Gollenz.
Gerüstet für herausfordernde Zukunft
In diesem Sinne soll der Bauträger und Immobiliensach-
verständige Andreas Kern auch in Zukunft weiterhin wirken, denn er kenne die Problemfelder schon berufsbedingt aus seiner umfangreichen Erfahrung. „Von Hürden im Bauverfahren über Planungsunsicherheit bis hin zu überbordenden rechtlichen Grundlagen – ich erlebe täglich selbst, wo es hakt, und weiß auch, was es brauchen würde: weniger Bürokratie, viel mehr Zusammenarbeit und gute Lösungen! Im Berufsalltag wie in der Interessenvertretung!“, erklärte Kern, in dem Gollenz den bestens geeigneten Nachfolger für diese
Funktion sieht. Die Zukunft der Branche bleibt herausfordernd, aber mit Andreas Kern als Nachfolger sei die Kontinuität gewährleistet. Der neue Fachgruppen-Obmann dankte Gerald Gollenz für seinen jahrzehntelangen Einsatz und wünschte ihm alles Gute für die nächste Phase. Denn seine Funktion als Obmann des Fachverbandes der WKO Österreich wird Gollenz aller Voraussicht auch nach Beendigung der laufenden Periode fortführen, spätestens im Laufe des Jahres 2026 diese aber an einen Nachfolger übergeben.

Sie suchen einen professionellen Partner für die Verwertung Ihrer Liegenschaft. Wir bieten Ihnen umfassende Unterstützung: von der sorgfältigen Bewertung über die Erarbeitung und Umsetzung eines Verkaufskonzeptes bis zur problemlosen Abwicklung des Kaufvertrages. Ich berate Sie gerne und freue mich auf Ihren Anruf!
Michael Pontasch-Hörzer, 0316/8036-2599 oder 0664/5345495. www.raiffeisen-immobilien.at

Ihr Immobilienverkauf in verlässlicher Hand! Gerade jetzt umso wichtiger: Fundierte und umfassende Beratung, langjährige Marktkenntnis und Erfahrung. Persönlicher Einsatz, breite Werbewirksamkeit und gewissenhafte Unterstützung bis zur problemlosen Kaufvertragsabwicklung sind Ihnen sicher. Unsere Kunden sind für Sie Barzahler! In einem persönlichen Gespräch berate ich Sie unverbindlich und freue mich auf Ihren Anruf!
Sabine Heißenberger, 0664/85 50 199, sabine.heissenberger@rlbstmk.at www.raiffeisen-immobilien.at
Am 19. Mai 2025 startet die dringend umfassende Sanierung der Münzgrabenstraße sowie der angrenzenden Fröhlichgasse. Die Bauarbeiten, die bis September 2025 andauern, beinhalten nicht nur eine Fahrbahnerneuerung, sondern auch die Modernisierung bzw. Erneuerung der unterirdischen Leitungen, die Umgestaltung der Beleuchtung sowie Anpassungen im Straßenraum. Wegen gesetzlicher Regelungen ist der Umbau der Schräg- zu Längsparkplätzen in der Münzgrabenstraße nötig, dadurch entfallen 36 Stellplätze. Neue Fahrrad-Mehrzweckstreifen entstehen in beide Richtungen zwischen Moserhofgasse und Fröhlichgasse. Weiters erfolgt eine Verlängerung der Abbiegespuren in der Fröhlichgasse und Neuordnung der Bushaltestellen sowie ein Lückenschluss im Radwegenetz zwischen Klosterwiesgasse und Messe.

GRAZ-WALTENDORF:
Exklusives Grundstück mit Altbestand und Schöcklblick –Ruhe pur! Gstgr. ca. 2.526 m², sanierungsbedüfrtiges Haus mit ca. 114 m² Ntzfl., Kaufpreis: 895.000,- Euro, www.remax.at/1606/16385
Mag. (FH) Elke Raich, +43 664/42 41 767, e.raich@remax-for-all.at


8073 Feldkirchen bei Graz: Familienfreundliche 3-Zimmerwohnung in Grünruhelage
73,83 m² Nutzfläche, BJ 2007, im 2. und letzten Stock, gutes Raumkonzept, Süd-Ausrichtung, ca. 9 m² großer SüdBalkon, Carport zum KP von 15.000,- Euro, HWB: 61,4 kWh/m2a, KP: 174.000,- Euro, Renate Müller, M +43 664 8184132, renate.mueller@sreal.at, www.sreal.at


GRAZ-ANDRITZ:
Vielfalt pur: Ein Haus für jede Lebensphase - grenzenlose Möglichkeiten auf über 300 m²
Gstgr. ca. 1.390 m², Wfl. ca. 298 m², 6,5 Zi., 2 Balkone, 1 Terrasse, Garage,HWB: 130,8 kWH/ m2a, Klasse D, Kaufpreis: 899.500,- Euro, Objektnummer: 1606/16394
Mag. (FH) Elke Raich, +43 664/42 41 767, e.raich@remax-for-all.at


8401 KALSDORF bei Graz: Moderne 3-Zimmerwohnung mit großem Balkon 67,05 m² Nutzfläche, Erdgeschoss, sehr gutes Raumkonzept, große südseitige Terrasse mit ca. 22,10 m², hochwertige Einbauküche inkl. aller E-Geräte, Fernwärme, Fußbodenheizung, Tiefgaragen-Stellplatz zum Kaufpreis von 17.000,- Euro, Kellerabteil, HWB: 22 kWh/m2a., fGEE 0,71, KP: 181.000,- Euro, Renate Müller, M +43 664 8184132, renate.mueller@sreal.at, www.sreal.at


8020 Graz-Eggenberg: Nähe FH Joanneum u. Schloss Eggenberg / Gepflegte 2-Zimmer-Wohnung in Grünruhelage 59,24 m² Nutzfläche, ideales Anlegerobjekt, sehr gutes Raumkonzept, Zimmer getrennt begehbar, Kellerabteil, Parkplätze vorhanden (grüne Zone). HWB: 47,2 kWh/m2a, fGEE 0,92. KP: 159.000,- Euro, Renate Müller, M +43 664 8184132, renate.mueller@sreal.at, www.sreal.at


8010 Graz-Waltendorf: Elitäre Lage Ruckerlberg/Kleines aber feines Grundstück mit Stadtblick und Objektbestand aus Jahrhundertwende 211 m² Nutzfläche, 421 m² Grundstücksfläche, Baugrund ist voll erschlossen, Widmung WR 0,2 bis 0,6, Keller, Gas-Zentralheizung; HWB: 95 kWh/m2a, KP: 749.000,- Euro, Renate Müller, M +43 664 8184132, renate.mueller@sreal.at, www.sreal.at
Von




Als er 1997 in die USA auswanderte, um den dortigen Markt mit seinem selbstgemachten Speiseeis zu missionieren, hat er sich die Sache ziemlich einfach vorgestellt.
Mehrfach stand Karl »Charly« Temmel finanziell auf der Kippe, bevor es der hierzulande »Eiskönig« Genannte geschafft hat. Anders als geplant, aber hochprofessionell, unternehmerisch schlau, zugleich mitarbeiterfreundlich und mutig. Und mit ein bisschen Arnie.
Aurelia kam in der Regel zweimal die Woche nach Graz. Einkaufen, Besorgungen machen, vielleicht hat sie auch Besuche gemacht, wer weiß das heute noch? Doch eines ist gewiss – sie ging jedesmal ins Kaffeehaus, in den Kaiserhof. Das Lokal war in der Neunzigerjahren zwar nicht mehr ganz so wie früher, der neue Pächter hatte umgebaut, aber er war ihr sympathisch. Immer gut aufgelegt und freundlich, so wie auch seine Frau Maria, mit der er ein kleinen Sohn hatte. Kurz, man war sich grün und so nahm Aurelia eines Tages auch ihren Sohn ins Kaffeehaus mit. Das war nicht ganz so einfach, der war schon groß, ziemlich groß sogar und auffällig muskulös und außerdem Filmstar. Aber Aurelia Schwarzenegger hatte recht, Arnold verstand sich auf Anhieb mit Herrn Karl, dem Chef im Kaiserhof. Der Rest ist Geschichte. Arnold wurde noch berühmter, sogar Politiker in Kalifornien, wo er auch eine gute Figur machte, dann hat er dort etwas unterschrieben, weshalb sein Name vom Liebenauer Stadion, das inzwischen nach ihm benannt worden war, wieder entfernt wurde, dafür hat er den Ehrenring der Stadt Graz wieder zurückgegeben und man war wieder irgendwie quitt, das ist aber eine andere Geschichte. Der damalige Pächter vom Kaiserhof und anschließend noch vom Operncafé, Karl »Charly« Temmel, ging auch nach Amerika und machte dort ebenfalls sein Glück, sodass er heute sagen kann, er würde alles wieder so machen. Wenn jemand das von sich sagen kann und den Verdacht vermittelt, es auch ehrlich zu meinen, dann lohnt es eine Spurensuche.
Nach Amerika »Sagen, was man denkt. Und vorher was gedacht haben.« Nur sehr treue Fazitportraitleser und natürlich seine Fans kennen dieses Zitat von Harry Rowohlt, jenes großen Sprach- und Redekünstlers, der »nun völlig sinnloserweise« (FAZ) schon ziemlich

Ein Freund hat mich dazu überredet.
Charly Temmel, Eiskönig
genau sieben »Jahre tot ist, weil er nur siebzig wurde«, und dessen Bühnenauftritte sich deshalb regelmäßig über mehrere Stunden erstreckten, weil er vom Hundertsten ins Tausendste zu kommen pflegte. Solcherart zum »Paganini der Abschweifung« geadelt, wurde er auch zur Inspirationsquelle der »Fazitabschweifung«, in der wir uns gerade so unvermittelt befinden. Die aber gar nicht so abwegig ist, wie es scheint. Als Charly Temmel in den Neunzigern das erste Mal »nach Amerika« flog, tat er das unwillig: »Ein Freund hat mich dazu überredet.« Man landete an der Westküste, in Los Angeles, und Charly war vom »American Lifestyle«, von der Stadt, von den Universalstudios und Disneyland dermaßen beeindruckt, dass er sagte, was er dachte: »Ich gehe nach Amerika.« Das war, wie er heute offen sagt, vorher keineswegs durchdacht, doch der Plan war klar. Schließlich war er zu Hause bereits der »Eiskönig«: Temmel-Eis war sprichwörtlich in aller Munde und sein Unternehmen auf Expansionskurs. Warum sollte das in Amerika nicht gehen? Ihm war zwar aufgefallen, dass es in L. A. keine Eisdielen gab so wie in Europa, aber aus sportlicher Sicht erschien ihm das als spannende Herausforderung.
Mit Sport hatte er ab 1990 tatsächlich einiges zu tun, denn vor der Ära Kartnig ab 1992 war Charly Temmel Präsident von Sturm Graz: »Mit Gustl Starek damals als Trainer sind wir immerhin Dritter in der Meisterschaft geworden.« Als Geschäftsmann konnte er sich außerdem über zahlreichen Besuch von Fußballern im Kaiserhof freuen, im Übrigen nicht nur von Sturmspielern.
Die Anfänge
Begonnen hat alles in St. Andrä im Sausal. Dort besaßen seine Eltern ein Gasthaus, das auch als Wohnhaus diente, gleich gegenüber der Kirche. Der heute 66-jährige hatte im Grazer Gambrinuskeller den Kochberuf erlernt, es folgten einige Stationen als Koch in Serfaus, Velden, Lech und auf Korsika und dann wollte er möglichst bald das elterliche Gasthaus übernehmen. Allein – die Eltern spielten nicht mit. »Also habe ich 1981 in Feldkirchen südlich von Graz das Gasthaus »Zum Löwen« übernommen.« Auf der Suche nach Personal gaben ihm seine Eltern den entscheidenden Tip: »Die beste, die wir bei uns jemals hatten, war die Maria, schau, dass Du sie findest.« Das tat er auch und es ist ihm heute noch anzumerken, wie glücklich er darüber ist. Maria war gerade in der Wildschönau in Tirol »auf Saison« und froh in die Steiermark heimkehren zu können, denn sie stammt ebenfalls aus der Südsteiermark, aus Otternitz bei Sankt Martin im Sulmtal. Charly hatte sie zwar bereits aus St. Andrä gekannt, aber eher flüchtig. »Die Gäste im Gasthaus in Feldkirchen haben aber von Anfang an gedacht, das ist meine
Freundin oder Frau, weil sie so nett war.« Jetzt kennen sie sich schon 40 Jahre und sind seit 36 Jahren verheiratet. »Ohne sie hätte ich das alles nicht geschafft. Das ist zu 80 Prozent ihr Verdienst«, schwärmt Charly noch heute – der grundsätzlich mit allen per Du ist, weshalb hier oft nur sein Vorname steht. Nach sechs Jahren bot sich für den erfolgreichen, energiegeladenen Gastwirt die Möglichkeit, die Café-Konditorei Rauninger auf Leibrente zu kaufen. Das ist jenes Haus in der Mitterstraße in Puntigam, das heute noch Zentrale und Stammsitz von Temmel-Eis ist. Und Charly legte einen Superstart hin. »Das war für mich der Einstieg in die große Welt«, sagt er mit einer ansteckender Begeisterungsfähigkeit. »Ich habe fast alle Gäste, die gekommen sind, gekannt. Die sind von Feldkirchen raufgekommen, das ist ja in unmittelbarer Nähe.« Der Schritt vom Gasthaus zum Kaffehaus kam ihm auch gelegen, denn sein großes Vorbild damals war die Konditorei Philipp in der Krenngasse, die zugleich ein Eissalon ist. Und übrigens vor exakt acht Jahren bereits Gegenstand dieser Fazitportraitreihe war. Die Mehlspeisen kaufte er damals in der Konditorei Sekirnjak zu, aber mit dem Eis hatte er schon damals große Pläne: »Meine Vorgängerin, die Frau Rauninger, hat noch sechs Eissorten gehabt. Ich habe dann Eismaschinen gekauft, die Außenwand aufgeschnitten und eine große Vitrine mit 24 Eissorten installiert.« Als gelernter Konditor übernahm Charly die Rezeptur des Speiseeises und das ist ihm so gut gelungen, dass die Kundschaft förmlich angepilgert kam. Heute gibt es in Graz zwar ungleich mehr Mitbewerber als vor 36 Jahren, doch als wir uns kürzlich für dieses Interview in der Temmel-Eis-Filiale in der Herrengasse getroffen haben, mussten wir uns selbst anstellen, um ein Eis zu bekommen.
Prominenz als Magnet Charly Temmel ist ein umtriebiger Mensch, so war er zwischendurch etwa auch Stadtparteiobmann-Stellvertreter der ÖVP und Wirtschaftskammerfunktionär. Wie war das jetzt wirklich mit »Amerika«? »Sie haben dort nicht auf mich gewartet«, sagt Charly. Die Eiskultur in den USA ist nicht mangelhaft, sondern schlicht nicht vorhanden. Das hätte er sich nicht gedacht, als er 1997 mit Kind und Kegel nach L.A. ging. Sohn Swen war bereits sechs Jahre alt und ging in die erste Klasse Volksschule. Cineasten wissen, dass der inzwischen 31-jährige, zweisprachig Erzogene Schauspieler geworden ist und mit so bekannten Hollywoodgrößen wie Robert De Niro, Bruce Willis oder John Travolta Filme dreht. Aber auch das ist eine eigene Geschichte. Der erfolgsverwöhnte »Eiskönig« eröffnete einen Eissalon in Santa Monica, das zum Großraum L. A. gehört, aber die Gäste blieben aus. »Zum Glück hatte ich einige


Das war für mich der Einstieg in die große Welt.
Charly Temmel, Eiskönig
Mieten schon im Vorhinein bezahlt, sonst hätte ich nicht durchgehalten«, sagt er heute. Innerhalb von zwei Monaten baute er den Eissalon in ein Speiselokal um, und die Sache begann zu laufen. Ja, und da war noch sein Freund aus Graz, der Arnie Schwarzenegger. Der hatte nicht weit entfernt sein Promi-Speiselokal »Schatzi On Main«, Sie wissen schon, mit Apfelstrudel nach Muttis Rezept, Wienersnitzel und so weiter. Charly fragt Arnie einfach, ob er das Lokal nicht pachten könnte und Arnie sagte ja. »Ich habe gewusst, das kann ich noch besser machen«, stellt Charly sein Licht nicht unter den Scheffel. Gesagt, getan. Und der Laden brummte. Das ganze Haus gehörte Schwarzenegger und nachdem er dort auch sein Büro hatte, war er oft dort und das war für die Gäste Grund genug in Massen zu kommen – ein Blick auf Arnie war im Bereich des Wahrscheinlichen. Außerdem wohnte Pierce Brosnan auch in dem Haus und Stammgäste wie Charles Bronson und viele ander Prominente wirkten wie Magnete. Charly hatte inzwischen verstanden, das die Amerikaner lieber Icecream aus dem Supermarkt, abgepackt in kleine Kübel, kaufen. Er schaltete wieder schnell, erwarb von einem Franzosen in Santa Clarita, ebenfalls im Raum L. A., eine Fabrik für Eissorbet, kaufte die für die Eisherstellung notwendigen Anlagen in Italien und produzierte fürderhin Eis für Supermärkte und Tankstellen. »Aber der Vertrieb hat mich zweimal fast umgebracht«, resümiert er. Der Aufwand, Eis über weite Strecken zu transportieren, ist gelinde gesagt gewaltig. »Zum Beispiel eine wirklich große Bestellung für Tankstellen in Florida. Das liegt auf der anderen Seite des Kontinents, zigtausend Kilometer entfernt. Und zurück muss der Kühlwagen ja auch wieder fahren.« Die Kosten waren explodiert. Dann kam plötzlich ein italienisches Ehepaar mit der Anfrage, ob er für sie Eis abfüllen könnte. Das tat er natürlich gerne, denn das Vertriebsproblem war damit bei den Italienern.
Temmel Konditorei Café GmbH
8055 Graz, Mitterstraße 1 Telefon +43 316 295802 temmel.com
Dieses Fazitportrait erschien erstmals im August 2022.
Gelato statt Icecream
Und sieh an: Die verkauften das Eis nunmehr als »Gelato« und das wurde ein Renner. »Der Amerikaner meint, das ist etwas anderes.« Geschäftsmann, wie Charly einer ist, verkaufte er an die Italiener, sicherte sich aber von Anfang an eine Beteiligung. Mittlerweile gibt es eine zweite Fabrik in Phoenix/Arizona und der Laden brummt. Abgefüllt wird für andere, nicht mehr als Temmel-Eis, sondern als »homemade« beziehungsweise unter anderen Namen. Und »Schatzi On Main«? Als Arnie Gouverneur in Sacramento wurde, versiegte auch der Gästestrom, Schwarzenegger verkaufte das ganze Gebäude und Charly die Rechte am Lokal. Mit den Mitarbeitern vom »Schatzi« betrieb er noch für fünf Jahre ein Lokal in Malibu, das »Plate«, aber auch das ist bereits Geschichte. Es ist eine Erfolgsgeschichte, der Gastwirtesohn hat viele Investitionen getätigt, auch in Immobilien, sein Eisimperium hierzulande umfasst 18 Geschäfte in der Steiermark und er beliefert mehr als 70 Lokale auch in anderen Bundesländern. An drei Standorten wird sein Eis produziert, auch in der Herrengasse, wo sich gleich ums Eck auch das »Eislager« befindet. Hier wird das Gefrorene noch einmal auf Minus 20 gekühlt – der Vertrieb, Sie wissen schon. Charly ist jeweils nur für zwei Sommermonate in Graz und setzt seine Familie als Statthalter ein. Cousin Wolfgang ist Geschäftsführer in der Herrengasse, dessen Bruder in Puntigam und Charlys Bruder Willi führt das Café Lewandofsky in Bad Aussee, wohin jeden Tag die mittlerweile in Puntigam selbst hergestellten Kuchen und Torten angeliefert werden. Vertrieb, schon wieder. Aber es gibt mittlerweile rund 100 Mitarbeiter, die für ordnungsgemäße Abläufe sorgen. Ob es ein Erfolgsgeheimnis gibt? »Ich habe mich getraut, selbständig zu werden. Und ich habe die richtige Frau und auch Glück gehabt. Und ich habe die Worte meines Vaters beherzigt: Der Einheimische ist der wichtigste Gast.« n

Song Contest

Aufgabe der Politik soll sein, dem Menschen zu einem gelungenen Leben zu verhelfen.
Kurt Jungwirth, 1929–2025, österreichischer Kulturpolitiker
Mit seinem ESC-Sieg wurde JJ über Nacht zum Star – doch nun steht der Wiener Musiker international in der Kritik.

Von Andreas Pankarter
Seine Forderung, Israel vom nächsten Eurovision Song Contest auszuschließen, stößt nicht nur zur Unzeit, sondern offenbart eine gefährliche Schlagseite. Der als queerer Hoffnungsträger gefeierte Künstler überschreitet eine rote Linie – und befeuert ein Narrativ, das Antisemitismus als moralischen Aktivismus tarnt. Der frischgebackene ESC-Sieger JJ, bürgerlich Johannes Pietsch, hat mit seinen jüngsten Aussagen für internationale Debatten gesorgt – und dabei selbst eine gefährliche Grenzüberschreitung vollzogen. In einem Interview mit der spanischen Zeitung El País forderte der 24-jährige Wiener, dass Israel im kommenden Jahr vom Eurovision Song Contest ausgeschlossen wird: »Ich würde mir wünschen, dass der ESC nächstes Jahr in Wien stattfindet – ohne Israel.«
Vergleich mit Rußland
Diese Forderung kommt nicht nur zur Unzeit, sondern ist in ihrer Stoßrichtung auch klar antisemitisch einzuordnen. Pietsch stellt Israels Verteidigungsoffensive im Gazastreifen auf eine moralische Stufe mit Russlands völkerrechtswidrigem Überfall auf die Ukraine – eine Gleichsetzung, die historische und geopolitische Realitäten grob verzerrt. Denn während Russland einen souveränen Staat überfiel, begann Israels Militäroperation als Reaktion auf das beispiellose Massaker der Hamas am 7. Oktober 2023 – bei dem unter anderem die israelische ESC-Kandidatin Yuval Raphael nur knapp überlebte.
Verschwörungstheorien beim Publikumsvoting Raphael, sie entkam dem Terror auf dem Nova-Musikfestival, trat in Basel mit dem Song »New Day Will Rise« an – ein Lied,
Johannes Pietsch alias »JJ« in einer Mangainterpretation durch künstliche Intelligenz
das Hoffnung und Resilienz in dunklen Zeiten verkörpert. Dass ihre Performance ausgerechnet vom Publikum mit der Höchstwertung bedacht wurde (297 Televoting-Punkte) und Israel sich so vom 15. auf den 2. Platz katapultierte, sorgt nun für Irritationen bei ESC-Teilnehmerstaaten wie Spanien und Belgien. Man fordert eine Überprüfung des Votings –unterstellt werden organisierte Mobilisierungen. Der Sieger JJ nennt das Ergebnis »seltsam«, der spanische Rundfunk gar »kulturgefährdend«.
Progressive Neomoral Pietsch beruft sich in seiner Argumentation auf den Ausschluss Russlands 2022 und ignoriert damit zentrale Unterschiede. Nicht zuletzt, dass Israel ein demokratischer Staat ist, dessen Bevölkerung sich seit Jahrzehnten gegen Raketenangriffe, Terror und Delegitimierung zur Wehr setzen muss. Der ESC, eigentlich ein kultureller Brückenbauer, droht durch politische Kampagnen und Boykottforderungen in eine Schieflage zu geraten, in der Antisemitismus nicht nur geduldet, sondern in progressive Moral verpackt wird.
Antisemitische Narrative Beunruhigend ist auch die mediale Resonanz. JJ, der sich als Stimme der Vielfalt versteht und für LGBTQ+-Rechte eintritt, erfährt breiten Zuspruch, obwohl seine Aussagen Israel faktisch das Existenzrecht im Rahmen der europäischen Wertegemeinschaft absprechen. Die Enttäuschung darüber, dass ausgerechnet ein queerer Künstler den Ausschluss des einzigen jüdischen Staates fordert, ist tief. Und sie ist berechtigt. Die Europäische Rundfunkunion (EBU) kündigte an, die Umstände des Wettbewerbs evaluieren zu wollen. Es ist zu hoffen, dass sie dabei nicht nur technische Details, sondern auch ideologische Tendenzen ernst nimmt. Denn der Ausschluss Israels vom ESC wäre kein Zeichen von Gerechtigkeit, sondern ein fatales Zugeständnis an eine Normalisierung antisemitischer Narrative im Gewand kultureller Kritik. n
Vassili Christopoulos, Chefdirigent der Grazer Oper, gibt einen Einblick in die Geheimnisse der italienischen Oper

Von Marlene Tischler
Am 6. Juni ladet die italienische Bibliothek »Arca« zu einem besonderen Abend über die italienische Oper. Über ihre sozio-historische und vor allem ihre musikalische Bedeutung. Der Chefdirigent der Grazer Philharmoniker, Vassili Christopoulos, wird dem Publikum die Rolle des Dirigenten in der italienischen Oper vom Belcanto bis zum Verismo erläutern und dabei die Figur von Giuseppe Verdi und die Neuerungen seiner Opern, insbesondere »Rigoletto«, hervorheben. Es werden auch einige musikalische Ausschnitte zu hören sein. Seit vielen Jahren organisiert »Arca« in Zusammenarbeit mit dem Verein »Dante Alighieri Graz« Veranstaltungen zu verschiedenen Themen rund um die italienische Kultur.
»Arca« ist eine italienische Buchhandlung und Bibliothek in der Grazer Brandhofgasse 9, die seit 2012 die italienische Sprache, Literatur und Kultur fördert. Neben dem Verkauf von Büchern in italienischer und deutscher Sprache von italienischen Autoren gibt es auch Bücher über Geschichte und aktuelle Ereignisse und Persönlichkeiten. n
Die italienische Oper Vom Bellcanto über Giuseppe Verdi bis zum Verismus: die Rolle des Dirigenten
6. Juni 2025, 19 Uhr Aula Roma in der Grazer Elisabethstrasse 12/II bit.ly/ArcaGraz
Von lebender Farbe, spekulativer Ästhetik und der kleinen Revolution an der Wand.
Von Andreas Pankarter
Es beginnt, wie so oft bei epochalen Erfindungen, mit einem beinahe skurrilen Bild. Hauswände, die atmen, denken, sich selbst heilen – und ganz nebenbei auch noch den Kohlendioxidfußabdruck polieren. Was klingt wie ein dadaistischer Tagtraum der Grünen Jugend, ist in Wahrheit ein ernsthaft gefördertes Projekt der Europäischen Union. »Remedy« nennt es sich, also eigentlich »Heilmittel«. Aber hier als ein Art Akronym, das an pharmazeutische Beipackzettel erinnert, tatsächlich aber die erste zarte Berührung zwischen Architektur, Biologie und Poesie markiert. Denn was da rund um die Grazer Strömungsphysikerin Carole Planchette, die slowenische Bioästhetin Anna Sandak und einer Schar eigensinniger Mikrobiologen entsteht, hat Potenzial zur leisen Sensation. Mikroorganismen – nicht jene, die im Kühlschrank auf dem Joghurtdeckel gären, sondern gezielt komponierte Algen und Pilze – sollen künftig unsere Fassaden besiedeln. Als Gestaltung, als Schutzschild, als ökologische Intervention. Lebende Tinte wird per Inkjetdruck auf Wände appliziert,
gewissermassen zu Wandtattoos, die zugleich Schadstoffe filtern, Kohlendioxid speichern oder auch Risse kitten. Ein wenig wie ein Biotop, ein wenig wie Klimapolitik und auch ein bisschen Street Art. Aber ohne Spraydose.
Mehr als Science-Fiction »Das ist mehr als nur Science-Fiction«, sagt Planchette, während sie an einer Tinte tüftelt, die zugleich lebendig und druckbar bleibt. Die Herausforderung dabei, Mikroben sind dickköpfige Zeitgenossen. Zu groß für klassische Nanodüsen, zu sensibel für bloße industrielle Routine. Aber vielleicht liegt auch genau darin ihr Zauber. Unberechenbar, formverliebt, eigenwillig. Was man gemeinhin »Zufallskunst« nennt. Die Vision ist eine neue Ästhetik. Keine Fassaden mehr, die glätten, was Geschichte gezeichnet hat, sondern Gebäude, die in Symbiose mit der Umwelt stehen. Persönlich, wandelbar, atmend. So könnte eine neue Architektursprache entstehen, eben irgendwo zwischen Bauhaus und Biotop. Remedy ist kein Medikament gegen den Klimawandel. Aber vielleicht ein poetischer Anfang. n
















Allmonatliche Finalbetrachtungen von Johannes Tandl

Seit den Flüchtlingswellen ab 2015 hat Österreich über 250.000 Asylanträge verzeichnet. Damit einher ging ein spürbarer negativer Effekt auf die Sozialsysteme und besonders auf das Gesundheitssystem. Asylwerber haben natürlich Anspruch auf medizinische Grundversorgung, die über öffentliche Mittel finanziert wird – ebenso auf notwendige Behandlungen im Akutfall oder bei chronischen Erkrankungen. Auch nach der Asylanerkennung bleibt die finanzielle Belastung zunächst bestehen, denn viele anerkannte Flüchtlinge sind in den ersten Jahren weder voll in den Arbeitsmarkt integriert noch in der Lage, kostendeckende Beiträge zur Krankenversicherung zu leisten. Besonders gefordert sind Spitalsambulanzen in urbanen Gebieten. Gleichzeitig sind Gesundheitsleistungen ein wesentlicher Baustein der Integration – sie stärken individuelle Stabilität und gesellschaftliche Teilhabe. Langfristig hängt der Integrationserfolg davon ab, wie gut Bildung, Arbeitsmarkt und Gesundheitsvorsorge zusammenspielen. Ganz Europa
Zuwanderung
braucht ein Ziel. Nicht Naivität
muss sich der unbequemen Wahrheit stellen, dass Migration ein dauerhaftes Strukturmerkmal moderner, freier Demokratien geworden ist. Und auch, dass nicht jede Migration ein Gewinn für die Gesellschaft ist. Während qualifizierte Arbeitsmigration angesichts der demografischen Krise dringend notwendig ist, gefährdet unkontrollierte Armuts- und Bildungsmigration langfristig die Stabilität unserer Sozial- und Bildungssysteme. Der oft zitierte Satz von Max Frisch – »Wir riefen Arbeitskräfte, und es kamen Menschen« – klingt empathisch, verschleiert aber ein zentrales Problem: Menschen, die ohne ausreichende Qualifikation und ohne Bereitschaft zur Integration kommen, belasten jene Systeme, auf die sie angewiesen sind, anstatt sie zu stärken. Einwanderung in prekären sozialen Lagen erzeugt nicht nur Bildungsungleichheit, sondern verstetigt sie. Und das, obwohl Bildung als Schlüssel zur Integration gilt. Die Realität ist ernüchternd: Kinder aus migrantischen Familien schneiden europaweit in Kernkompetenzen wie Lesen, Mathematik und Naturwissenschaften wesentlich schlechter ab als einheimische Kinder – unabhängig vom sozialen Status. Es gibt also eine migrationsspezifische Bildungsbenachteiligung, die sich durch fehlende Sprachkompetenz, mangelnde frühkindliche Förderung und geringe Bildungsaspirationen im Elternhaus erklärt. Wer die Sprache des Landes nicht spricht und aus bildungsfernen Milieus kommt, wird auch durch das beste Schulsystem der Welt nicht zum »High Performer« – eigentlich eine unglaubliche Vergeudung von Talenten, die durch die Überlastung der Systeme hervorgerufen ist. Noch gravierender ist: Die strukturelle Überforderung führt dazu, dass sich soziale Spannungen und Integrationsdefizite in jenen Stadtteilen bündeln, in denen Bildungsbenachteiligung und Wohnsegregation zusammenfallen. Das Ergebnis: sogenannte »Brennpunktschulen«, die nicht per se schlecht wären, wären dort nicht ausgerechnet auch noch die unerfahrensten Lehrkräfte konzentriert. Durch die frühe Bildungsselektion erhöhen sich zweifellos die Chancen derjenigen, die es auf an-
spruchsvollere Schulen wie die Gymnasien schaffen. Gleichzeitig werden Zehnjährige mit Sprachdefiziten – also Migrantenkinder – in weniger anspruchsvolle Bildungswege gedrängt. Auch so verschwenden wir Potenziale. Ambitionierte Kinder aus Einwandererfamilien scheitern nicht nur an ihrem eigenen Umfeld, sondern nicht selten an institutionellen Hürden und impliziten Vorurteilen.
Das größte Problem der Migration ist die große Zahl derjenigen, die irgendwie zu uns gekommen sind, ohne die Voraussetzungen für die Schaffung der eigenen Lebensgrundlagen jemals erreichen zu können. Es muss endlich wieder außer Streit gestellt werden, dass der Zuzug in die Sozialsysteme kein Menschenrecht ist; und auch, dass Integration keine Einbahnstraße ist, sondern aus Geben und Nehmen besteht. Migration muss daher Sprachkompetenz voraussetzen und sich auf jene beschränken, die Bildungsbereitschaft und Arbeitsfähigkeit mitbringen.
Ohne diese Klarheit droht aus dem humanistischen Versprechen der Chancengleichheit eine kostspielige Illusion zu werden – mit jenen fatalen Folgen für Wirtschaft, Bildung, Gesundheit und gesellschaftlichen Zusammenhalt, die sich seit Jahren bei uns abzeichnen. n
Sie erreichen den Autor unter johannes.tandl@wmedia.at


Schenken gedacht.
Gute Arbeit verdient mehr. Belohnen Sie Ihr Team mit GrazGutscheinen – steuerfrei und individuell gestaltbar.
holding-graz.at/grazgutschein
